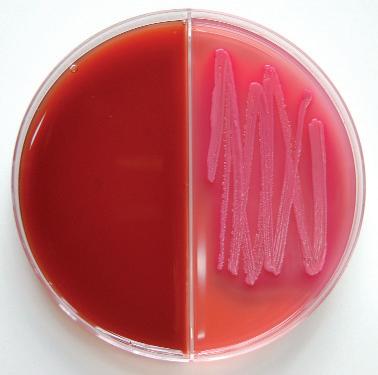
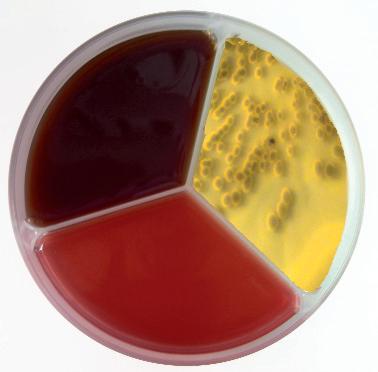

Tercera página.........................................................................3

Agenda.....................................................................................4
Empresas...................................................................................6
REPORTAJES
•8ª Escuela de Preparadores..............................................10
•XIV Concurso de ganado frisón de Irún..........................18
•19º Concurso de Valle de Carriedo y 39º Concurso de Llanera............................................................................19
•Jueces españoles por el mundo: Feira Agrícola de Açores y 30º Concurso Nacional de Hungría.................20
•Finca de Mouriscade.........................................................22
OPINIÓN
•Directora del I.E.S. de Luces y Directora General de Ganadería de Asturias.................................................28
CONAFE
•Vacas Medalla de Oro y Vacas Estrella..........................34
•Resumen de la Memoria CONAFE 2012..........................38
GENÉTICA
•Mejores Rebaños por ICO.................................................50
•Diez mejores hembras genotipadas................................54
•Pruebas CONAFE-MACE junio/agosto’13........................56
ESCUELA DE JUECES SOBRE PAPEL
•Resultados sección 57ª......................................................66
•Sección 58ª..........................................................................67
CALIFICACIÓN
•Reunión semestral de los técnicos calificadores............68
•Animales calificados EX y MB durante los meses de mayo y junio de 2013.........................................................70
CONTROL LECHERO
•Resultados del Control Lechero 2012...............................78
INFORMES
•Resumen del Control Lechero en Cataluña 2012..........82
ANEMBE RESPONDE
•Control de Neospora en explotaciones ganaderas. S. Rojo y L.M. Ortega..........................................................86
JURÍDICO
•Las cláusulas suelo. L. Peña...............................................90
TEMARIO
•Las micotoxinas, también un problema en la leche. M. Martín Richard ...............................................................92
•La causa de las cojeras no era la alimentación, era el flemón interdigital. J.V. González .................................96
•El cultivo de muestras de leche en granja como herramienta en el control de mastitis. N. Roger y L.M. Jiménez ......................................................................100
•Los resultados económicos 2012 de las explotaciones de vacas de leche en Catalunya. A. Seguí y otros.....104
•El confort del ganado lechero en épocas de calor. Manejo del estrés térmico. A. Callejo.................106
y además...
• Reglamento del 34º Concurso Nacional CONAFE’13 ..118
•Legislación.........................................................................125
•Índice de anunciantes.....................................................125
•Guía Comercial................................................................126
En el editorial del número de mayo/junio se apuntaba que la drástica reducción de las ayudas al Control Lechero, fruto de los recortes presupuestarios, estaba poniendo el peligro la existencia, ya precaria, de algunas asociaciones. Ahora añadimos que no es solo la disminución de ayudas, sino el retraso en el pago de las subvenciones de ejercicios anteriores lo que está apretando el cuello de explotaciones y organizaciones ganaderas. Los afectados estamos esperando una posible solución de estos problemas –con poca esperanza, por cierto–, tratando de no incomodar a unas administraciones que lo que tienen que hacer es pagar lo debido.
Y como al perro flaco todo se le hacen pulgas, la Comisión Europea reclama 180 millones de euros correspondientes a la PAC gastados indebidamente por 15 Estados miembros, entre ellos, España, cuyos agricultores tendrán que retornar al Estado 6,7 millones. Cómo el sector agropecuario va a hacer frente a deudas, impagos, multas y devoluciones, intriga e intimida a partes iguales. No será, desde luego, con los beneficios obtenidos por la venta de la leche, aunque afortunadamente hay alguna buena noticia al respecto, como la subida del importe medio percibido por los ganaderos gallegos que, después de varias campañas en las que apenas cubrían gastos, se ha situado en 33,06 céntimos de media, sin IVA.
En realidad, esta subida del precio, que se ha producido en todo el Estado, se debe a la confluencia de varios factores, entre ellos, la bajada de la producción en algunos países como Francia –nuestro mayor importador (¿inundador?) y cuyos precios sirven de referencia a este lado de los Pirineos– donde se ha reducido un 6%, y España, donde la producción ha caído un 2,5%. Otro factor que propicia la subida del precio es el aumento del consumo en países como India y China.
Precisamente, la revista Nature ha publicado un mapa que muestra la tolerancia a la lactosa de la población mundial: solo el 35% de la humanidad puede beber leche después de los 7 u 8 años de edad sin tener problemas de estómago y es en China y el sudeste asiático donde se encuentra mayor número de “lacto intolerantes”. Es otra buena noticia, por tanto, que pese a esa intolerancia, el consumo aumente en estos territorios.
Algún medio también apunta a que este alza puede ser consecuencia del convenio suscrito por la gran distribución y la industria, bajo la tutela del Ministerio de Agricultura, por el que la primera se comprometía a ir eliminando paulatinamente la leche como producto reclamo. Si es así, resulta alentador ver que algo se mueve en el sector.
Por nuestra parte, añadimos a estas pocas buenas nuevas la certeza de que el sector productor cuenta con una cantera entregada al mundo de los concursos –y por extensión, al de la ganadería– como ha quedado demostrado una vez más en la Escuela de Preparadores, celebrada los primeros días de julio y cuyo reportaje publicamos en las siguientes páginas. También hemos visitado la Finca Mouriscade, donde nos han mostrado sus actividades y proyectos, destacando lo que ya es una realidad: la puesta en funcionamiento de la planta de biogás.
A punto de comenzar el nuevo curso, CONAFE se centra en impulsar las herramientas asociadas a la selección genómica y en continuar trabajando en programas como el de Salud Podal, que ha cumplido ya su primer año de andadura. Igualmente, la Confederación seguirá trabajando en el desarrollo de futuros programas, como el estudio de la eficiencia energética de los alimentos, que será de gran utilidad considerando el precio de las raciones.
Con independencia de estos programas y proyectos, “el centro de atención”, como indica el cartel del 34º Concurso Nacional, se situará en la pista del Recinto Ferial de Asturias, donde las mejores vacas de nuestro país competirán para demostrar el gran trabajo de selección y manejo hecho por sus criadores y propietarios. Este año, además, con la nueva sección de vacas en producción de más de 50.000 kg, confirmarán que la buena morfología y la buena producción están estrechamente ligadas. Os invitamos a comprobarlo en Gijón el 28 y 29 de septiembre.

Edita:
Confederación de Asociaciones de Frisona Española
Presidente:
Germán de la Vega Delgado, AFCA.
Vicepresidente:
José Emilio García Suárez, ASCOLAF.
Secretario:
Jaime Olascoaga Enseñat, AFB.
Tesorero:
José Antonio Hernández Martín, FEFRICALE.
Interventor:
José Carlos Vega Rodríguez, FEFRIGA.
Vocales:
Antonio Casas García, AFA.
Carlos Prat Castillejo, AFNA.
Carlos Manuel Sánchez García, AFRIARA.
Alejandro Arasanz Balongo, AFRICAMA.
Miguel González de Parla, AFRIDEMA.
Valentín Novales Elejalde, EFRIFE.
Agustí Prat Aguilar. FEFRIC.
Sofia Alday Martínez de Cestafe, Directora Gerente.

Redacción, Publicidad y Suscripciones
Revista Frisona Española - CONAFE
Apdo. de Correos 31 - 28340 Valdemoro (Madrid)
Ctra. de Andalucía Km. 23,600
Tlfs: 91 895 24 12/62/68
Fax: 91 895 14 71
PUBLICACION BIMESTRAL AÑO XXXIII NUM. 196
Julio/Agosto 2013
Directora:
Pilar López Caño
Subdirector:
Baldomero Fernández Fernández
Publicidad y revistafrisona.com: Departamento propio
Suscripciones:
Charo García Tovar
Impresión: Litofinter, S.A. ISBN. 9211-3767
Depósito Legal: M-5.568-1981
CONAFE no se responsabiliza del contenido de los artículos, anuncios y otros escritos firmados, así como tampoco, necesariamente, comparte los criterios de sus autores. Se permite la reproducción total o parcial de los artículos, informaciones y fotografías de esta revista citando el origen.
Correo Electrónico: publicidad@revistafrisona.com suscripciones@revistafrisona.com conafe@conafe.com
Páginas Web: www.revistafrisona.com www.conafe.com
D.
Domiciliado en . . .
C.P. . . .
Profesión . . . . .
Se suscribe a la revista FRISONA ESPAÑOLA por un período de un año (enero a diciembre). El importe de la suscripción lo abona mediante el sistema señalado más abajo. (No se considerará efectiva la suscripción que no venga acompañada del justificante de pago elegido).
Precio Suscripción 2013
•España . . . . . . . . . .48 Euros (IVA incluido)
•Europa . . . . . . . . . . .77 Euros (IVA incluido)
•Resto Mundo . . . . .90 Euros (IVA includio)
Indique (✗) el sistema de pago elegido:
❏ Enviado giro postal núm.............
❏ Transferencia Bancaria Nº Cuenta: 2100 1903 41 0200038804
❏ Talón nominativo a favor de CONAFE
❏ Domiciliación Bancaria:
(Entidad)(Oficina)(D.C.)(Número de Cuenta)
de 2013
La Confederación de Asociaciones de Frisona Española, CONAFE, informa que todos los datos personales recabados serán incluidos en una base de datos, cuya única finalidad es la gestión de suscriptores de la Revista Frisona Española. Dicha base de datos se encuentra incluida en el Registro de la Agencia de Protección de Datos.
CONAFE ha adoptado los niveles de protección de los Datos Personales legalmente requeridos y ha instalado todos los medios técnicos a su alcance para evitar la pérdida, mal uso, alteración, acceso no autorizado y robo de los Datos Personales facilitados. Siempre que lo desee podrá ejercer su derecho al acceso, rectificación, cancelación y oposición dirigiéndose a la siguiente dirección:
CONAFE, Apdo. 31. 28340 Valdemoro (Madrid).
Algunos ejemplos de los animales que se venden:

Novilla de consurso!

BADIOLA SID KENDA
Se vende la actual Novilla Gran Campeona de Asturias, esta preciosa novilla está imbatida en la pista durante el 2013, ha sido Gran Campeona en el Regional de Asturias y en Llanera, viene de la familia de Kournikova y Koketa
Genómica Top de la familia de Goldwyn

DKR ZENDRA MB-86-ES 86-SM 2a
Se vende una GoldChip de DKR Zendra, de la familia Gypsy Grand. Manolero Gold Chip 1dn Wind-ET 3027 GICO / 125 RCS (Nº1) / GICU +3.13 (Nº5) / GIGT +2.60 (Nº12).


MANTONO BRAXTON FROSIA
La UNICA ternera española con potencial para ser la 17ª generación MB o EX, una tremenda ternera de concurso. De la familia Canadiense Karona Attraction Robin
La Hermana completa de Monalisa!

PLANILLO GOLDWYN MONEGRA
La hermana completa de Planillo Shottle Monalisa, Novilla Gran Campeona Nacional 2012. Shottle x Planillo Goldwyn Monegra MB-86 2a. x Planillo Sept Sara EX-93-ES

SCIENTIFIC DEBUTANTE RAE EX-92-USA
Una Colt P con Factor Rojo & Polled nieta de Scientific Debutante Rae EX-92-USA que fue Gran Campeona Reserva en Madison’05. De la familia de las Roxy EX-97-USA.

Una Mayfield nieta de MS Atlees Goldwyn Ariel EX-92-USA, la siguiente madre es la MD-Delight Durham Atlee EX-92-USA.

MORSAN FOOLS GOLD RED MB-87-CAN 2a
Exclusiva EPIC Roja de la Morsan MOM Fools Gold Red, buena ternera con buen pedigrí y potencial de concurso.

REGANCREST-PR BARBIE EX-92-USA
Buenas terneras de la familia Barbie. Una Dempsey con +14 a tipo en Canadá y una Domain Hermana materna de Mars Yorick (Ascol)
 MD-DELIGHT DURHAM ATLEE EX-92-USA
DKR PRONTO FAITH MB-87-DE 2a Bonita Atwood de la familia de la Ralma Juror Faith! La madre es una Pronto de una Goldwyn que se vendió en la Subasta NH’10 en 40000€
MD-DELIGHT DURHAM ATLEE EX-92-USA
DKR PRONTO FAITH MB-87-DE 2a Bonita Atwood de la familia de la Ralma Juror Faith! La madre es una Pronto de una Goldwyn que se vendió en la Subasta NH’10 en 40000€

Sábado,
Durante el 34º Concurso Nacional de CONAFE
Hora: 19:00
Live Stream & puja a través de Live Dairy Auction
WWW.SPANISHMASTERSSALE.COM
Subasta de 15 animales de elite y algún lote de embriones, de los mejores criadores nacionales e internacionales. Se venden magníficos animales de Mantoño Holstein, Ganaderia Badiola, Planillo Holsteins, La Benera, Ganadería Flora, Diamond Genetics, JK Eder Holsteins, Drakkar Holsteins entre otros. Esperamos verte el 28 de Septiembre, en el recinto ferial Luis Adaro.
Para más información o para pedir el catálogo, visite la página web o contacte con la organización a través de: Pablo Reboiro Fernández: Tel.+34 627812012- Email: pablo@eurogenes.com
Arjan van der Vlis: Tel.+31 (0)6 43985150 -Email: arjan@eurogenes.nl
Jan de Vries: Tel.+31 (0)6 26250502 -Email: jandevries@diamond-genetics.nl

Una Hermana materna de Ciderman (Nº1 GICO, @Ascol) Cancellara (Nº6 GICO, @ Xenética Fontao) y de Control (@ Semex), una buena rama de la Glenridge Citation Roxy

Una Atwood de una Pronto de la familia de Comestar Laurie Sheik, familia que ha producido toros como Lautamic, Starleader, Lauthority, Outside, Stormatic entre otros.


 GIESSEN CINDERELLA 20 MB-87-NL 2a
CHARPENTIER OMAN MADAM MB-CAN
BADIOLA GOLDWYN MEGATE MB-88-ES 2a
Su madre, Badiola Shottle Megadonna MB88 2a. es la actual Vaca Joven Campeona de Asturias. Su abuela Badiola Goldwyn Megate I, fue Vaca Gran Campeona en GandAgro 2012.
GIESSEN CINDERELLA 20 MB-87-NL 2a
CHARPENTIER OMAN MADAM MB-CAN
BADIOLA GOLDWYN MEGATE MB-88-ES 2a
Su madre, Badiola Shottle Megadonna MB88 2a. es la actual Vaca Joven Campeona de Asturias. Su abuela Badiola Goldwyn Megate I, fue Vaca Gran Campeona en GandAgro 2012.

El danés Niel Eric Haahr es propietario de la ganadería lechera Anderstrup Holsteins, con 300 vacas y una media de producción a 365 días por encina de los 14.600 kg de leche.
La familia Haarh ha desarrollo un programa intensivo de selección con el que obtienen anualmente más de 200 terneras procedentes de transferencia de embriones. El programa también produce numerosos toros para centro de inseminación en Dinamarca y Alemania.
En Anderstrup Holsteins también son muy aficionados a los certámenes ganaderos y han ganado alrededor de 25 premios en el Concurso Nacional Danés.


Niels Eric Haahr comenzó a juzgar concursos a los 16 años, siendo en la actualidad un reputado experto que ha juzgado en su país numerosos concursos regionales así como el Concurso nacional, que ha juzgado en cuatro ocasiones y que juzgará de nuevo en la edición de 2013.
En el Concurso Europeo celebrado en Suiza en marzo de 2013, Haahr fue el juez de las secciones individuales de Holstein Rojo y del Campeonato Europeo de Jóvenes Ganaderos.
Curso de “Producción lechera de alto rendimiento”
El Galilee International Management Institute (GIMI) –institución israelí dedicada a la capacitación internacional en gerencia–organiza del 13 al 27 de noviembre en Israel un curso sobre “Producción lechera de alto rendimiento”, cuyo programa se beneficia del liderazgo que Israel posee en esta materia.
La producción de leche en Israel se caracteriza por sus modernos sistemas de producción y altos rendimientos. Un intenso programa de mejora genética, junto a la aplicación de nuevas tecnologías para el manejo de la alimentación, sanidad y control del estrés calórico han logrado obtener una raza de alto potencial productivo capaz de adaptarse a las difíciles condiciones climáticas del país, alcanzando una producción anual de leche considerada entre las más altas a nivel mundial.
El programa se desarrolla íntegramente en español y consiste en una capacitación intensiva, que combina clases teóricas, talleres y visitas de campo, en los que se podrá profundizar y obtener información de primera mano sobre los avances tecnológicos utilizados y desarrollados en Israel, en estos últimos años en materia de Producción Lechera.
El GIMI cuenta con más de veinticinco años de experiencia en el diseño y aplicación de programas de Gestión, Liderazgo y Seminarios de Capacitación, dirigidos a profesionales y directivos de diferentes áreas provenientes de más de 170 países del mundo.
Para más información, contactar con Eva Bermejo, Directora de Programas, Centro de Capacitación en Agricultura y Medio Ambiente AETC. Ebermejo@galilcol.ac.il - tlf. 972 4 642 8801

Los días 14 y 15 de noviembre, el auditorio de la Facultad de Veterinaria de Lugo (USC) acogerá una nueva edición, la décimo primera, de las Jornadas Técnicas de Vacuno de Leche de SERAGRO, que este año girarán en torno al correcto manejo del rebaño.
La importancia del periodo seco para prevenir la aparición de problemas vinculados a la salud de la ubre y la comparación de dos granjas de producción láctea con realidades distintas pero con el mismo objetivo de conseguir un negocio rentable son algunos de los temas más destacados del programa.
El manejo de la alimentación y los problemas podales también tendrán cabida en las exposiciones de varios ponentes. Además, y como ya viene siendo habitual, el segundo día tendrá lugar una mesa redonda donde se tratarán temas de actualidad y de interés para el sector.
En este momento, los organizadores están ultimando el cartel de técnicos especialistas que intervendrán en las jornadas, manteniendo la aspiración de que los temas resulten lo más interesantes posible para los ganaderos.
Afortunadamente, las Jornadas Técnicas de Vacuno de Leche disfrutan de una excelente consolidación en el calendario del sector ganadero y suelen reunir a cientos de productores y veterinarios.
Como siempre, la asistencia es libre y gratuita y no se requiere inscripción previa, por lo que el registro y la entrega de material se realizarán in situ los propios días del evento.
El director general de la Asociación Empresarial Española de la Industria de Sanidad y Nutrición Animal (Veterindustria), Santiago de Andrés, asistió como invitado a la toma de posesión de Juan José Badiola, como presidente de la Organización Colegial Veterinaria (OCV), en un acto que estuvo presidido por Miguel Arias Cañete, ministro de Agricultura, Alimentación y Medio Ambiente, quien en su intervención señaló que “la profesión veterinaria está al servicio de la sociedad y volcada en la protección de la salud y el bienestar animal, la conservación y mejora de los recursos ganaderos, la promoción y la prevención de la salud pública y la conservación y defensa del medio ambiente”.


Por su parte, Badiola en su intervención, agradeció especialmente la presencia de representantes de organizaciones como Veterindustria por su labor esencial en la mejora de la sanidad veterinaria, además de subrayar el decisivo papel que tienen en España los profesionales veterinarios en el des-

arrollo ganadero y en el bienestar animal.
Al acto celebrado el pasado 12 de julio en la sede de la OCV, asistieron también entre otras personalidades y representantes sectoriales, el director general de Sanidad de la Producción Agraria, Valentín Almansa; el director general de Producciones y Mercados Agrarios, Carlos Cabanas; el vicepresidente del Consejo Asesor de Sanidad, Julio Sánchez Fierro; el director general de Investigación Científica y Técnica del Ministerio de Economía y Competitividad, Juan María Vázquez y el director del Instituto Nacional de Investigación y Tecnología Agraria y Alimentaria (INIA), Manuel Laínez.

Septiembre:
10-13 Space 2013. Rennes, Francia.
26-29 34º Concurso Nacional CONAFE’13 de la Raza Frisona. Gijón, Asturias
Octubre:
1-5 World Dairy Expo. Madison, Wisconsin (EE UU).
Noviembre:
1-10 Royal Agricultural Winter Fair. Toronto, Canadá.
9 Subasta de ganado vacuno Frisón de Castro de Ribeiras Do Lea. Castro de Rei, Lugo
14-15 X Jornadas Técnicas de Vacuno de Leche de Seragro. Facultad de Veterinaria de Lugo.

Entrada de ganado

Descanso
Mañana:
Concurso de Terneras y Novillas
Tarde:
XIII Campeonato Nacional de Manejadores
•II Encuentros profesionales CLAS SAT
•Subasta EUROGENES
Mañana:
Concurso de Vacas lactación y grupos
Entrega de los diplomas a la Mejores Vacas de la Evaluación Genética de Junio 2013

Merial pone en marcha la nueva campaña de Eprinex®

Bajo la denominación Historia de una vaca, la campaña presenta más de 15 años de experiencias y compromiso de Merial con la salud animal a través de la investigación y la formación de los profesionales.
El objetivo de esta iniciativa es dar testimonio de la mejora de la salud animal gracias al uso de Eprinex® y dejar constancia de los logros conseguidos desde el lanzamiento mundial del producto. Para ello, los mensajes se articulan en torno a 6 hitos que se pueden encontrar en la página web www.historiadeunavaca.es
El primero de ellos es la investigación, fruto de la cual se diseñó la eprinomectina y se lanzó, en 1997, bajo la denominación de Eprinex®.
El amplio espectro, gracias a la excepcional actividad endectocida; la eficacia, pues actúa frente a más de 10 especies de nematodos; la actividad, persistente entre 3 y 4 semanas; la seguridad, con períodos de supresión nulos para el consumo de leche; y los beneficios.
En este último hito es donde se resume el éxito de Eprinex® y se justifica su liderazgo, gracias a lograr disminuir el estrés, aumentar la ingesta, lograr una mayor ganancia de peso, incrementar la producción y la calidad de la leche, y mejorar la reproducción.
DeLaval, suministrador líder de soluciones para los productores de leche, ha adquirido Uniform-Agri, ubicada en Assen, líder en el suministro de sistemas de gestión de la información para los productores de leche.
En un entorno cada vez más automatizado de las granjas de leche, la gestión de los datos es la clave para lograr una explotación profesional y aumentar su eficiencia y rentabilidad
Este programa de gestión se caracteriza por un análisis minucioso que enlaza con procesadores y una base de datos contrastada. La compañía emplea a unas 40 personas.
Uniform-Agri continuará como empresa independiente dentro del Grupo DeLaval, manteniendo su nombre actual.
“Nuestro objetivo es seguir creciendo con Uniform-Agri a través de la actual red global de distribución e integrarnos en las nuevas oportunidades de negocio”, dice Jan-Ove Nilsson, nuevo Presidente del Consejo de Uniform Agri y Vicepresidente del Área Capital Goods de DeLaval International.

Harm-Jan Van der Beek, actual Director General y ex-dueño, continuará en su cargo de Director General de Uniform-Agri. Harm-Jan tiene una dilatada experiencia en el sector lácteo y ha desarrollado la empresa con gran éxito en los últimos 20 años.



La Academia de Ciencias Médicas de Bilbao y el Colegio de Veterinarios de Vizcaya organizaron el pasado 5 de Junio una Jornada sobre Fiebre Q, en el Colegio Oficial de Médicos de Vizcaya, dada la prevalencia de esta zoonosis en su entorno.
En ella intervinieron Francisco Pascual Velasco, del Hospital Comarcal de Laredo, Antón Esnal, de Analítica Veterinaria, Ana García, de Neiker Tecnalia y Antonio Jiménez, de CEVA Salud Animal.
En las diferentes ponencias se puso en evidencia la presencia y relevancia de esta enfermedad, su prevalencia en la especie humana y la importancia patológica en las explotaciones de rumiantes, destacando la vacunación como una importante medida de control.
Duran estuvo presente en la 53ª edición de la Feria Regional del Campo de Castilla-La Mancha (Fercam), que se celebró del 3 al 7 de julio en Manzanares (Ciudad Real).
En esta ocasión, las máquinas de recolección de forraje de las marcas Pöttinger y McHale –de las que Durán Maquinaria Agrícola es importador exclusivo para España– fueron las grandes protagonistas de la exposición,


En el stand de Duran, varios técnicos de la compañía mostraron a los interesados las características de varios equipos como la nueva rotoempacadora-encintadora Fusion 3, la segadora de discos trasera Novadisc 305, la segadora arrastrada Novacat 307 TRC equipada con la cinta sinfín “collector” y los rastrillos hileradores Eurotop 461 N (de un rotor) y Eurotop 881 A (de dos rotores e hilerado central).
La sembradora neumática de rejas con preparador delantero Optisem 5.40, una máquina desarrollada en y para España partiendo de la base del modelo Aerosem de Pöttinger y utilizando su técnica de sembrado, completó el conjunto de máquinas expuestas.

El 5 y 6 de junio, Madrid fue la ciudad escogida para la celebración de unas jornadas sobre Zactran® que contaron con la presencia de expertos nacionales e internacionales.

Allí se dieron cita 10 veterinarios españoles expertos en la producción de vacuno de carne (extensivo y cebaderos) y 3 invitados europeos: Fiona MacGillivray, director técnico de Rumiantes para Merial laboratorios en Inglaterra e Irlanda ; Cedric Dezier, director técnico de Rumiantes para Merial Laboratorios en Francia ; y Andy Forbes, director técnico de Rumiantes para Merial Laboratorios a nivel mundial.
El objetivo del encuentro fue el de poner en común la información disponible sobre el uso y los resultados con Zactran en distintos países. Respecto a la experiencia española, Josep Soler explicó y documentó los resultados de Zactran® en cebaderos de ternero mamón. Asimismo, Iñaki Espinosa habló del uso de Zactran® en cebaderos de pasteros en la zona del centro de España.
Por su parte, los ponentes europeos aportaron su experiencia en torno a la evolución de Zactran® desde su lanzamiento en sus respectivos países. Además, aprovecharon las jornadas para informar a los asistentes acerca del desarrollo de distintos proyectos de investigación que Merial está realizando para ampliar los usos de Zactran® en la prevención de diferentes enfermedades del ganado.


Este libro se editó en el marco del proyecto europeo FoodSMEHop cuyo objetivo fue ayudar a la empresas de la región del sudoeste europeo a innovar y desarrollar productos más saludables.
Este libro ofrece una revisión en cada una de las temáticas del proyecto, describiendo estrategias y/o alternativas para la reducción, substitución o adición de grasas, aditivos y sal en alimentos.
Se describen, además, los proyectos de demostración llevados a cabo en el marco del proyecto.
El libro se encuentra disponible en tres idiomas: español, francés y portugués en la página web del IRTA: http://www.irta.cat/es-es/RIT/Noticies/paginas/Llibre_FoodSME-Hop.aspx
AMOXOIL RETARD: Una sola inyección y nuevo periodo de supresión
Amoxoil Retard de Syva renueva su registro con una mejora en la posología, mediante la cual una sola inyección vía intramuscular proporciona una eficacia de 48 horas; y un nuevo período de supresión, especialmente favorable para porcino (25 días) y bovino (50 días). Laboratorios SYVA ha querido conjugar esta mejora significativa de la calidad de Amoxoil Retard, con otra ventaja que le posiciona como un producto más competitivo: su mayor facilidad de uso. Un estudio interno comparativo entre diferentes formulaciones de amoxicilinas inyectables del mercado, ha demostrado que Amoxoil Retard de SYVA es la suspensión que mejor relación guarda entre el coeficiente de sedimentación y su índice de Jeringabilidad; lo que supone una mayor facilidad de uso a cualquier temperatura (consulte los resultados completos de este estudio).


El IRTA y la Carnicería Planagumà de Olot (Girona), han firmado un acuerdo de colaboración para estudiar las características tecnológicas y sensoriales de la carne de bovino madurada.



La inquietud de los dos hermanos Albert y Aleix Planagumà para mejorar continuamente la calidad de sus productos los ha llevado a viajar por todo el mundo, aprendiendo distintas formas de trabajar la carne (de Olot a París, Londres, Nueva York, Sidney...). Actualmente, la Carnicería Planagumà está centrando sus esfuerzos en proporcionar a sus clientes un producto diferenciado y de gran calidad organoléptica, la carne de bovino madurada en seco (Dry-Aged Meat). La colaboración con el IRTA, del Departamento de Agricultura de la Generalitat de Catalunya, permitirá optimizar las condiciones de maduración para obtener de cada tipo de pieza la mejor ternura, aroma y sabor posible.
Este estudio tendrá una duración de 6 meses y finalizará con una jornada de presentación de los resultados conseguidos.




Parafraseando un título de Lucía Etxebarría, en esta edición de la Escuela de Preparadores ha habido de todo un poco: dudas los primeros días, curiosidad entre los novatos, algunas dosis de Dalsy para los pequeños y amor, que ya se sabe, está en el aire... Todo esto bien combinado da como resultado cinco intensos días de trabajo y vacaciones
No, no podemos decir que hizo buen tiempo del 1 al 5 de julio en Colunga: cielos grises, nieblas, orbayu, temperaturas que a penas alcanzaban los 20 grados... Sin embargo, no parecía importarle a nadie. No al menos a los veinticuatro alumnos inscritos en la octava edición de la escuela; alumnos entregados desde el primer día y con gran profesionalidad a las tareas marcadas por los profesores Javier Álvarez, Bonet Cid y Jaume Serra-





Esta edición se ha caracterizado por la amplia presencia de alumnos noveles (17 de los 24 asistían por primera vez) y la juventud de todos ellos, siendo la mitad menores de edad, destacando dos jovencísimas promesas, Eva Candamio y Miguel Rodríguez, de solo once años. Pero ni la falta de experiencia ni la poca edad desalentaron a este grupo de futuros expertos que al final de la semana coincidieron en haber aprendido muchas cosas y en haber hecho muchos nuevos amigos, que al fin y al cabo, es de lo que se trata: alimentar el sector con nuevos y entusiastas colegas con quienes compartir esta afición.
Como cada año, el curso comenzó con la formación de los grupos y la asignación de los animales: terneras para los más jóvenes e inexpertos y vacas en lactación para los más experimentados. A partir de ahí se abren tres grandes líneas de trabajo: la preparación del stand expositor y del alojamiento de los animales, con camas limpias y confortables; el lavado y pelado de los animales y, por último, la doma y manejo de los mismos.
Al principio, la mayoría se enfrentó a las mismas dificultades: integrarse en un grupo de desconocidos; superar el miedo a enfrentarse a un animal con una peladora en la mano; trabajar de sol a sol (es un decir, nos remitimos a las primeras líneas de este comentario). Pero son dificultades que se fueron superando poco a poco, gracias en gran parte a las reuniones diarias que cada grupo mantuvo con los profesores, en las que se trataban todas las incidencias de la jornada. Y gracias también a la asistencia del resto del cuadro técnico (Gabriel Blanco, Juan Manuel Fernández, Santiago Mato –los tres del Dpto. de Morfología de CONAFE–y Ángel







Amandi, del I.E.S. de Luces), de cuya constante y atenta mirada era difícil escapar.
SAT Zakarías
Fue elegido mejor equipo de la escuela por el cuidado de sus animales y el diseño del stand, a punto casi desde el primer día y ordenado y atractivo durante toda la semana.















Recordamos que los participantes pueden disponer para la construcción y decoración de su stand, del material que encuentren en la finca del I.E.S. de Luces: madera, ladrillos, telas, plantas, focos... Todos los equipos tienen las mismas oportunidades, es la imaginación de cada uno la que marca la diferencia. La única condición que pone el centro es que, una vez finalizada la escuela, todo quede como lo encontraron; y ésto es importante porque que se cumpla esta condición significa que los equipos han sido responsables con sus compañeros, con los animales y con el entorno. Volviendo a SAT Zakarías, el grupo trabajó muy bien y muy organizado, con los animales bien alimentados y el pelado bien hecho. Sus componentes, además, pueden presumir de haber sobrevivido al “huracán Avelino” (14 años), quien se encarga de animar con su imparable charla las jornadas de la escuela desde la edición de 2011, cuando participó por primera vez.
Aunque todos sus componentes coinciden en que al principio les costó integrarse y formar un grupo organizado, lo cierto es que lo consiguieron, llegando a ser elegidos 2º




















mejor equipo, a pesar de que el comentario de los profesores respecto a las camas poco profundas, a las tareas de pelado pendientes de hacer (hablamos de la tarde del jueves, víspera del campeonato) y a la tardanza en el montaje del stand, podía hacer pensar que lo iban a tener difícil. Pero no, el resultado final fue más que satisfactorio y presentaron sus animales bien cuidados y su stand sencillo, limpio y ordenado, exhibiendo la maqueta de la vaca ideal hecha en plastilina por Jaime Cobo, el artista del grupo.
La Cantera
Este grupo, llamado así en analogía a la cantera de jóvenes promesas del Barça, experimentó en opinión de los profesores una evolución muy buena durante toda la semana, llegando al viernes con un stand un poco recargado, pero lo más importante, con un equipo muy cohesionado y con muy buena relación entre ellos.





El Merengue
Los cuatro miembros de este equipo valoraron la experiencia como buena, incluso para repetirla. Fueron los que mejor evolucionaron a lo largo de los cinco días, tanto respecto al trabajo en equipo como en cuidado y preparación de los animales, aunque también les hubiera gustado practicar más el manejo. En cuanto al stand, no era muy llamativo, pero sí limpio, ordenado y bien resulto en general.
El Rastrillo
Los miembros de este equipo destacaron la buena experiencia que supone asistir a esta escuela, sobre todo por el compañerismo. ¿Qué hubieran cambiado?, menos preparación del stand y más manejo de los animales. Y también alguna clase de morfología, apunta María Manteiga, veterana participante y experta preparadora. Acabaron la semana con sus animales bien alimentados, sabiendo arreglar los desajuste iniciales; las camas bastante bien hechas y el stand muy ordenado y con elementos destacables, como el perfecto solado.
Elección del mejor grupo


La tarde del jueves se hizo la elección del mejor grupo, teniendo en cuenta la puntuación diaria hecha por los profesores y por los mismos alumnos, que valoraron tanto su propio stand y trabajo en general, como el de los otros equipos. Como dijo Jaume Serrabassa en nombre de los profesores, este año el nivel de los equipos y los stands ha estado más igualado que nunca; ha habido buena armo-



nía y buen trabajo en general, por lo que la elección del mejor equipo resultó difícil.
Los aspectos que que Javier, Bonet y Jaume valoraron cada jornada fueron el mantenimiento de las camas, el pelado que se iba haciendo cada día, la coordinación como equipo, la alimentación de los animales y los stands.
Teniendo en cuenta todo ésto y según la suma de los puntos obtenidos cada día, resultó segundo mejor grupo de esta escuela el Perejí Júnior y como mejor equipo –no stand–, SAT Zakarías. Probablemente, destacó Jaume, si únicamente se valorara el montaje y decoración del stand, hubiera resultado en primer lugar Perejí Júnior, aunque con algunos retoques. En cualquier caso, la diferencia entre los cinco equipos fue de décimas, por lo que los tres grupos restantes están al mismo nivel.
Pero las celebraciones de los grupos ganadores duraron poco porque había que seguir trabajando en la puesta a punto de los animales, cuya preparación y manejo serían juzgados en la mañana del viernes.
Llegado el gran día de la valoración del trabajo individual, el espíritu de equipo siguió siendo la clave de la jornada: todos los alumnos se echaron una mano para que cada uno saliera a pista en las mejores condiciones.
La categoría de adultos, con diez participantes, fue la que inició el concurso con el fin de servir de modelo a los más jóvenes. Oscar Castro fue elegido mejor preparador y segundo manejador y Jon Arrechea, segundo preparador y












tercer manejador. Como mejor manejador adulto fue elegido Marcos Rivas, que en todo momento paseó a su animal muy tranquilo, aplomándolo muy bien y siempre atento a las indicaciones del juez.
A continuación salió a pista la categoría de juveniles, con ocho participantes. Fue elegida mejor preparadora María Manteiga, que desde que comenzó a participar en las escuelas en 2010 ha ido progresando primero como manejadora y luego también en la preparación de los animales. El segundo puesto de preparadores fue Plácido Mayo (tercer manejador).

En cuanto al concurso de manejadores, se impusieron dos veteranos alumnos: , que mostró muy bien su animal, con tranquilidad, parándolo bien y siempre atento al juez. Por su parte, María Manteiga, segunda manejadora, controló muy bien a su animal, a pesar de llevar una cabezada demasiado
Entre los seis participantes de la categoría infantil, también se impusieron dos jó-

venes veteranos: como mejor preparadora y manejadora, Cristina Carro, con su habitual buen hacer, mostrando muy bien a su animal, corrigiendo los defectos y haciendo que pareciera siempre vivaz; como segundo preparador y manejador, Avelino Souto, demostrando de nuevo que es capaz de combinar trabajo y diversión a partes iguales. El tercer manejador fue Jorge Vázquez
En la final de manejadores se impuso como Campeona Cristina Carro, acostumbrada ya al triunfo después de alcanzar la tercera posición del campeonato en las ediciones de 2011 y 2012. El título de Subcampeón fue para Marcos Rivas y Miquel Vanrell obtuvo el tercer puesto. Eva Candamio alcanzó la Mención Especial que los profesores otorgan en cada edición al alumno que destaca por su comportamiento y aprendizaje.
Concluido el concurso, no acabaron las prisas: los alumnos tuvieron que regresar rápidamente a la nave de estabulación para dejar los animales, desmontar la zona de exposición y recoger todo el material utilizado durante estos días, para





después pasar por las duchas y aparecer en la entrega de premios en perfecto estado de revista.
En esta entrega de premios nos acompañaron Mª Rosa Urdiales (Dtra. general de Ganadería de Asturias), José Emilio García y Carlos Méndez (Presidente y Gerente de ASCOLAF), Miguel Ángel Forascepi (Inspector de Educación del Principado), los representantes de Caja Rural de Asturias Javier Nievas y Enrique Corte (director de la oficina de Colunga) y la Directora Gerente de CONAFE, Sofía Alday.
El Presidente de ASCOLAF, colaboradora con CONAFE en la organización de la escuela, dio las gracias a los demás colaboradores ASA, Caja Rural, Servicio de Podología Pura y, sobre todo, al I.E.S. de Luces, representado por su Directora Elsa Carbonell, y por la Jefa de Estudios, María Soledad Martínez. “A los que estamos relacionados con el campo y la producción de leche –añadió José Emilio García–nos satisface ver que a la gente joven le gustan las vacas. Al final, necesitamos gente que haga vacas; es muy importante porque haciendo vacas, tendremos leche y podremos vivir del sector en el futuro”. El Presidente de ASCOLAF finalizó su discurso dirigiéndose a los participantes de esta 8ª Escuela de Preparadores reiterando su satisfacción al ver la ilusión, incluso de los más pequeños, y las ganas de vivir de las vacas. “No perdáis la ilusión y muchos ánimos para que en un futuro seáis vosotros los que manejéis las explotaciones y sepáis llevar adelante la producción de leche y defender al sector, que mucha falta hace; defenderlo y que no se muera”.
De nuevo agradecemos la participación de las empresas colaboradoras y, como siempre, el agradecimiento a todos los que se han implicado más allá de sus obligaciones profesionales: el personal de cocina y los encargados de la ganadería del Instituto; a Juan Prado y Ángel Amandi, “nuestros hombres en Luces”; a Ángel de Podología Pura, por su explicaciones. Todos han hecho posible esta Escuela. Si como parece, a los alumnos les han quedado ganas de repetir el próximo año, significa que se han cumplido los objetivos de esta convocatoria.


Sección de manejadores infantiles

Sección de manejadores juveniles

Sección de manejadores adultos
 En la foto de la izquierda, de izquierda a derecha. José Emilio García, Rosa Urdiales, Enrique Corte y Elsa Carbonell. En la foto de la derecha, Sofía Alday, Carlos Méndez, Miguel Ángel Forascepi y María Soledad Martínez.
En la foto de la izquierda, de izquierda a derecha. José Emilio García, Rosa Urdiales, Enrique Corte y Elsa Carbonell. En la foto de la derecha, Sofía Alday, Carlos Méndez, Miguel Ángel Forascepi y María Soledad Martínez.

Campeonato de Manejadores (de derecha a izquierda)
1ª Cristina Carro Mosquera
2º Marcos Rivas López

3º Miquel Vanrell Garau



Categoría infantiles (de 11 a 14 años)
1ª y 1ª Preparadora Cristina Carro Mosquera, 14 años (A Coruña)
2º y 2º Preparador Avelino Souto Rozados, 14 años (Pontevedra) y
3º Jorge Vázquez Cuñarro, 12 años (Lugo)
4º Miguel Rodríguez Madueño, 11 años (Córdoba)
5ª Eva Candamio Freire, 11 años (A Coruña)
6º Manuel Candamio Freire, 13 años (A Coruña)
Categoría juveniles (de 15 a 18 años)
1º Miguel Vanrell Garau, 18 años (Baleares)
2ª y 1ª Preparadora María Manteiga Rodríguez, 17 años (Pontevedra)
3º y 2º Preparador Plácido Mayo Franco, 15 años (Asturias)
4º Iván Torrado Morado, 16 años (A Coruña)
5º César Díaz Abraira, 15 años (Lugo)
6º Jorge Albesa Valls, 16 años (Teruel)
7º Joan Lleal Nogué, 17 años (Girona)
8º Roger Andorra Bonet, 18 años (Lleida)
Categoría adultos (a partir de 19 años)
1º Marcos Rivas López, 20 años (Lugo)
2º y 1º Preparador Oscar Castro García, 30 años (Lugo)
3º y 2º Preparador Jon Arrechea Unanua, 23 años (Navarra)
4º Jaime Cobo Pelayo, 23 años (Cantabria)
5º Iván López Díaz, 19 años (Lugo)
6º Koldo Zazpe Urmeneta, 22 años (Navarra)
7º Lorenzo Bosch Fedelich, 34 años (Baleares)
8º Joan Miquel Jorda Bagaria, 19 años (Girona)
9º Julen Ancizu Marckert, 20 años (Navarra)
10º Marc Bigas Munuera, 19 años (Barcelona)



Irún (Guipuzcoa) 1 de julio de 2013
Juez nacional de CONAFE: Franciso Javier Freije Freije
Resultados del Concurso
Sección 1ª: Terneras menores de 12 meses
1ª Casa Nueva Shottle Bimba E.T./Casa Nueva (Carranza)
2º Ondazarte Dude Ura/Ondazarte Gain ( Igueldo)
Sección 2ª Terneras de 12 a 18 meses
1º Ondazarte Lavanguard Beltxi/Ondazarte Gain (Igueldo)
2º Murrieta Windrook Inda/Murrieta ( Muskiz)
Sección 3º Terneras de 18 a 30 meses
1º Ondazarte Tee Off Brigada/Ondazarte Gain ( Igueldo)
2º Casa Nueva Tee Off Megan/Casa Nueva ( Carranza)
Sección 4ª: Vacas menores de 36 meses en lactación
1º Murrieta Ashalar Lenina/Murrieta ( Muskiz)
2º Ardeo Duplex 1054/Ardeo (Gatika)
Sección 5ª: Vacas en lactación de 3 a 4 años
1º Murrieta Montgomery Fiona/Murrieta ( Muskiz-Bizkaia)
2º Murrieta Duplex Kira/Murrieta ( Muskiz-Bizkaia)
Sección 6ª. Vacas en lactación de más de 4 años
1º Poyu Bolton Flor/Poyu ( Arrankudiaga-Bizkaia)
2º Finaga Goldwyn Zoraida/Finaga ( Basauri-Bizkaia)
Novilla Gran Campeona
Ondazarte Tee Off Brigada
Vaca Gran Campeona
Murrieta Montgomery Fiona
Mejor Ubre
Murrieta Montgomery Fiona
Mejor hija de toros de Aberekin
Murrieta Duplex Kira


En el concurso participaron seis ganaderías, La guipuzcoana: Ondazarte Gain y otras cinco ganaderías vizcainas: Murrieta, Poyu, Casa Nueva, Finaga y Ardeo, con


Novilla Gran Campeona y Vaca Gran Campeona con el Juez del concurso y los propietarios de los animales



 El Juez del concurso con la vaca Gran Camepona , A la derecha Novilla Gran Campeona y debajo los ganadores de los premios con los organizadores y patrocinadores del concurso.
El Juez del concurso con la vaca Gran Camepona , A la derecha Novilla Gran Campeona y debajo los ganadores de los premios con los organizadores y patrocinadores del concurso.




1 Vaca Gran Campeona.

Coterillo-Saro- (Cantabria) 11de agosto de 2013 Juez Nacional Conafe: Jaume Serrabassa
Resultados del Concurso
Ternera Campeona
Perejil Mariachi/Granja Perejil “El Macho”
Novilla Campeona
Perejil Moscona/Granja Perejil “El Macho”
Novilla Gran Campeona (Terneras y Novillas)
Perejil Moscona/Granja Perejil “El Macho”
Vaca Joven Campeona
Tezanillos Lara Croft Laramie/S.A.T Tezanillos
Vaca Intermedia Campeona
Tezanillos Spirte Extravanca/S.A.T Tezanillos
Vaca Adulta Campeona
Perejil Rimbonbanzia/Granja Perejil “El Macho”
Vaca Gran Campeona
2 Novilla Campeona
3.Mejor Rebaño
Perejil Rimbonbanzia/Granja Perejil “El Macho”
Mejor Ubre:
Perejil Rimbonbanzia/Granja Perejil “El Macho”
Mejor Rebaño : S.A.T Tezanillos
Segundo Mejor Rebaño: Granja Perejil “El Macho”
Mejor Criador: Granja Perejil “El Macho”
Segundo Mejor Criador: S.A.T Tezanillos



El concurso resultó ser un mano a mano entre dos ganaderías Granja Perejil “El Macho” y SAT Tezanillos. Donde Perejil el Macho consiguió el pemio de Vca Gran Campeona con Perejil Rimbombanzia que superó a Tezanillos Gollwyn Cancelara por una ventaja clara en su sistema mamario con mejores inserciones de la ubre, anterior mucho más agarrada, posterior más ancha, mejor definición de su ligamento suspensor y mejor textura. Vaca muy angulosa y armónica. Fácil ganadora combinando una gran estructura lechera, angulosidad y el mejor ubre del concurso





Llanera (Asturias) 17 de agosto de 2013
Juez Nacional Conafe: Jaume Serrabassa
Resultados del Concurso
Ternera Campeona
Venturo Atwood Davinia/Casa Venturo
Novilla Campeona
Badiola Sid Kenda/Ganadería Badiola S.L.
Novilla Gran Campeona (Terneras y Novillas)
Badiola Sid Kenda/Ganadería Badiola S.L.
Vaca Joven Campeona
Venturo Xuanuco GW Almudena-ET /Casa Venturo
Vaca Intermedia Campeona
Badiola Damion Coqueta /Ganadería Badiola S.L.
Vaca Adulta Campeona
Badiola Goldwyn Silvana/Ganadería Badiola S.L
Vaca Gran Campeona
Badiola Damion Coqueta /Ganadería Badiola S.L.
Mejor Ubre:
Badiola Goldwyn Silvana/Ganadería Badiola S.L
Mejor Rebaño : Ganadería Badiola S.L
Campeona Novillas
Ascol: Serafo Emilyson Paulina/Fernando Prendes
Campeona Vacas
Ascol: Castiello Mclaren Divina /La Pineda

Fecha: Horta 13-14 de julio de 2013
Vaca Campeona: PT 017058353
Propietario: Manuel da Silva Gonçalves
Juez: Bonet Cid Salgado


Concurso bonito de juzgar ya que había animales de varias islas (Faial, Pico, Terceira y San Miguel). Buen ambiente y buenas terneras y novillas.
Gran Campeona: Fue la vaca intermedia, nº PT017058353, una hija de Minister, propiedad de Manuel da Silva Gonçalves. Lages - Ilha do Pico. Concretamente una vaca de 4 años de edad, fácil ganadora por tener la mejor estructura, la mejor ubre y las mejores patas de todos los animales participantes.
La novilla Gran campeona fue una novilla de 24 meses con buena estructura lechera acompañada de unas magníficas patas y muy buen desarrollo para su edad
La ternera campeona tenía 12 meses, nos demostraba buenos aplomos, buen desarrollo y una buena estructura lechera.



Fecha: Hódmezóvásárhely 26-28 de abril de 2013
Vaca Campeona: Stefi
Concurso con un nivel muy correcto, con animales muy notables en las primeras posiciones y con secciones con bastante participación en general.
En el primer campeonato el Junior Championship la ganadora fue Havas una novilla hija de Willow-Marsh-CC Gabor-ET que se impuso a Tóbiás una ternera hija de Ladys-Manor Ruby Shout-ET, mejor en capacidad corporal, mejor tercio anterior, mejor costillar anterior y una grupa mucho más ancha. Como mención honorífica fue nominada una ternera hija de Regancrest Dolman-ET de nombre Rózsi.



El segundo campeonato del concurso fue el de vacas jóvenes en el que participaban las ganadoras de las secciones de vacas de 2 años júnior y sénior y las vacas de 3 años júnior y sénior también. La campeona fue la vaca de nombre Módé, hija de Magor GB Baroque Allen-ET al superar en estilo, feminidad, angulosidad, mejor balanceada y más armónica en general, con una ubre anterior con mejor inserción y una grupa con mejor relación isquionilión.
El campeonato de vacas adultas fue para la vaca de nombre Stefi, hija de Rietben Charge-ET al superar a Boukje, una hija de Regencrest-MR Samuelo. La campeona que fue elgida GrVaca Gran Camepona del concurso, es una vaca con mejor sistema mamario, mejor en inserción anterior, adornada con más venas, con mayor fortaleza en su tercio anterior y con ventaja también en sus patas, mejores a nivel de fortaleza de cuartillas.
La reserva fue también la subcampeona de adultas anteriormente mencionada.
El mejor sistema mamario del concurso fue para la vaca de nombre Csiri una hija de Gavor.
Los tres mejores toros para TIPO del top 50 genómico (Conafe 06/2013)

REPICÓN
• Nº 1 en ESTRUCTURAS: +2,35
• Nº 2 en TIPO: +2,76
• LECHE: +1.190 kg
• ICO: 3.247
• Familia “WANJA”

Hill x Atwood x Mac x Durham
• Nº 1 en TIPO: +2,98
• Nº 1 en UBRE: + 3,10
• LECHE: +1.194 kg
• ICO: 3.320
• Familia “BARBIE”
Epic x Man O Man x Duplex x Jocko Besn

GOLDOURO

Heidenskipster
GOLDOURO
• Nº 3 en TIPO: +2,62
• Estructuras, ubres y patas con estilo y angulosidad
• LECHE: +1.348 kg
• ICO: 3.370
• Familia “CONVERSE JUDY”





“Este es un laboratorio de servicio y su objetivo es ser rápido, fiable y totalmente independiente de las partes implicadas en el sector”
 María Hermida. Directora de la Finca de Mouriscade
María Hermida. Directora de la Finca de Mouriscade

Frisona Española.- La finca de Mouriscade –de 44 ha y atravesada por la carretera y el ferrocarril y bordeada por el río–fue comprada por la Diputación de Pontevedra en 1972 por 10 millones de pesetas. ¿Con qué finalidad se compró?
María Hermida- La Diputación quería establecer con el sector ganadero alguna relación y la manera que tenían para hacerlo era comprar la finca. La Diputación de Pontevedra ya tenía otras fincas en la provincia, pero el sector ganadero de frisón estaba en esta zona y ese fue el motivo por el que buscó la finca aquí, en Lalín.
La finalidad, fundamentalmente, erafomentar la ganadería de frisón. Estamos hablando del año 1972, un momento en el que casi todo era raza rubia gallega y la raza frisona apenas estaba introducida.
F.E.-¿Cómo ha ido evolucionando la finca y su actividad hasta ahora?
M.H.- En 1990 es cuando se produce un cambio importante con la creación del laboratorio, aunque la ganadería había empezado a funcionar antes importando vacas desde Alemania, que luego se subastaban aquí para que los ganaderos tuvieran facilidad para comprar animales de calidad.
El laboratorio, que empezó a trabajar en agosto de 1990, nace con la idea de ser el Laboratorio Interprofesional de Leche para Galicia, pero se queda un poco relegado a segunda posición porque coincidió con la entrada en funcionamiento del laboratorio interprofesional de Coruña.
F.E.-¿Qué servicios realizaba y a quién se dirigían?
M.H.- A la industria, para la recogida de muestras y realizar las analíticas en calidad de leche.
Pero ya en el año 1993 se empieza a trabajar con los ensilados, forrajes sobre todo, y empezamos a darle la vuelta a todo el laboratorio hacia la alimentación animal.
F.E.- ¿La analítica de leche ha quedado en segundo plano?
M.H.- Hoy ya no se hace calidad de leche; se siguió manteniendo hasta el año 2000, pero a un nivel muy reducido. Lo que sí mantenemos en leche, es la identificación de gérmenes en mamitis, que comenzó en el año 1995. Queda reducido su uso casi solo para la provincia de Pontevedra, y para esta comarca.
Como decía, es a partir del año 93 cuando en alimen-
tación animal empezamos a trabajar el tema de ensilajes y ensilados, incrementando las analíticas con piensos y materias primas, hasta el momento actual, en el que ya estamos totalmente centrados en ésto.
F.E.- ¿Los servicios que ofrecéis ahora sobrepasan el termino de la Comunidad Autónoma?
M.H.- En este laboratorio, en este momento, se trabaja para toda España y Portugal. El servicio ha ido evolucionando en diferentes fases haciendo cada vez más analíticas y, además, complementándolas.
F.E.- ¿El servicio es directo con el ganadero o a través de empresas?
M.H.- Es como se demande, un ganadero puede venir aquí con su propia muestra, pero lo normal es que sean las empresas o a través de cooperativas o de asociaciones que junten las muestras y que sea su servicio técnico los que conectan, tanto para el envío de muestras al laboratorio, como para la interpretación de resultados.
Nosotros analizamos las muestras, pero nunca vamos a interpretar nada; no vamos a decir si ésto es bueno o malo, sino que lo que venía en esta bolsa nos ha dado este resultado, nada más.
F.E.- ¿El servicio tiene un coste determinado por muestra, por contrato de servicio?
M.H.- Nosotros cobramos todas las analíticas, de hecho los precios están colocados en la web, son precios oficiales. La facturación es lo que nos permite mantener el servicio.
F.E.- ¿Qué parte del presupuesto general se cubre con el coste de los servicios?
M.H.- No se cubre el 100% pero sí una parte muy importante. Tampoco es nuestro objetivo. El objetivo es dar un servicio y poner a disposición del sector un laboratorio analítico. Hoy en día recibimos muestras de toda España y Portugal.
F.E.- Las empresas de alimentación ¿qué envían a analizar? ¿muestras de sus clientes, de sus productos?
M.H.- Las empresas de alimentación tienen dos tipos de demanda hacia a nosotros: por un lado, dar servicio a sus clientes analizando los productos que utilizan en la composición de sus raciones, y por otro lado, lo que hacemos es servir de garante de calidad de muchas industrias. Algunas






Distintas salas del laboratorio (fotos 1, 2, 3 y 4). Equipo de absorción atómica para determinación de minerales, calcio, sodio, potasio, hierro, manganeso, zinc, cobalto... algo que está cada vez más demandado en la alimentación animal -según comenta Maríapara ver la necesidad de cubrir ciertos rasgos de carencia de estos minerales y también para evaluar, en el caso del zinc o del cobre, los residuos que puedan salir a los purines.


“Lo que estamos haciendo con el HPLG –explica la Directora de Mouriscade–es la determinación de azúcares en harinas de soja, sacarosa, rafinosa y estaquiosa. Disponemos de dos equipos totalmente automatizados con un carrusel de 20 posiciones, cada uno de ellos, para la determinación de nitrógeno y proteína. El parámetro proteína sigue siendo muy importante en alimentación animal, tanto en el valor nutricional que puedan tener materias primas como los piensos, pero también su control de calidad es muy importante por lo que supone económicamente a la hora de comprar una materia prima. Es uno de los parámetros acreditados por ENAC sobre el que realizamos un exhaustivo control de calidad, utilizando patrones de referencia mediante la utilización de muestras que nos permitan asegurar al máximo su valor. Tanto las básculas como las balanzas nos mandan las pesadas al ordenador y una vez recogidos por los equipos a través del programa, devuelven los datos al mismo programa”.
Cualquier muestra (fotos 6, 7 y 8) tiene un total control de su trazabilidad; desde el momento que entra en recepción y se le coloca un código de barras, hasta que sale el certificado. “Las normas de acreditación así lo exigen –apunta Hermida–y sería casi imposible medir 54.000 muestras sin esa trazabilidad y sin ese control”.
Debajo (9 y 10) equipo Nirsystem para puebas NIR nuevo y el antiguo
“El laboratorio está acreditado por ENAC desde el año 2005 y eso también hace que nuestro trabajo tenga un valor añadido”

han cerrado sus laboratorios y han externalizado ese servicio y en estos momentos tenemos contratos con varias empresas de Galicia y del resto de España. Estamos analizando tanto las materias primas que ellas reciben como los piensos que fabrican.
F.E.- Además de Portugal ¿trabajáis con empresas de otros países?
M.H.- Sí, desde hace tiempo trabajamos con dos empresas alemanas bastante importantes.
Hace dos o tres años pusimos en marcha unas determinaciones analíticas en harinas de soja para ver qué tipo de procesamiento sufrían; son los inhibidores de tripsina, la solubilidad en KOH, el PDi, factores que permiten evaluar el tratamiento térmico que ha sufrido la harina de soja. La harina de soja, como fuente de proteína vegetal más utilizada en alimentación animal, tiene un coste muy elevado, pero ahora mismo ya no sirve saber que esa harina es del 44% o del 47%; lo importante es saber si esa proteína está bien procesada y vamos a tener un aprovechamiento total de los aminoácidos. Estas son las analíticas que nos piden desde Alemania.
F.E.- ¿Sobre qué producto hacéis mayor volumen de analíticas?
M.H.- En materias primas sería la harina de soja la que más se analiza, ¿por qué? por su precio, que influye mucho en el coste de la alimentación.
En el año 2012, hemos hecho análisis de 54.000 mues-



















María nos enseña las muestras de la “hemeroteca”. La etiqueta indica que este es un maíz de importación recogido en el puerto de Coruña, el proveedor, la fecha de recogida. Se muestreó cuando estaba saliendo del barco a los camiones. Estas muestras están aquí seis meses, precintados. Forma parte del proyecto GMP Galis puesto en marcha, desde el año 2005, por los fabricantes de piensos de Galicia, que hizo un protocolo para el muestreo de materias primas en puertos A la derecha detalle de la planta del Laboratorio de alimentación animal.
tras, de estas, 22.000 son ensilados y el resto son piensos y materias primas, de esas 32.000 restantes, tenemos de todo, y los piensos igual. El mayor volumen es para vacuno, pero analizamos piensos para gallinas, conejos, caballos, perros, gatos..., ahora mismo de todas las especies.
Dentro de las analíticas hacemos el análisis químico con determinación de humedad, proteína, fibras, cenizas. Aquellos parámetros que te dan indicación de su calidad; pero el laboratorio fue evolucionando y se puso en marcha el laboratorio de microbiología en el que analizamos unos cuantos parámetros, los interesantes en alimentación animal como E. Coli, salmonela, estafilococos, clostridium, levaduras, recuento de enterobacterias, etc., esa parte del laboratorio cada vez tiene más importancia.
Otra línea que se puso en marcha fue la analítica de minerales, para conocer los niveles de calcio, fosforo, sodio, potasio, magnesio, cobre, hierro manganeso, zinc... es algo que en alimentación animal cada vez tiene más importancia. Se ve una evolución muy grande en alimentación animal desde el año 93-95 en que hemos empezado a trabajar en el laboratorio con lo que necesitaban los técnicos en aquel momento y lo que quieren hoy día. Es muy diferente. En aquel momento un análisis con NIR de proteína y materia seca ya casi era suficiente; hoy eso, el técnico casi lo sabe a priori viendo la muestra, porque él en el campo hace un seguimiento de eso. Sin embargo, conocer el análisis microbiológico de determinados parámetros que están dando indicación de por qué las cosas no van bien, o conocer el nivel de minerales en un forraje para saber si se tiene que complementar con correctores o no, es algo que se ha ido realizando en estos años.
F.-E.- ¿Qué influencia ha tenido en este proceso el abaratamiento de las raciones?
M.H.- Tiene que mucho que ver. Viene condicionado por eso, adaptar lo máximo posible dentro de las necesidades nutricionales, reducir el coste económico de alimentación. Esto solamente se puede hacer si conoces la analítica de todos los productos para poder sustituir unos por otros.
Hace tiempo, el análisis del silo se hacía una vez al año. Hoy, los técnicos lo analizan constantemente, a media que el frente del silo avanza, porque se sabe que influye el estar abierto y que no todo el silo es uniforme y homogéneo. Por eso, en una buena explotación, el técnico analiza la ración unifeed cada quince días normalmente; hay un seguimiento constante y eso requiere más analítica y afinar cada vez más, para que los costes económicos se reduzcan y los beneficios sean mayores.
F.E.- ¿En el laboratorio se prepara al ganadero, al técnico?
M.H.- Hacemos unas jornadas de alimentación animal una vez al año, pero son jornadas de otro tipo. No hacemos cursos de formación porque no tenemos espacio físico disponible, esperemos que con la construcción del nuevo centro, que quedará este año licitado, lo hagamos. Se prevé un
aula para formación. Sobre todo para tratar de acercar conocimientos, nuevas técnicas, información de la que disponemos a los técnicos que trabajan con nosotros o a los propios ganaderos.
F.E.- ¿Qué plantilla tiene actualmente el centro ?
M.H.- Somos treinta personas en el laboratorio y once en la ganadería. Una de las finalidades del centro nuevo es adaptar las instalaciones al trabajo que ahora tenemos, porque el centro actual no está bien acondicionado fisicamente para ello, y la otra finalidad es disponer de espacio para poder hacer nuevas cosas.
Ahora mismo hay análisis muy demandados en el sector de la alimentación animal –micotoxinas, abonos, purines...–y no disponemos de espacio físico para poder empezarlos. Es decir, que tenemos ahí líneas pendientes de abrir, que podemos abordarlas con las mismas técnicas que usamos, que ya están rodadas, y tenemos el personal altamente cualificado, pero no disponemos de ese espacio para poder abordarlo. La idea es seguir creciendo, seguir dando servicio al sector e ir complementando.
F.E.- ¿Cuál es el presupuesto que maneja el laboratorio?
M.H.- Un millón ochocientos mil euros para toda la finca, laboratorio, ganadería, planta de biogás, etc.
F.E.- Durante los últimos años que se ha producido una disminución de ganaderos productores de leche ¿ha disminuido el número de muestras a analizar en el sector lácteo?
M.H.- En alimentación se ha incrementado el número de muestras, son vacas que necesitan más control. La producción necesita más control y en esto el ganadero no está escatimando.
Cada día son enviadas a este centro mayor número de muestras a pesar de los recortes; los ganaderos y las empresas del sector de alimentación animal no escatiman en analíticas para conocer más y mejor lo que comen los animales, pudiendo hacer un mejor aprovechamiento tanto nutricional como económico. Por eso nosotros no hemos notado una bajada.
F.E.- ¿Hay muchos ganaderos que a título individual solicitan análisis de muestras de productos de alimentación?
M.H.- Sobre todo de ganaderos de la comarca, porque les es muy cómodo el acceso al laboratorio, lo traen ellos mismos. También lo algunos de fuera a través de un transporte, ganaderos que no están de acuerdo con la valoración que les hace la empresa que les da servicio. Lo que sí respetamos, al cien por cien, es que los resultados analíticos siempre son del que envía la muestra, ya sea ganadero, cooperativa o industria. El ganadero a veces desconfía de lo que le están vendiendo y piensa que no cumple con lo que le está en la etiqueta; por ejemplo, traen a analizar un pienso con un 20% de proteína con el que las vacas no responden. Lo que sí garantizamos es la confidencialidad, nosotros nunca preguntamos si este pienso es de esta fábrica o de la otra, ni queremos la etiqueta. Nosotros lo analiza-


Comederos para ensayos. El animal tiene una tarjeta que le va a identificar cuando entra al puesto de alimentación. Puede entrar en el puesto que quiera, se pesa lo que hay en la cubeta, cuando sale, se vuelve a pesar y en ese cúmulo de pesadas en 12, 24 horas, se mide la cantidad de comida que utilizó. Estos parámetros se relacionan con el estudio que estés realizando sobre producción, calidad leche etc. Se rellena la cubeta tres veces al día. La ración puede ser distinta que la del resto de la sala.
mos y lo que da es lo que se lleva el ganadero en un certificado, somos totalmente independientes
El laboratorio dispone, desde el año 2.005, de un servicio en internet para recoger los resultados de las analíticas. Ese servicio a través de la web supuso un avance muy importante para el laboratorio; es decir, que un técnico que se encuentra en casa del ganadero y que desde allí puede directamente acceder a los resultados de las muestras que envió la semana pasada o el día anterior, supone un gran avance para el laboratorio y sobre todo para nuestros usuarios. Hoy es muy utilizado, cada cliente dispone de su contraseña y usuario para acceder a sus muestras.
Tenemos un programa propio de gestión de las muestras y de la transferencia embrionaria que va al servidor central de diputación.
Ganadería Finca de Mouriscade
F.E.- Las vacas frisonas son las primeras que entraron en esta finca y hoy mantienen su presencia en la misma ¿cómo ha ido evolucionando la ganadería es estos años?
M.H.- En este momento tenemos en la granja 109 animales en total: 64 vacas adultas, siempre con 50-55 en lactación, y el resto novillas y terneras.
La ganadería fue pasando por diferentes momentos. Al principio era una ganadería de leche normal y corriente, pero con el tiempo se vio que había que dar algún cambio, dotarla de algún valor añadido y en el año 98 se empieza a trabajar en transferencia embrionaria, se hace una selec-




Los dos parques de la nave de estabulación adultas en producción arriba y primerizas, secas, novillas y terneras, abajo. Cúbiculos con bicarbonato cálcico y serrín. ción de los animales para quedarnos con los mejores y se comienza a seleccionar genéticamente. Esta es una de las líneas de trabajo que tenemos, hoy en día, para los ganaderos de la provincia de Pontevedra.
Ese trabajo nos ha llevado a que en los últimos años la ganadería salga evaluada por ICO con el número uno o dos de las explotaciones españolas. Por ejemplo, en la evaluación de junio 2013, está la primera con ICO 2273. F.E.- ¿El resto de ganaderos gallegos no tiene acceso a este servicio?
M.H.- No, tal como está establecido, no se da el servicio. Tampoco es demando, vamos también a decirlo.
F.E.- ¿Cuál es la media de producción de la ganadería?
M.H.- La media de producción es de 37 litros por vaca y día a dos ordeños. Pero el objetivo no es tener más litros, claro está que al tener vacas hay que producir leche y además es una de las fuentes de ingresos de la finca. Pero tenemos una cuota pequeña, 230.000 kg
F.E.- Si desaparecen las cuotas ¿se va a cambiar para producir más?
M.H.- No, es que no tendría razón de ser. Se trata de tener un cierto número de animales




con buena genética, que los ganaderos puedan acceder a ella, y mantener ese servicio.
Lo que hemos hecho recientemente con esos mismo animales de los que disponemos, que puedan producir buenos embriones y dar leche, es realizar ensayos en alimentación, algo que está dentro de la tónica general que desarrollamos. Proporcionamos datos de ingesta de diferentes calidades de un aditivo nuevo, de un producto nuevo que pueda utilizarse; probarlo para que una empresa o un organismo pueda disponer de un dato medio. Es algo nuevo que estamos llevando a cabo.
F.E.- ¿Tenéis alguna vaca fistulada?
M.H.- No, será el siguiente paso. Deberemos complementar eso.
F.E.- ¿Estos ensayos se hacen con todas las vacas del rebaño o se elige un grupo específico?
M.H.- Cuando planteamos un ensayo de alimentación, lo que hacemos es que, dentro del lote disponible de animales, ver cuáles pueden ser los que cumplen los requisitos. Depende lo que estés ensayando. Puede ser que metas vacas de primer parto o lotes lo más amplio posible. Tratamos de que entren todas las vacas disponibles, seleccionar el lote más conveniente al uso que se quiere realizar.
F.E. ¿Pero estos ensayos se hacen a petición de una empresa, no es por investigación propia?
M.H.- Hasta ahora llegaron por petición de las empresas.
F.E.- ¿La reposición se hace comprando vacas o con la propia recría?
M.H.- Las vacas son todas nacidas en la finca, se van seleccionando aquí, todo se recría. Lo que sí compramos son algunos embriones que interesen.
Sala de ordeño, 2 x 8 en espina de pescado. Las vacas usan podómetros para recogida de datos Novillas en su parque en la nave. Box de terneras, y abajo, nave de preparto, posparto y enfermería






F.E.- ¿De quién depende la dirección técnica de la granja?
M.H.- Yo llevo la parte de gestión general de toda la finca, pero en la granja hay tres veterinarios, que son los que se encargan de ese tema, de toda la parte de ganadería. La decisión sobre qué embriones comprar, por ejemplo, recae en los veterinarios, consensuada entre los tres.
F.E.- ¿Utilizáis toros del programa de Fontao?
M.H.- Si, estamos dentro del programa.
F.E.- ¿Vendéis o subastáis animales?
M.H.- Alguna vez participamos en la feria de Feiradeza, en Lalín, si tenemos disponible algún animal, porque tampoco nuestro objetivo es vender animales. Pero en esta feria sí solemos participar.
F.E. ¿Habéis participado en concursos morfológicos?
M.H.- No, en concursos no. No nos lo plantemos por el hecho de ser una ganadería de la Diputación.
F.E.- ¿Cuál es la composición de la ración que se está dando a las vacas?
M.H.- Es una ración unifeed en base a silo de maíz y silo de pradera complementada con harina de soja y harina de maíz y un corrector, ración que se distribuye una vez al día.
F.E.- ¿Varía la ración según la época del año?
M.H.- La estamos cambiando ahora cuando es necesario establecer un ensayo, pero nunca van a ser condiciones drásticas de cambio, porque lo que se pretende con esos ensayos es que los resultados puedan ser trasladados a la realidad, a lo que hay en el campo.
Se trata de ver qué ventajas o qué desventajas hay si se añade un producto; qué va a aparecer en la leche, más ácidos grasos o menos, más omegas o menos... ahí es donde sustituimos un componente de la ración normal por otro o añadir alguno especifico. Pero siempre teniendo en cuenta que lo que se haga, pueda ser llevado a la práctica, a la realidad, a lo normal.
F.E.- ¿A qué empresa estáis entregando la leche?
M.H.- En estos momentos a Lactalis.
F.E.- ¿El precio está negociado como cualquier ganadería?
M.H.- Sí, eso está claro; entregamos leche doble AA, con las primas que corresponden por producción, calidades, etc.
F.E.- ¿Qué precio os están pagando
M.H.- Ahora mismo estamos en torno a 39 cts. con calidades.
F.E.- ¿Tenéis firmado un contrato con Lactalis?
M.H.- Si, un contrato con revisión de precios cada tres meses.
F.E.- ¿Qué coste tiene el servicio de transferencia embrionaria para el ganadero?
M.H.- Está establecido también en el boletín de la provincia. Tenemos dos tipos de servicio; por un lado, el ganadero puede solicitar embriones de los que hay en el centro, los que producen nuestras vacas con unas características determinadas y que los implante el equipo de transferencia en esa granja. Por otro lado, el ganadero














Planta de biogás. A la izquierda, arriba, balsa de premezcla que recoge por un canal lo que arrastran las arrobaderas. Según nos explica María, “aquí podemos ajustar la cantidad de purín que nos conviene, echar más o menos y hacer la mezcla con los restos de los ensilados y de los piensos que tenemos del laboratorio”. La bomba homogeniza e impulsa esta mezcla al digestor, que tiene una capacidad de 240 m3. El disgestor está totalmente cerrado, dentro solo está el calefactor y el agitador.
“La mezcla que nosotros proporcionemos –continúa María–entra aquí y sufre el proceso metanogético a través de las bacterias que van en el purín y se produce el gas, que en un porcentaje del 60% va a ser metano. En la parte inferior nos queda el digestato. El gas pasa a la microturbina y al ser quemado produce electricidad y calor”. El digestato (2) es lo que sale a la balsa, que luego se va a utilizar como fertilizante para los campos.




Una microturbina quema el gas que vienen del digestor y lo comprime de 0,3 milabares a cinco bares, para que tenga la fuerza suficiente para quemarlo. Al quemarlo, la electricidad va a nuestro transformador al mismo tiempo produce calor. Una parte del calor vuelve por el circuito al digestor que lo tenemos a 37 ºC de rango mesófilo y otra parte del calor lo desaprovechamos en este momento. En el futuro tenemos que aprovechar este calor. Un ganadero, por ejemplo, podría utilizar ese calor en la sala de ordeño y en la calefacción de la casa, por ejemplo.

también puede solicitar que se haga el flushing a sus propios animales y después se haga la transferencia de los embriones en fresco o bien después de congelados. Los precios están estipulados; se trata de cubrir los costes mínimos del servicio.
Desde nuestro punto de vista no es caro, por ejemplo, un embrión de una vaca nuestra de hasta 84 puntos o sin calificar, son 150 €, que incluyen la preparación, la transferencia y el embrión. De vacas de 84 a 86 puntos, son 215 €, que incluyen lo mismo. El flushing en casa del ganadero, con la preparación, cuesta 230 €.
F.E.- ¿Cuándo se ha instalado la planta de biogás?
M.H.- La planta, que también forma parte de este centro, se inauguró en febrero de este año. Es una planta piloto, pequeña, de 30 Kw/hora en su máximo rendimiento. Fue un convenio hecho entre Consejería, Industria y Diputación de Pontevedra.
La planta está funcionando con el purín que producimos en la finca, proveniente de nuestra granja, y de los restos del laboratorio. Debido al volumen de muestras que analizamos, generamos gran cantidad de residuos que son muy aprovechables para la planta de biogás. Una vez pasado el tiempo que marca la acreditación de dos o tres meses, hay que desechar las muestras, y era un problema; ahora tenemos la planta para eso. Pero es una planta piloto y el objetivo es que el sector ganadero pueda tener datos reales de producción de energía eléctrica y calorífica a partir del purín de sus vacas. Aún no tenemos datos porque lleva funcionando desde febrero y son procesos
biológicos que lentos y hay que acumular datos de un cierto periodo de tiempo.
Esta planta produce energía eléctrica y calorífica que es utilizada en parte para el mantenimiento del digestor a 37 ºC. Pero nos está sobrando una parte de calor y esa parte que se está perdiendo, hay que aprovecharla en el futuro. El digestato que sale de la planta es el purín que utilizamos para nuestros campos. Porque en cuanto a la agronomía que tenemos en la finca, todo está cultivado con maíz y pradera, que se rotan, con la finalidad de conseguir forraje para nuestras vacas durante todo el año. De lquí la necesidad de utilizar el purín o el digestato que sale de la planta . Otro de los objetivos que pretendemos y que se realizará en un convenio con la Consejería de Medio Rural es la valoración ergonómica de ese digestato. Ahora mismo se ve que ese digestato no tiene el mismo olor que el purín, es menor, pero queremos probarlo, ver qué propiedades aporta a los cultivos, si es más o menos beneficioso que el purín en sí, en bruto.
F.E.- ¿El olor del digestato es menor?

M.H.- Es menor, una vez que el purín va a la planta de biogás, sale un purín con los mismos nutrientes pero sin materia orgánica y eso redunda en una disminución del olor, que se aprecia. Falta valorarlo en los cultivos.
F.E.- ¿La finca está toda cultivada?

M.H.- Totalmente cultivada y aprovechada, ya digo, con maíz y con praderas forrajeras. Además llevamos a cabo proyectos y ensayos con diferentes casas, por ejemplo, tenemos un campo de ensayo de maíz con la empresa Limagralin Ibérica S.A. y otro convenio con Fertiberia.




Durante la visita al I.E.S. de Luces con motivo de la Escuela de Preparadores, hablamos con Elsa Carbonell, su directora, y con Mª Rosa Urdiales, Directora General de Ganadería de Asturias, sobre el funcionamiento y proyecto del Instituto y la relación de la Consejería de Agroganadería con la formación ganadera.
Desde hace tres años, en el I.E.S. de Luces se han implantado ciclos nuevos de formación: dos de grado medio (producción agroecológica y jardinería y floristería), uno superior sobre gestión y organización de los recursos naturales y paisajísticos y también hay un PCPI (Programa de Cualificación Profesional Inicial) de auxiliar de explotaciones ganaderas. Este PCPI, por cierto, es el único ciclo que hay ahora propio de ganadería al 100%, comenta la del I.E.S., Elsa Carbonell. “Estamos contentos porque hay muchos alumnos y los resultados han sido muy buenos. En parte por el esfuerzo que se ha hecho en el centro y en parte por la situación general, el caso es que la matrícula en dos años se ha multiplicado por tres; hemos pasado de tener 47 alumnos en ciclos formativos en la familia profesional agraria a tener 150 este año”.
Dado el especial éxito del PCPI, lo ideal sería implantar un ciclo de grado medio para dar continuidad en la formación de explotaciones ganaderas, algo que ya está solicitado a la Consejería de Educación, pero cuya consecución no es ni rápida ni fácil. También está en fase de conversaciones la posibilidad de que el I.E.S. de Luces asuma parte del programa impartido por el centro de Villaviciosa, que se va a cerrar. Son acuerdos, sin embargo, en los que participan las consejerías de Educación y Agroganadería y en los que Luces, de momento, solo puede aportar su buena disposición, puntualizando, como hace su Directora, que “tenemos infraestructura y estamos reconvirtiendo espacios, pero para traer la escuela de agricultura necesitaríamos una buena dotación y ésto es lo que hay que hablar. Esto es un instituto y, si se quiere poner una escuela profesional, habrá que ofrecer también unas instalaciones adecuadas”

que podamos realizar allí las escuelas de Preparadores. El rebaño, que llegó a tener 126 cabezas, tiene en estos momentos 80 animales y para realizar el proyecto de producción agroecológica, se verá reducido a unos 40, suficientes para el programa de formación, ya que según Carbonell no necesitan tener una producción a nivel industrial. “Nuestro objetivo –apunta–es adaptarlo a nuestra base territorial, porque el gasto en pienso es enorme. No recibimos ningún tipo de subvención para mantener la ganadería y con la subida de los piensos y las materias primas, se nos pone muy cuesta arriba. Aunque vendemos la leche, gastamos más en alimentación y manejo que lo que recibimos por la venta”. “La primera intervención que tuvimos que hacer –continua Elsa Carbonell–fue equilibrar el rebaño, porque teníamos 40 vacas productoras y unas 80 de recría. Nosotros no podemos vender los animales sobrantes, debe ser en subasta pública, así que el proceso es lento, pero lo vamos haciendo y la idea es, si podemos, introducir en el próximo curso esta diversidad de animales”.
Otro proyecto relacionado directamente con el anterior es la creación de una asociación de alumnos y profesores, que se llamará “Granja de Luces”, para que se encargue durante todo el año de la producción, gestión y comercialización de la producción de la granja agroecológica, de la huerta y del invernadero, ya que el instituto, como centro público, no puede vender. Como nos explica la responsable de Luces, “sería crear un modelo de gestión, de producción y de comercialización de la producción agraria; es un proyecto educativo que consideramos revolucionario”.
Además de su programa formativo, el centro de Luces está trabajando en otros proyectos, entre los que destaca el de transformación a producción agroecológica, iniciado hace tres años. El objetivo es diversificar y crear una granja con ganado frisón, un apiario ecológico, un pequeño rebaño de razas autóctonas: cabras, oveja bermeja, un gallinero con pinta, asturiana de los valles…
Tradicionalmente en Luces ha existido una ganadería de ganado frisón asociada al centro, que permite, entre otras cosas, que los alumnos tengan una muestra para aprender a gestionar una explotación lechera y también,
Los alumnos con necesidades específicas que requieren una atención educativa especial son el objetivo de otro de los proyectos que enumera la Directora de este instituto asturiano. “Son proyectos que se adaptan a las nuevas demandas de la sociedad, que está cambiando continuamente. Antes, estos alumnos no llegaban a grado medio, pero hoy en día están en el sistema y tenemos que ofrecer una respuesta a esta demanda”. Ante un alumnado tan heterogéneo, en Luces han introducido el concepto de “aprendizaje por servicio” que funciona “como los equipos de la Escuela de Preparadores, donde el que más sabe enseña al que menos o al pequeño”, nos explica
Elsa Carbonell. Una Escuela, por cierto, que ha encontrado



María Rosa Urdiales, Directora General de Ganadería desde junio de 2012, es un rostroconocido en el entorno de CONAFE ya que nos ha acompañado en varias actividades, como el Concurso Nacional o la Escuela de Preparadores, donde participó en la entrega de premios.

ConafeMat es una aplicación de CONAFE disponible desde hace unos meses y a la que los socios pueden acceder a través de Sinbad
Su finalidad es facilitar al ganadero la tarea de selección de los toros más adecuados para cumplir sus objetivos de selección.

“Consideramos muy interesante el trabajo desarrollado por la Escuela de Preparadores de CONAFE, ya que contribuye muy activamente a formar profesionales para el manejo y preparación de las vacas que participan en concursos morfológicos, y dado su alto nivel de calidad y reconocimiento tienen más oportunidades en el mercado laboral. Muestra de ello es la gran demanda de los cursos, en los que tradicionalmente participan junto a alumnos españoles otros de diversas nacionalidades y varios alumnos de esta escuela ya han conseguido situarse entre los mejores del mundo. Por otro lado, la participación en los cursos que organiza la escuela, permite crear redes de intercambio de información que mejoran la comunicación entre los futuros ganaderos de vacuno de leche, contribuyendo activamente a su profesionalización”.
Sobre la relación entre la Consejería de Agroganadería y la de Educación para potenciar actividades como ésta y para promocionar ciclos formativos en ganadería, Urdiales explicó que la desde Agroganadería se presta la máxima colaboración que a nivel técnico sea requerida para promocionar actividades de este tipo. “No existen consignaciones presupuestarias para transferir de una a otra Consejería –según explicó–porque la financiación de los gastos de ambas se hace a través de los mismos Presupuestos Generales del Principado”.
A la pregunta sobre el posible cierre del centro de Villaviciosa y que el I.E.S. de Luces asuma parte del programa, la Directora de Ganadería manifestó que la Consejería de Agroganadería ha mantenido contactos con la Dirección del I.E.S. de Luces para solicitar la cesión de aulas del centro en caso de ser necesario, pero que el programa formativo seguirá gestionándose desde la propia Consejería.
Además de la colaboración con otros organismos, la Consejería de Agroganadería destina una partida presupuestaria anualmente para desarrollar un amplio programa formativo dirigido al sector ganadero y agroalimentario. “Un programa –indicó Rosa Urdiales–que además de publicarse en el Boletín Oficial de Principado de Asturias, está accesible a todos los interesados en la página web del Principado”.
Como punto de partida hay que establecer qué toros vamos a utilizar en el acoplamiento (los más usados en la ganadería, los mejorantes según criterios o toros específicos) y sobre qué hembras se va a llevar a cabo el acoplamiento. En el caso de las hembras se puede seleccionar novillas por edades, vacas por número y estado de lactación y animales individuales.
Una vez seleccionados los animales y establecidos los criterios de selección para determinar los niveles mínimos exigibles en los distintos parámetros del acoplamiento a la cría resultante, y los parámetros de configuración de acoplamiento, se obtiene una tabla con los datos de la hembra, su padre y hasta tres posibles sugerencias por orden de preferencia para el acoplamiento.
Los resultados del acoplamiento se pueden consultar de forma individual para cada hembra y también es posible descargar un fichero Excel con todos los resultados detallados del acoplamiento. se puede consultar una guía rápida y entrando en , con la clave personal, se puede acceder a la pestaña de Ayuda de la aplicación y descargar el manual de uso.



Estamos ante una ganadería en la que siempre se cuidó la gestión y el confort de los animales. Ahora, con un robot Lely trabajando, ha habido un antes y un después que les ha puesto a la cabeza de las explotaciones catalanas en kg de leche por vaca.

ANTECEDENTES
La explotación Parnau-Barcons, S.C.P. se encuentra en Fonolleres-Parlavà (Girona) una pequeña localidad del Bajo Ampurdán donde en 1972 empezaron a producir leche los padres de Miquel, Josep Parnau y Leonor Font.
Como anécdota Miquel aún recuerda como los primeros 15 días tuvieron que ordeñar a mano hasta que empezaron a hacerlo con una ordeñadora de olla. Luego continuarían haciéndolo con dos ollas a las que daba servicio el mismo depresor.
En el 1991 instalan una sala de 4 puntos en la que ordeñan 14 vacas que en poco tiempo se convirtieron en 28. En el 1996 cambian de cama caliente a








tación de 25 Ha en las que cultivan raygras, maíz y avena con los que cubren parte de la alimentación de sus animales.
A día de hoy todo el trabajo, incluido la gestión de la distribución de la leche, lo realizan entre los tres, dos de ellos trabajando a tiempo completo y otro ocupándose de las labores administrativas.
Los animales en lactación están recibiendo una ración de 20 kg de maíz, 4 kg de alfalfa y heno en rama, 9 kg de pienso en forma de harina, 9 kg de silo de primavera de raygras (segundo corte) y 57 kg de melaza para todo el rebaño en producción. La melaza es suministrada a través de un Titania, equipamiento complementario del




Astronaut A4 que permite automatizar el punteo de estos productos en el comedero del robot, eliminando así otra tarea más de la rutina del ganadero.
Fue en el 2012 cuando la explotación Parnau-Barcons decide que ha llegado el momento de automatizar el ordeño. Querían que la instalación de un robot Lely fuera el colofón de una serie de cambios en la granja que tenían como objetivo ordeñar más vacas sin necesidad de aumentar la mano de obra de forma que la calidad de vida de los ganaderos mejorase por la mayor flexibilidad de horarios que esperaban, el robot Lely, les iba a dar y la disminución de horas dedicadas al ordeño respecto a la sala de ordeño. Según nos explica Miquel “olvidarnos del ordeño en el foso también fue uno de los motivos para comprar un robot Lely”
Así pues, hace ya casi un año que un robot Astronaut A4 funciona en la granja ordeñando unas 60 vacas de un total de 126 animales entre terneras, novillas, secas y vacas en lactación. Ha sido instalado en una nave nueva con 3 líneas de cubículos, cama de arena sobre neumáticos y paja encima y con capacidad para 70 animales. El resultado ha superado las expectativas de la familia y no sólo en lo que a aumento de producción se refiere:
“Ha sido un cambio radical. Al ajustar la alimentación con el pienso que se suministra en el robot se controla muy bien el balance energético negativo posparto de forma que las vacas no pierden casi peso, algo que en la sala de ordeño no llegábamos a controlar tan bien”.
La detección de celos, que es donde la producción de leche empieza realmente, se hace en este caso con los collares LELY que proporcionan “una
plotación es que siempre se ha cuidado la genética de las vacas lo que les llevó en el año 2011 a alcanzar la novena posición de mejor explotación española por ICO con un índice de +1946 en la categoría de ganaderías de 17 a 75 reproductoras. No es de extrañar que una de las razones para la compra de un robot Lely fuera precisamente “sacarle partido a la genética de nuestras vacas ordeñándolas tres veces”. El objetivo se ha








con dos ordeños. Miquel añade “los primeros 30 días hay vacas que se ordeñan hasta 5 veces”.
Conviene señalar que una de las diferencias entre el robot Lely y una sala de ordeño en la que se hacen tres ordeños es que en el Astronaut una media de tres ordeños por vaca significa que hay vacas que se ordeñan 5 veces mientras que otras se ordeñarán sólo dos. Esto evita el sobre ordeño que se puede dar en una sala cuando se ordeña tres veces a una vaca que está a punto de secarse y, de la misma manera, se permite que una vaca muy productora, en pico de lactación, se ordeñe más de tres veces. Esto redunda en una mejor salud de


la ubre, menos mamitis y por tanto más dinero en el bolsillo del ganadero.
RUTINA DIARIA
La jornada empieza con la consulta en el ordenador de los retrasos (vacas que hace más de 12 horas que no entran en el robot), las mamitis y los celos. El programa de gestión del rebaño, el T4C, permite a través de un sencillo sistema de alarmas centrarse sólo en aquellas vacas que lo necesitan. Después de comprobados estos datos en el ordenador, Miquel o su hijo, empujan las vacas con retraso a un área situada justo antes del robot donde si las vacas quieren salir deberán pasar por el robot.
Luego toca hacer el unifeed y ocuparse de las terneras. “Calculo que el trabajo ligado al robot nos lleva cada día en torno a 1 hora. Antes en la sala entre ordeñar dos veces y limpiar la zona de espera no estábamos menos de 5 horas al día en total”.
Por último preguntamos a Miquel cual fue la característica que más le llamó la atención del Astronaut A4 respecto a los robots de la competencia que vio antes de tomar la decisión de comprar: “no fue sólo una cosa lo que me llevó a elegir pero si tuviera que destacar una me quedo con la rapidez de conexión. De todas las mar-
cas que vi ninguna conecta tan rápido las pezoneras como el robot Lely. Además que la vaca pueda entrar y salir en línea recta del robot, sin tener que hacer ningún giro, me pareció que era una de las formas más sencillas de solucionar la forma en la que la vaca accede al robot”.
Ordeño más rápido y entrada y salida más rápida de la vaca, estas son dos de las señas de identidad del Astronaut A4.
La rapidez en la conexión se consigue gracias a la tecnología láser de detección de pezones y a que el brazo del robot tiene incorporadas las cuatro pezoneras y no tiene que ir a “buscarlas” cada vez que conecta una de ellas. Con un solo movimiento nuestro robot se coloca lo más cerca posible de la ubre y empieza la conexión, no sin antes limpiar los pezones. Para dar más seguridad a todo el proceso los tubos de leche están protegidos en el interior del brazo, sin que las vacas puedan acceder a ellos, impidiendo que el ordeño se vea interrumpido por pisotones o coces del animal. Si no fuera así, cada vez que una vaca pisara un tubo se interrumpiría el ordeño e incluso la pezonera acabaría en el suelo aspirando suciedad que iría directa al tanque.



El próximo 23 de octubre de 2013 se va a celebrar una nueva jornada de puertas abiertas en la GANADERÍA PARNAU-BARCONS situada en Fonolleres- Parlavà (Girona)
Equipamiento: 1 robot Astronaut A4




A continuación aparecen las vacas que han obtenido el título de VACA MEDALLA DE ORO en la evaluación de junio de 2013. Este título se concederá a las vacas que hayan conseguido tres estrellas o más, bien sea del aporte de datos de hijas
nacidas de partos naturales o de trasplante de embriones.
Las vacas vivas en ese momento aparecen resaltadas en negrita.

ESPH0802220604
A continuación aparecen las vacas que han obtenido el título de VACA ESTRELLA o que han aumentado su número de estrellas en la evaluación de junio de 2013
VACA ESTRELLA es aquella cuyas hijas cumplen con los requisitos que se exigen en producción, tipo y longevidad con los que sumarán méritos a los datos obtenidos por la madre. Obviamente, la madre y VACA ESTRELLA en cuestión también con
las exigencias que se piden a sus hijas.
Los animales con título de VACA ESTRELLA por hijas nacidas por parto de la madre llevan el indicativo VE tras el número de estrellas. En el caso de VACA ESTRELLA por hijas procedentes de trasplante de embriones, el distintivo es VEE. Las vacas vivas en ese momento aparecen resaltadas en negrita. (Ver requisitos en www. conafe.com)
ESPH3102170676



Durante 2012 la situación económica en nuestro país ha provocado unos ajustes presupuestarios tanto nacionales, como autonómicos y locales que han afectado a todos los ámbitos de la sociedad y de los que la ganadería tampoco ha escapado.
Los ganaderos siguen luchando por el reconocimiento del verdadero valor que su producto tiene y la administración central y algunas autonómicas, han tratado de hacer ver, tanto a industria como a distribución, que hay que proteger al eslabón más débil de la cadena mediante la creación de diversos grupos de discusión o firmando acuerdos cuyos resultados aún no han llegado.
En lo que a CONAFE, se refiere el descenso de la subvención procedente del Ministerio de Agricultura, Alimentación y Medio Ambiente (MAGRAMA) fue de un 14,5% con respecto al año anterior. Sin embargo, el anuncio de la cantidad máxima a percibir en 2013 ha obligado a CONAFE a reducir costes de personal de manera drástica para poder afrontar el siguiente año, asumiendo que habrá que realizar mayores esfuerzos, tanto de búsqueda de ingresos como de reducción de gastos.
En cuanto a la estructura del Libro Genealógico de CONAFE, en el año 2012 no ha habido cambios importantes. Los números que la gestión del Libro Genealógico arroja son los de una reducción del número de ganaderías y en los registros de auxiliar e importadas y un mantenimiento del registro principal.
En cambio ha sido un año intenso en cuanto a la puesta en marcha del Servicio de Evaluación Genómica. El acuerdo firmado con EuroGenomics en septiembre de 2011, ha permitido añadir unos 18.000 toros a los 1.800 de referencia disponibles, gracias a la aportación del MAGRAMA, con la que estimar unas ecuaciones de predicción fiables en colaboración con el INIA. En noviembre de 2012 se publicó la primera Evaluación Genómica de CONAFE, la cual sitúa a nuestra raza al mismo nivel técnico que los países de nuestro entorno.
El servicio de Evaluación Genómica permitirá a nuestros ganaderos disponer de una herramienta de selección adicional para poder detectar las hembras de una mayor valor genético a una edad más temprana y a los centros de inseminación españoles, los machos candidatos a ser futuros sementales, cuando son terneros recién nacidos, y por tanto, a reducir el intervalo generacional ostensiblemente.
Finalmente, queremos reconocer que para todas las actividades desarrolladas se ha contado con la participación y colaboración de las Asociaciones/Federaciones integradas en CONAFE y con las ayudas de las Administraciones, Central y Autonómicas, sin olvidarnos de la mejor disposición que con CONAFE han tenido otros organismos y empresas ligadas de alguna forma con la mejora y selección de la raza frisona. A todos el más sincero agradecimiento.
Desde el año 2009 el Real Decreto 2129/2008, de 26 de diciembre, por el que se establece el Programa Nacional de Conservación y Mejora de las Razas Ganaderas, constituye la base legal del Libro Genealógico y de las actividades que su desarrollo conlleva. Nuestro actual Reglamento del Libro Genealógico, para adaptarse a las exigencias del Real Decreto, ha sido objeto de modificaciones que recogen los avances que hay que introducir para el mejor desarrollo de la actividad ganadera de selección y ha sido aprobado por Resolución de la Dirección General de Recursos Agrícolas y Ganaderos el 27 de junio de 2011.
Estas reglamentaciones, se complementan con las normas y directrices que emanan de los órganos de gobierno de CONAFE, autorizada legalmente para la gestión y desarrollo del Reglamento del Libro Genealógico de la Raza.
El Libro Genealógico es pilar básico e imprescindible para desarrollar cualquier programa de mejora y de selección de la raza, y en él se inscribe y se mantiene toda la información relacionada con genealogías, calificaciones morfológicas, producciones, índices de mejora, filiaciones genéticas, consanguinidad, premios, méritos y otros, con el fin de que toda esta información esté integrada en una base de datos única, lo que constituye la referencia integradora más amplia de cualquier proceso informático para el desarrollo de la raza frisona
La información de las genealogías se viene informatizando desde el año 1979 a la base de datos del Libro Genealógico. Desde el año citado, también se vienen incorporando a esta misma base de datos la calificación morfológica, las producciones y otros datos relativos a la actividad productiva individual de los animales de raza frisona de las explotaciones incluidas en el Libro Genealógico. La información del Libro Genealógico, anterior a esa fecha, se encuentra en poder de CONAFE, en los documentos que en cada provin-

cia se habilitaron para la llevanza del Libro Genealógico.
En diciembre de 2012, el número de animales inscritos y vivos en el Libro Genealógico era de 757.228 (Cuadro 1).
Registros Genealógicos
El Registro de animales es una de las actividades de la gestión del Libro Genealógico, cuyo servicio se presta a los ganaderos bien directamente por CONAFE, o bien a través de las Asociaciones/Federaciones integradas en la Confederación tales como: AFA (Andalucía); AFB (Baleares); AFCA (Cantabria); AFNA (Navarra); AFRICAMA (CastillaLa Mancha); ASCOLAF (Asturias); EFRIFE (País Vasco); FEFRIC (Cataluña), FEFRICALE (Castilla y León) y FEFRIGA (Galicia).
Los registros en el Libro Genealógico de la Raza Frisona Española se dividen en dos secciones: Auxiliar (RA) y Principal (RP).
Registros en el año 2012
Cuadro 2. Registros del año 2012 por CC.AA.

La inscripción en el año 2012 (Cuadro 2) ha sido de un total de 168.759 animales, lo que supone 3.004 animales mes (1,75%) que en 2011. En concreto disminuyen 2.250 animales en el Registro Auxiliar “A”; 1.137 en el Auxiliar “B”; y 2.210 en el de Importadas. Sin embargo, aumenta en 188 la inscripción en el Registro de Machos y en 2.405 animales en el Registro Principal de Hembras
a) Sección Auxiliar
En el Registro Auxiliar se inscriben las hembras que, poseyendo las características étnicas de la raza, carecen total o parcialmente de documentación genealógica que acredite su ascendencia o incumplen la normativa de la gestión del Libro.
El Registro Auxiliar se clasifica en: Registro Auxiliar A y Registro Auxiliar B.
El número total de animales registrados en el Registro Auxiliar a final del año ha sido de 24.112 animales, de los que 12.513 (51,90%) son de Registro Auxiliar “A” y 11.599 (48,10%) son de Registro Auxiliar “B”. Ambos representan el 14,28% de todos los animales registrados en el año 2012 en el Libro Genealógico.
Con respecto al año anterior se han registrado
3.387 animales menos en el Registro Auxiliar, lo que representa un decremento del 13%.
b) Sección Principal
La sección Principal del Libro Genealógico se subdivide en varios registros: Principal, Importadas, Toros y Méritos.
1. Registro Principal. En él se inscriben las hembras que provienen de padres y abuelos inscritos en el mismo registro. El registro ha sido ligeramente superior al del año anterior. En el ejercicio de 2012 se han registrado 137.776 hembras. Galicia, con 55.370 animales (el 40,18%), ha sido la comunidad que más registros ha tenido, seguida por Castilla y León con 13.935, Cataluña con 13.784, Asturias con 12.477 y Cantabria con 11.999.
2. Importadas. Se registran las hembras procedentes de la UE y terceros países. En 2012 se ha producido un decremento en la inscripción de 2.210 animales frente a 2011.
3. Toros. Se inscriben en este registro los toros que provienen de otros Libros Genealógicos y los nacidos de padres y madres del Registro Princi-
pal. En el 2012 se han registrado 1.047 machos, lo que representa un aumento sobre el año anterior de 188 toros, debido a la incorporación de toros genómicos.
4. Méritos. Los animales inscritos en el registro de méritos son animales incluidos en la sección Principal del Libro Genealógico. Se subdivide en registro de hembras y machos. El Reglamento del Libro especifica los requisitos que deben cumplir los animales para inscribirse en este registro, en sus diversas clasificaciones.
Toros padres de animales registrados en 2012
De las 150.415 hembras registradas en 2012, 73.509 son hijas de toros nacionales (35.554 con prueba y 37.955 sin prueba) y 76.906 son hijas de toros extranjeros (72.048 con prueba y 4.858 sin prueba). Se consideran toros extranjeros con prueba aquellos que tienen prueba en el Catálogo Oficial de CONAFE, o están evaluados por Interbull, tomando como año de referencia el año de las inscripciones de sus hijas. Los toros extranjeros sin prueba, son los que no tienen prueba oficial en CONAFE, y no han sido enviados por CONAFE a la Evaluación MACE de Interbull.
El Cuadro 3 recoge la evolución del Libro en los últimos cinco años, tanto en ganaderías y re-



productoras como en datos de registro y calificación. Como se puede observar, se mantiene la tendencia de menor número de ganadería y mayor número de vacas por explotación.
Fiabilidad del Libro
• Pruebas de Filiación
Las pruebas de filiación se realizan mediante la determinación de 17 loci (en algunos casos hasta 30), todos ellos normalizados y homologados por la Sociedad Internacional de Genética Animal (ISAG).
El documento “Normas sobre pruebas de filiación”, en el que se recogen: Técnicas, Responsabilidad de Ejecución, Laboratorio y Marcadores, Dirección y Organización, Metodología de muestreo, Ejecución en Campo y Análisis, Valoración de Resultados y los protocolos para la realización del muestreo aleatorio y dirigido. La obligación de aportar pruebas de filiación también viene reflejada en el documento “Norma sobre requisitos complementarios”, para los casos de machos a registrar y productos de trasferencia embrionaria.
El objetivo de esta norma es conocer la fiabilidad de las genealogías del Libro Genealógico y detectar fallos o posibles fraudes en el Libro Genealógico.
La extracción de muestras es responsabilidad de cada Asociación Autonómica, cuyo coste es abonado por CONAFE
• Huellas Genéticas por ADN
En 2012 la Junta de Gobierno aprobó la realización de 2.000 muestras, entre aleatorias y dirigidas. La distribución de los análisis se ha llevado a cabo por CC.AA., de forma proporcional respecto a número de registros y reproductoras. Se han realizado 1.800 muestras y los resultados del muestreo aleatorio han sido de un 5,13% de negatividad.
En 2012 la ronda de calificación comenzó en junio y ha terminado en marzo de 2013, con 10 meses de intervalo.
En el año 2012 se han visitado 8.485 explotaciones en las que se han calificado 140.705 animales,





mentado ligeramente este año, siendo de nuevo Lugo la provincia que más peticiones solicita y donde más vacas se han calificado. Cantabria y Gerona se suman este año a este servicio de Calificación especialmente valorado por ganaderos que trabajan en la formación de familias de vacas y pedigrís profundos. Se han hecho 11 peticiones de parte individual, con 197 animales, y 68 ganaderías en ronda colectiva, con 682 animales. En el trascurso del año se han mantenido las dos reuniones habituales de unificación de criterios de la calificación morfológica, con la participación de los técnicos calificadores y los del Dpto. de Genética. La primera tuvo lugar en junio en las ganaderías pontevedresas Pereira y Kinteiro; la segunda se celebró en diciembre en las ganaderías SAT Teserna y El Canton, S.C., de Cantabria.
CONAFE es la organización responsable de la gestión de la Base de datos nacional de Control Lechero de la raza frisona, según lo establecido en el Real Decreto 368/2005, de 8 de abril, por el que se regula el Control Lechero Oficial del Rendimiento Lechero para la Evaluación Genética en las especies bovina, ovina y caprina. En este sentido, a lo largo del 2012 se han realizado, entre otros, los siguientes trabajos en cuanto a la gestión y mantenimiento de la Base de Datos nacional de Control Lechero:


- Solicitar, recibir e integrar en la base de datos los ficheros bimestrales de lactaciones y controles mensuales procedentes de las distintas CC.AA, con el fin de actualizar la Base de datos nacional. Seguimiento de los errores detectados en los ficheros de lactaciones y controles recibidos cada dos meses, comunicación de los mismos a las organizaciones de origen y corrección de datos.
- Solicitar, recibir e integrar en la base de datos los datos de facilidad de parto, velocidad de ordeño e inseminaciones, que se reciben cada dos meses.
- Extracción de la base de datos de la información para la certificación de lactaciones de aquellas CC.AA. que se lo solicitan.
- Mejoras en la metodología y procesos de incorporación de la información.
- Recepción de nuevos archivos históricos de Control Lechero de algunas autonomías, que se contrastaron con el archivo histórico actual de CONAFE, con el fin de recuperar lactaciones pendientes de corrección.
- Carga de actualizaciones de datos de raza churra y murciano-granadina en colec.org.
- Establecimiento de un protocolo de devolución a origen y corrección de errores de inseminaciones, facilidad de parto y velocidad de ordeño.
En cuanto a la aplicación informatizada de gestión de Control Lechero y Libro Genealógico
de CONAFE (GESLIB), se han realizado las siguientes tareas en 2012:
- Creación de especificaciones para el nuevo sistema de toma de datos en campo de Control Lechero (DATCOL).
- Creación de un nuevo sistema de revisión de lactaciones.
- Cambios en formularios de Control Lechero en campo.
Cuadro 5. Evolución fenotípica en España.

Estructura del Control Lechero
El número de controladores en 2012 ha sido de 250 (8 menos que el año anterior), lo que supone una media de 30 ganaderías y 1.993 reproductoras por controlador.
Las reproductoras son consideradas como tales a partir de 24 meses, que están en C.L. aunque no tengan lactación alguna.
Recordamos que todas las reproductoras están obligadas a estar en C.L., así como todas las ganaderías del L.G.
Producciones del Control Lechero
La evolución fenotípica den España en los últimos cinco años (periodos de enero a diciembre) considerando el número total de lactaciones naturales se muestra en el Cuadro 5. El resumen de las lactaciones terminadas y válidas en el período de enero a diciembre de 2012 está detallado en el Cuadro 6.
Cuadro 6. Resumen de las lactaciones terminadas y válidas en el período de enero a diciembre de 2012.

Evaluaciones genéticas nacionales
En el Cuadro 7 se muestra el número lactaciones y calificaciones utilizadas en las evaluaciones genéticas de Junio 11 y Junio 12 y la variación de una evaluación a otra.
En cuanto al número de vacas vivas evaluadas y con índice genético para los caracteres de producción, tipo y recuento de células somáticas en las evaluaciones de junio 2011 y junio 2012, aparece en el Cuadro 8.
Cuadro 7. Lactaciones y calificaciones utilizadas en las evaluaciones genéticas

Cuadro 8. Vacas vivas

Evaluaciones internacionales
Las pruebas de los toros resultantes de la evaluación genética nacional se han integrado en las evaluaciones genéticas internacionales oficiales que ha realizado Interbull en 2012 para producción, conformación, recuento de células somáticas y longevidad.
En el Cuadro 9 se muestran las correlaciones genéticas utilizadas por Interbull en agosto de 2012 entre España y los principales países exporta-
dores de semen para los cuatro grupos de caracteres considerados: kg de proteína, recuento de células somáticas (RCS), longevidad funcional y Días abiertos (DA).
Cuadro 9. Correlaciones genéticas de España y los principales países exportadores de semen para los caracteres de kg proteína, RCS, longevidad funcional y D.A.

Se aprecia que hay un alto grado de semejanza entre las pruebas de los distintos países, incluido España. Las correlaciones entre países para los caracteres de tipo son incluso superiores a las de producción.
En el carácter longevidad las correlaciones son, en general, más bajas que en otros caracteres y son menores entre los países europeos. La razón parece estar en que es un carácter que resume muchos otros caracteres y que en realidad la longevidad de las vacas está muy ligada al tipo de explotaciones y manejo existente en cada país.
Las correlaciones para los caracteres de conformación se recogen en el Cuadro 10 (siguiente página).
Las pruebas MACE de INTERBULL en la base y escala española son oficiales en nuestro país para aquellos toros extranjeros sin prueba en el Catálogo de Sementales de CONAFE.
Evaluaciones genómicas
Se ha colaborado con los laboratorios españoles en el registro de información de los animales a genotipar y en establecer los criterios al respecto,

Cuadro 10. Correlaciones genéticas de España y los principales países exportadores de semen para los 18 caracteres de tipo evaluados por Interbull (agosto’12)

así como en la recepción y gestión de los ficheros de SNPs por parte de los mismos.
En cuanto a la colaboración con entidaddes internacionales, en particular con EuroGenomics, se ha analizado la posibilidad de un laboratorio común en este consorcio. También se han realizado intercambios de genotipos y genealogías de toros probados entre los países de EuroGenomics; se han analizado formatos para intercambio con terceros países (Estados Unidos, Canadá, Hungría) y también de algunos toros de países de EuroGenomics no incluidos en los acuerdos.
CONAFE ha participado en las reuniones de la mesa de acuerdos entre los programas de testaje de los centros de IA españoles para la discusión en su seno de las propuestas presentadas por el INIA en materia de Selección Genómica.
Con el INIA se ha colaborado en la puesta en marcha de las evaluaciones genómicas, entre otros trabajos, en:
− Preparación de ficheros de SNPs según formatos solicitados por el INIA.
Publicación de las primeras evaluaciones genómicas nacionales
El 30 de noviembre de 2012, se publicaron las primeras valoraciones genómicas nacionales.
Participación o colaboración en otros proyectos de investigación
Además de la colaboración para la puesta en marcha de las evaluaciones genómicas rutinarias con el INIA, se ha trabajado en buscar acuerdos de colaboración en otros temas de interés para el sector de la mejora genética del vacuno Holstein, tanto a nivel nacional como internacional, como:
− Proyecto sobre monitorización de la variabilidad genética. Coordinadora Beatriz Villanueva (INIA).
− Tesis Doctoral sobre estudio de valoraciones genómicas sobre caracteres experimentales de fertilidad de los machos.
− Proyecto Heat stress.
− Estudio de las imágenes obtenidas al realizar los genotipos de 50K.
− Estudios de imputación.
− Secuenciación de 10 toros españoles.
− EPICONCEPT.
− Feed intake international DGV project.
Cambios en las evaluaciones internacionales calculadas por INTERBULL
En abril 2012, INTERBULL introdujo cambios en la forma de calcular las evaluaciones internacionales y en los formatos de información suministrada. Esto ha supuesto adaptar los programas utilizados en los procedimientos que procesan esta información así como los que preparan las pruebas derregresadas, necesarias estas para la estimación de las ecuaciones de predicción de los valores genómicos directos.
El cambio en las evaluación de INTERBULL consiste en que aunque se sigue utilizando el método MACE, se utiliza ahora la genealogía de padre y madre de los toros, en vez de una genealogía sólo de ancestros machos, como se hacía hasta la fecha. La razón por la que se utilizaba una genealogía sólo de ancestros machos era el alto coste computacional de utilizar la genealogía de padre y madre, debido a la gran cantidad de madres de toro que se añaden.
− Preparación de las pruebas derregresadas correspondientes varias evaluaciones MACE de 2011 y 2012, así como las correspondientes a la
− Una vez incorporados los genotipos de EuroGenomics, la población de referencia usada para enero de 2009 fue de unos 18.000 toros y

En marzo el INIA transfirió a CONAFE las ecuaciones de predicción y se comenzaron a calcular valoraciones genómicas mensuales para entregar a los centros una fase preliminar.
Nuevos caracteres de salud podal
Se ha organizado un sistema de recogida de información sobre caracteres que describen la salud podal (I-SAP) a nivel de todo el país en colaboración con ANKAPODOL, S.L. Asimismo, se ha colaborado con el departamento de Tecnología, Informática y Comunicación de CONAFE para desarrollar una aplicación informática propia llamada DATPAT para recoger de forma sencilla la información en el campo sobre 6 caracteres. Asimismo, se está trabajando para diseñar un servicio web para generar informes on-line que comparan a través de gráficas y estadísticas las incidencias de las lesiones registradas en la última visita del podólogo con los datos históricos tanto a nivel del conjunto total de la ganadería como a nivel de cada animal. Además, sitúan las incidencias observadas en la ganadería, comparándolas con las medias a nivel autonómico y nacional.
Al mismo tiempo, se ha firmado un proyecto de colaboración e intercambio de información con SERAGRO, S.C. GALEGA, para poder disponer de la información de salud podal recogida por sus técnicos en las ganaderías que son a la vez socios
de SERAGRO y CONAFE.
Se ha analizado los datos recogidos en los primeros 3 meses, para validar el proceso de recogida de información y pasar de la fase de prueba a la fase de recogida definitiva.
cación de criterios entre podólogos en el marco del programa I-SAP en Gijón, en la cual asistieron 24 podólogos procedentes de varias comunidades autónomas.
Estudio sobre mamitis
Dentro de la colaboración establecida con la Facultad de Veterinaria de la UCM de Madrid para estudiar la incorporación de la información disponible de mamitis en las evaluaciones genéticas de CONAFE, se ha realizado la preparación preliminar de ficheros para el estudio. Se trabaja con los datos que dispone esta Facultad sobre mamitis en algunas explotaciones de País Vasco y Gerona.
PROMOCIÓN


33º Concurso Nacional de Otoño. Gijón
El Nacional de otoño se celebró del 27 al 30 de septiembre en Gijón, coincidiendo como es habitual con la celebración de Agropec. En esta edición participaron 53 ganaderías con 143 animales (ver tabla).
Se encargó del juzgamiento Francisco Javier Freije, Juez Nacional de CONAFE, quien eligió como Vaca Gran Campeona a Espinal Goldwyn Patricia, de las ganaderías La Flor, Ponderosa Holsteins y la italiana Albero. Patricia, que había sido nombrada Intermedia Campeona, se impuso a Mijaqui Dorita Jasper, de Cal Marquet, nombrada Joven Campeona y Gran Campeona Nacional Reserva.





El título de Gran Campeona Nacional de Novillas fue para Celis Chanel Wildman, de la ganadería Hnos. Celis Gutiérrez, que había sido elegida también Novilla Campeona.



Grupo de participantes en el Campeonato de Manejadores CONAFE 2012
La Ganadería Diplomada Badiola, de Asturias, fue nombrada Mejor Rebaño y Mejor Criador. Por su parte, Cal Marquet (Lleida) fue nombrada Segundo Rebaño y Segundo Criador.
Por primera vez, los títulos de Mejor Autonomía se otorgaron en función a los puntos obtenidos en las secciones individuales. En 2012, Asturias, con 88 puntos, obtuvo el título de Mejor Autonomía y Cantabria, con 84 puntos, el de Segunda Autonomía.
Fueron nombrados mejores manejadores del certamen, por este orden, Alberto Llera, Jaume Serrabassa y Germán Fernández.
XI Campeonato Nacional de Manejadores
Esta edición del Campeonato de Manejadores contó con la asistencia de 25 participantes repartidos en las tres categorías.
En la sección infantil, Javier Álvarez (Juez Nacional de CONAFE), estableció el siguiente orden entre los cuatro participantes: Miguel Rodríguez Madueño, Pau Sabrià, Adrián Rodríguez y Raúl Rodríguez. En la sección juvenil, juzgada por Mathia Mota (Italia), Cristina Carro fue elegida Campeona y Guillermo Orfila, Subcampeón.
Finalmente, en la categoría de adultos, juzgada por Bonet Cid (Juez Nacional de CONAFE), Alberto Llera fue nombrado Campeón y Germán Fernández, Subcampeón.
Otras actividades
Como es habitual en las ediciones de otoño, se entregaron los diplomas a las vacas premiadas entre las mejores de la evaluación genética de CONAFE de junio 2012. En esta ocasión correspondieron a animales de las ganaderías: S.A.T. A Campa; Sdad. Coop. El Pandio; Casa Caneda; S.A.T. Gutiérrez nº 647; L’Homet; Sdad. Anónima del Ucieza; Xirelo; Gan. Diplomada Badiola, S.L.; Gayere C.B.; Granja San José S.A.; Fisure Portillo C.B.; S.A.T. Algabrusan; S.A.T. Casa Carballo 1023 Xuga; Ganadería Blanco S.L. y S.C. Kattaburu.
Jornada Técnica CONAFE 2012
CONAFE organizó, coincidiendo con la celebración del Nacional, unas jornadas técnicas para dar a conocer los programas en los que está trabajando. Las jornadas, que se desarrollaron el viernes 28 y sábado 29 de septiembre, incluyeron presentaciones sobre el programa de acoplamientos de CONAFE –Conafemat–, el de Información sobre Salud Podal –I-SAP– y el servicio de valoración genómica. Para ello CONAFE contó con la participación de los técnicos que están trabajando en estas áreas.
La primera tarde de las jornadas, Xabier Aba-
solo, Secretario Ejecutivo de la Asociación Frisona de Navarra, se encargó de presentar el programa de acoplamientos creado por José Luis Tejeda, jefe del Dpto. de Tecnología, Informática y Comunicación de CONAFE. Como explicó Abasolo, la finalidad del programa Conafemat es facilitar al ganadero la elección de los toros más adecuados para sus objetivos de selección.
Para hablar sobre el Programa I-SAP intervinieron varios ponentes, comenzando por Noureddine Charfeddine, del Dpto. Técnico de CONAFE, quien presentó el programa de recogida de Información sobre Salud Podal (I-SAP), un sistema de recogida de información sobre caracteres que describen la salud podal a nivel de todo el país en colaboración con varias empresas de podología que prestan servicios de cuidado y recortes de pezuñas en muchas ganaderías socias de CONAFE. Asimismo, Jose Luis Tejeda presentó la aplicación informática desarrollada en CONAFE llamada DATPAT –que permite recoger de forma sencilla la información en el campo– y el servicio web que se va poner en marcha para generar informes on-line que comparan, a través de gráficas y estadísticas, las incidencias de las lesiones registradas en la última visita del podólogo con los datos históricos tanto a nivel del conjunto total de la ganadería como a nivel de cada animal. Además, sitúan las incidencias observadas en la ganadería, comparándolas con las medias a nivel autonómico y nacional.
Pedro Codesido, de Seragro, S.C. Galega, empresa colaboradora con CONAFE en el programa I-SAP, habló sobre la prevención en podología bovina.
Adrián González Sagüés, de la empresa ANKA, colaboradora también con CONAFE en este programa, habló sobre las cojeras en tiempos de crisis, cuando es imprescindible optimizar costes.
Por último, la Directora Gerente de CONAFE, Sofía Alday, expuso brevemente a los asistentes el nuevo servicio de valoración genómica de hembras.
Del 27 al 29 de marzo se celebró en el Valle de los Pedroches (Córdoba) la 37ª edición de la Escuela de Jueces, con 103 participantes. Se contó con la colaboración de quince ganaderías (aunque se visitaron once) que prestaron sus animales e instalaciones para el desarrollo de esta actividad. El juez fue Francisco Javier Freije.
Ganaderías colaboradoras: Guadarramilla, Pocito Calero, Cruz Dorada, Raya Dehesa, Granja


Came, Explot. María del Carmen, Dehesa Valbuena, Dehesa Riscal, López Lunar, Huerta Los Tobías, Ciguñuela, Las Rozuelas del Valle, Huerta El Coronel, S.C. Alegría y El Cruce.
Reciclaje de Jueces
El 27 de abril de 2012 tuvo lugar la reunión anual del panel de jueces de CONAFE, jornada que se dedica a la armonización y actualización de criterios en el juzgamiento de los animales en la pista de un concurso.
La ganadería La Flor, de Cantabria, fue el escenario de esta reunión donde se juzgaron 25 animales con los que los participantes pudieron discutir colocaciones, razonamientos y alcanzar consensos.
7ª Escuela de Preparadores
El IES de Luces (Asturias), acogió la séptima edición de la Escuela de Preparadores que se celebró del 25 al 29 de junio. Asistieron dieciocho participantes que se distribuyeron en cuatro equipos. Al finalizar la Escuela se eligió como mejor equipo, por la preparación y mantenimiento de sus animales y del stand, el “Amistad”, seguido por “El Recio”. En el Campeonato de Manejadores alcanzaron las tres primeras posiciones, por este orden, Coloma Mascaró, María Mantenga y Cristina Carro.
En esta edición, los monitores de la Escuela fueron Javier Álvarez, Bonet Cid y Jaume Serrabassa; la dirección de la misma estuvo a cargo de Gabriel Blanco, Jefe del Dpto. de Morfología de CONAFE, quien contó con la colaboración de los técnicos calificadores Juan Manuel Fernández y Santiago Mato.
Se contó con el apoyo económico de Central Lechera Asturiana, ASA y el Servicio de Podología Pura, cuyo representante, Ángel Fernández, dio unas clases prácticas de arreglo podal. Como en ediciones anteriores, Juan Prado y Ángel Amandi, del IES de Luces, prestaron su desinteresada colaboración.
Jueces de CONAFE en activo
En el cuadro a pie de página se relacionan los Jueces Activos, aunque algunos de ellos no han juzgado ningún evento en 2012




OTRAS ACTIVIDADES
Internas
Comités y Subcomités en los que participa CONAFE
Además de todas las actividades específicas que se resumen en el transcurso de esta memoria,
Jueces de CONAFE en activo
Alvarez Lastra, Javier Cid Salgado, Bonet Juanola Codina, Jordi Saiz Rio, Luis Arronte Diego, Jose Ramon Freije Freije, Francisco Javier Medina Menendez, Jose Manuel Saiz Rio, Roberto Badiola Fernandez, Paulino Garcia Souto, Santiago Paz Conde, Jose Manuel Sanchez Caso, Vicente Badiola Garcia, Jose Ramon Gonzalez Anton, Conrado Sabria Pujol, Joaquin Serrabasa Vila, Jaime
Participantes de la Escuela de Jueces celebrada en el Valle de los Pedroches Alumnos, profesores y organizadores de la 7ª Escuela de Preparadores El panel de jueces de CONAFE durante su reunión en la ganadería La Flor (Cantabria)CONAFE está presente en todas aquellas actividades propias del desarrollo del Libro Genealógico. También interviene en foros cuyo objeto es el desarrollo, promoción e intereses de la ganadería de leche. En 2012 CONAFE ha formado parte de los siguientes Comités Nacionales:
• Comisión Nacional de Control de Rendimiento Lechero.
• Comité de Secretarios de FEAGAS
• Comité Técnico de FEAGAS
• Mesa de Acuerdos, en la que participan los programas de testaje y CONAFE.
Externas
La presencia de CONAFE en el extranjero es cada día más asidua e importante. Durante el año 2012, CONAFE ha formado parte de los siguientes Comités y Subcomités; en los que han intervenido el personal de CONAFE especializado en cada tema:
• Comité Permanente de Secretarios Ejecutivos de la EHRC. Miembro del Comité Ejecutivo de Asociaciones Europeas. Reuniones trimestrales.
• Conferencia Mundial y Asamblea de la WHFF.
• Subcomité de Calificación y Juzgamiento de la EHRC. Miembro del Comité Ejecutivo.
• Comité Europeo de Jueces. Miembro del Comité Ejecutivo.
• Comité Mundial de Calificadores. Miembro del Comité Ejecutivo.
• Reuniones anuales de ICAR e Interbull.
Socios de CONAFE y representación en votos
A 31 de diciembre de 2012 permanecían 7.453 ganaderías dadas de Alta en el L.G. Esta cifra representa 376 ganaderías menos que en el año anterior. En cuanto a reproductoras, hay una disminución de 17.031 animales.
De acuerdo con los Estatutos vigentes de la Confederación, la distribución de votos de las Asociaciones/Federaciones que constituyen CONAFE es la que aparece en el Cuadro 11.
Cuadro 11. Socios de CONAFE y representación en votos





Cuadro 13. Composición de la Junta de Gobierno de Conafe Presidente








AFCA (Cantabria)
D. Germán de la Vega Delgado Vicepresidente
ASCOLAF (Asturias)
D. José Emilio García Suarez Secretario AFB (Baleares)







D. Jaime Olascoaga Enseñat Tesorero
FEFRICALE (Castilla y León)
D. Irineo Cuesta Modinos Interventor
FEFRIGA (Galicia)
D. José Carlos Vega Rodríguez Vocales
AFA (Andalucía)
D. José Luis Pereda Hondal
AFNA (Navarra)
D. Carlos Prat Castillejo
AFRIARA (Aragón)
D. Carlos Manuel Sánchez García
AFRICAMA (Castilla-La Mancha)
D. Alejandro Arasanz Balongo
AFRIDEMA (Madrid). D. Miguel González de Parla
EFRIFE (País Vasco)
D. Valentín Novales Elejalde
FEFRIC (Cataluña)
D. Agustí Prat Aguilar
Dtra. Gerente. Dª Sofía Alday Martínez de Cestafe




Se publican a continuación 200 las mejores explotaciones por Índice de Mérito Genético Total (ICO) de la evaluación genética de junio 2013, con las medias de los índices genéticoss de las vacas vivas en el período considerado.
Las características que debe de tener un rebaño para ser INCLUIDO en estos listados son:
1.El rebaño debe tener un mínimo 17 reproductoras.
2.Se exige un mínimo del 75% de animales valorados (con ICO), sobre reproductoras registradas de más de 36 meses, con el fin de obtener rebaños representativos.
3.No serán consideradas, ni publicadas, las ganaderías con más del 5% de reproductoras en el Registro Auxiliar categoría A, sobre el total del censo de reproductoras.
4.La referencia de reproductoras en granja serán las existentes a 15 de noviembre y al 14 de junio, para su respectiva evaluación.
5.Para la publicación de los rebaños se consideran los siguientes estratos:
- De 17 a 75 reproductoras
- De 76 a 200 reproductoras
- De más de 200 reproductoras







El nuevo listado de las mejores hembras con edad inferior a 18 meses, genotipadas hasta Julio 2013, está encabezado por la novilla S.M.ARALAR GERARD 2075. Un animal propiedad de la ganadería COOPERATIVA SAN MIGUEL de ARALAR situada en la Comunidad Foral de Navarra. Si examinamos su pedigrí vemos que proviene de una gran combinación de familias (GERARDxBOLTONxDUPLEX) y que su prueba genómica viene a confirmar una buena genealogía. Hija de GERARD, uno de los mejores hijos de OMAN y nieta de DUPLEX, son garantía suficiente para que nuestra mejor novilla sea transmisora de altos niveles de proteína y muy buena ubre, bien insertada y fuerte.
Como se puede observar en el cuadro 1, las 10 mejores hembras genotipadas son animales excepcionales con un GICO superior a 3000 puntos, situándose todas ellas en el percentil 99 de las vacas, correspondiente a la última evaluación. Todas ellas provienen de muy buenas familias y muy buena genealogía.
Un aspecto a destacar y que confirma que
estos animales son excepcionales, es el hecho de que los valores genómicos directos son más altos, que los índices de pedigrí, significa que cada una de estas hembras tiene en su genoma muy buena combinación de genes que le permite ser mejor que sus progenitores y la media de sus hermanos completos. El ejemplo más significativo es el de la ternera situada en segundo lugar FIGUEIRA EPIC SISI ET, que tiene un ICO genómico que supera en casi 1000 puntos su índice de Pedigrí. Este animal, es el típico animal que buscamos diagnosticar con las pruebas genómicas, animal excepcional, que supera netamente la información previamente pronosticada por sus pruebas de pedigrí, dado que ha heredado una combinación de genes que le hace muy superior a la media de sus hermanos completos.
De las 10 hembras que forman parte del nuevo listado, dos de ellas son hijas de toros jóvenes sin prueba de descendencia, llamados toros genómicos. El hecho de ver hijas de toros genómicos entre las diez mejores hembras genotipadas viene a confirmar una vez más la superioridad de la nueva genética transmitida por los toros genómicos. A pesar



Nombre
1 S.M.ARALAR GERARD 2075
Nombre Padre
Nombre Madre
SCHILLVIEW OMAN GERARD ET S.M.ARALAR BOLTON 10112
2 FIGUEIRA EPIC SISI ET GENERVATIONS EPIC ET SULLY PLANET MONTREAL ET
3 GENER HILL SHANEA 1148
4 COCHERO HILL HILTIA
LOTTA-HILL SHOTTLE 41 ET GENER O-MAN STAR 810 ET
LOTTA-HILL SHOTTLE 41 ET BOS COCHERO XACOBEO JESSICA ET
5 SOMALERA JENNY L DAKOTA ET ALH DAKOTA JENNY L PLANET
6 SAN-RIAN JERICHO HILL ET LOTTA-HILL SHOTTLE 41 ET BOS SAN-RIAN JERSEY XACOBEO ET
7 ULLOA LYDIA 405 ET BOS GOLDWYN GOSPELL ET BOS MAN OMAN PRECIOUS ET
8 MASEDA BOOKEM 355 ET DE-SU 521 BOOKEM ET VEKIS PHANTASTIC ET
9 NODI XF NUMERO UNO EDDA ET AMIGHETTI NUMERO UNO ET WILLSBRO PLANET GO SHO EDDA ET
10 GENER BEACON BIFLYER 1120 ET END-ROAD BEACON ET GE-GLEN-D-HAVEN BIFFY PLANE ET
de sus bajas fiabilidades, en media los toros genómicos acaban confirmando su alto potencial genético.
El potencial genómico por cromosoma de las diez mejores hembras que muestra el cuadro 2, nos ofrece una herramienta muy útil a la hora de dirigir los acoplamientos y buscar el toro perfecto, que se complementa con la composición génica de cada novilla. Nos permite corregir determinados defectos en determinados cromosomas. Se supone que un animal transmite a su descendencia una combinación media de SNPs por cromosoma, de la cual dibujamos su efecto sobre
Cuadro 2. ICO Genómico Directo total y por Cromosoma

1
2
3 GENER HILL SHANEA 1148
4 COCHERO HILL HILTIA 3639
5 SOMALERA JENNY L DAKOTA ET 3590
6 SAN-RIAN JERICHO HILL ET
7 ULLOA LYDIA 405 ET
8
9
cada carácter para cada animal en un pequeño gráfico de barras (Cuadros 3 y 4). Estas gráficas se deben usar para complementar la información dada por el valor genómico directo, para dirigir el acoplamiento hacia un acoplamiento más correctivo. El cuadro 3 dibuja el potencial genómico por cromosoma en varios caracteres de S.M.ARALAR GERARD 2075, la novilla con mayor índice combinado GICO en este listado. Es un animal excepcional en caracteres productivos, pero muestra valoración negativa en algunos caracteres de patas, días abiertos y recuento celular. Dichas valoraciones nos puede ayudar a la hora de buscar el toro perfecto para acoplar esta novilla. Lo ideal es buscar toros muy positivos en los cromosomas que muestran valoraciones negativas. En la web de CONAFE se publica la valoración genómica por cromosoma de los 50 mejores toros genómicos. Sería interesante consultar dicha información para acoplar este animal.
BOOKEM 355 ET

Asimismo, el cuadro 4, muestra la valoración genómica por cromosoma en varios caracteres de FIGUEIRA EPIC SISI ET, el animal con mayor valor genómico directo ICO. Un animal con una genética balanceada, prometiendo alta producción con buenos componentes, y una morfología funcional que harán de este animal muy rentable.



Se presentan los resultados del catálogo internacional de sementales de agosto 2013 para cuya elaboración se han utilizado las pruebas de CONAFE de junio’13 y las pruebas MACE de agosto’13 de producción, tipo, recuento de células somáticas, longevidad funcional y días abiertos, que son oficiales en España para los toros sin prueba en nuestro país para estos caracteres.
Las pruebas MACE son calculadas y distribuidas por INTERBULL para estimar cómo pueden compararse los toros de otros países sin prueba española con los toros que sí tienen prueba en España. Las pruebas MACE hacen posible esta comparación expresando la información de las pruebas de otros países en la escala del Catálogo de Sementales de CONAFE. Para calcular las evaluaciones internacionales, INTERBULL recibe las valoraciones de los toros en cada país y, mediante el método MACE, obtiene las pruebas de todos los toros en las escalas de cada uno de los países participantes.
Las listas de mejores toros se establecen según el ICO, que es el índice de mérito genético global oficial en CONAFE, y según requisitos de fiabilidad.

El resto de toros del catálogo internacional se puede consultar en la página web de CONAFE www.conafe.com.
En la columna de Tipo de Prueba, se indica con una “M” cuando es una prueba MACE, "I" = sólo indirecta y "F" = prueba faltante.

En longevidad, las pruebas de los toros sin prueba nacional se calculan combinando las pruebas MACE de longevidad y las pruebas MACE de miembros y aplomos, profundidad de ubre y RCS.

A continuación aparecen los primeros 400 toros mejoradores por ICO del listado internacional de sementales. Para elaborar este listado se han exigido los siguientes requisitos:
1. Estar dentro del percentil 90 por ICO en la última evaluación nacional realizada por CONAFE, es decir, su ICO es igual o superior al del mejor 10% de los toros probados en España.
2. Fiabilidad igual o superior al 80% en producción y tipo.
3. En tipo, el requisito de la fiabilidad se aplica sobre la fiabilidad máxima en alguno de los países participantes en las evaluaciones MACE.
Toros MEJORADORES ordenados por ICO. Pruebas CONAFE junio 2013 + MACE agosto 2013 Orden POM
A continuación se publica el segundo listado del catálogo internacional de sementales que recoge la relación de toros con baja fiabilidad dentro del percentil 99 por ICO y que cumplen los siguientes requisitos:
1. Estar dentro del percentil 99 de la última evaluación nacional realizada por CONAFE, es decir, su ICO es igual o superior al del mejor 1% de los toros probados en España.

2. Fiabilidad inferior al 80% en producción o tipo, pero superior al 70%.
3. En tipo, el requisito de la fiabilidad se aplica sobre la fiabilidad máxima en alguno de los países participantes en las evaluaciones MACE.


La relación completa se puede consultar en www.conafe.com
Toros MEJORADORES ordenados por ICO. Pruebas CONAFE junio 2013 + MACE agosto 2013 Orden POM
ICO
Tipo Prueba Fiabilidad Hijas Kg. Leche Kg. Grasa % Proteína Kg. Proteína Tipo Prueba Fiabilidad Hijas IPP ICU Fiabilidad R. Células Somáticas Tipo Prueba Fiabilidad Longevidad Tipo Prueba Fiabilidad Días Abiertos Valor Percentil


1ª: Vaca C



2ª: Vaca D



3ª: Vaca B



4ª: Vaca A



Observaciones previas:
Excepcional sección de animales de 4 años, donde contamos con dos vacas proximas entre si y que encabezan fácilmente la categoría .

Explicación oficial:
Introducción:
Comenzamos la sección con la vaca que tiene la mejor ubre y las mejores patas.
1ª sobre 2ª: Por mejores inserciones de ubre tanto anteriores. como posteriores, mejor forma de la ubre y patas en general así como un cuello un poco más largó que la tremenda vaca de Estuctura Lechera colocada en segunda posición.
2ª sobre 3ª: Por una mejor inserción anterior. Por la profundidad de la ubre así como por tener más profundidad y arqueamiento del costillar anterior.
3ª sobre 4ª: Es una colocación fácil donde nuestra vaca negra es más larga en general, posee un mejor tercio anterior y tiene un poquito más de capacidad, textura y mejor forma de la ubre anterior.


Ganador entre los acertantes con pleno:
Jaime Cobo Pelayo, estudiante, Torrelavega (Cantabria).
Resto de acertantes:
Guiem Orfila Camps, estudiante, Menorca (Baleares).

Lorenzo Orfila Mercadal, ganadero, Menorca (Baleares).
Goyo Blanco Álvarez, ganadero, Ribadesella (Asturias)







EXPLICACIÓN DE LA COLOCACIÓN:






Es imprescindible razonar el orden elegido, hablando del conjunto de la sección, mencionando dos o tres características de cada posición y haciendo un comentario final (Consultar “Manual de juzgamiento” de Conafe). Solo se admitirá una respuesta por participante
Introducción:
1ª sobre 2ª:
2ª sobre 3ª:
.......................................................................................................
3ª sobre 4ª:
Conclusiones:
Orden Vaca 1ª 2ª 3ª


Premio: Forro polar de Conafe
Datos del concursante:
Nombre y apellidos:
Profesión:
Dirección: .......................................................................
Código postal, localidad y provincia:
Teléfono:


Con la colaboración de las ganaderías lucenses, Casa Matias y Ganadería Novelle S.C, se celebró la Armonización semestral de calificadores, valorando y discutiendo sobre vacas, unificando criterios y mejorando año tras año las definiciones existentes de los rasgos descriptivos de la morfología.
La parte teorica esta siempre dedicada al análisis de los datos de calificación recogidos durante los seis meses anteriores a la reunión, valorando y comentando, con el Jefe del Departamento de Morfología de Conafe, las gráficas, desviaciones y distribuciones de las calificaciones de los diferentes Rasgos y Regiones de las vacas.
En la era de la genómica, la morfología y la calificación de los animales cobra una especial relevancia para los ganaderos, ya que en un futuro, más o menos próximo, alguien pensará que no será necesario calificar tantas vacas por año para valorar nuestros sementales y reproductoras. Pero es importante decir, al respecto, que la calidad de la información recogida debe mejorarse y que nuestra población de vacas de referencia, con la que se harán estimaciones, debe poseer más información por vaca (más generaciones y familias de vacas calificadas), con lo cual la cantidad de calificaciones tampoco debería bajar mucho hasta que la epigenetica clarifique y verifique aún más las fiabilidades de las pruebas genómicas de nuestros reproductores.
Hasta que la genómica alcance la mayoría de edad, debemos velar y seguir trabajando por mantener y mejorar la morfología de nuestros animales en niveles rentables para nuestras explotaciónes, para lo cual no existe aún mejor valoración de la morfología en el establo que la de un técnico independiente y preparado como son los calificadores de Conafe, quienes, visita tras visita, informaran al ganadero del nivel de calidad morfológica del rebaño .
Cuando califique sus vacas, aproveche el tiempo, teniendo toda la documentación necesaria para la calificación preparada, los animales amarrados y dedique algunos minutos a hablar con el técnico de aquellas partes de la vaca que puedan necesitar mejora, identificando con el calificador las virtudes y defectos de su ganado.
El calificador, después de calificar cada vaca, le dejará
un informe de ella diciéndole, por ejemplo, que:

Una ubre anterior débil no va a contribuir a mejorar la longevidad de nuestras vacas y debemos trabajar por mejorar esa debilidad morfológica y conseguir animales que aguanten mejor las altas producciones a las que en ocasiones están sometidas: Si no hacemos acoplamientos correctivos en nuestra explotación no mejoraremos al ritmo deseado para hacer suficientemente rentable nuestra ganaderia
Si el ángulo podal de la vaca calificada es 2, las posibilidades de cojeras y problemas de podología son mayores, vamos a perder producción, no se van a ver tan claramente los celos, la calidad de la leche se podría ver


Reconocimento a Marga y a los controladores gallegos
Marga fue durante muchos años controladora de Africor Lugo, colaborando y ayudando a organizar las rondas de trabajo con los calificadores de Conafe, Desde estas líneas queremos agradecer a todos los controladores gallegos su ayuda e implicación en la organización de las rondas de calificación y felicitarles por el buen trabajo de campo que desarrollan día a día, ayudando al ganadero a participar más activamente de los programas de mejora y selección de sus explotaciones.
Domingo Ces, calificador de CONAFE Marga, a la derecha, con su familia
Casa Matias en Birbigueiras/San Juan do Campo (Lugo) Ganadería Novelle S.C. Paradela (Lugo)


A continuación aparece la relación de animales (nombre y propietario) calificados durante los meses de MAYO y JUNIO de 2013, que han obtenido las categorías de EX o MB.
En la web de Conafe www.conafe.com aparece esta misma relación junto con el número genealógico y el padre de cada animal. También en esta web, a través de SinbadFree se puede ampliar la información sobre genealogías, índices y producciones de estos animales.
Técnicos Calificadores
Gabriel Blanco del Campo (Jefe del Dpto. de Morfología)
Juan Manuel Fernández Ahedo (Coordinador de Calificadores)

- Marcial Avelló Santiago - Santiago Mato Mantouto
- Domingo Ces Ares - Julián Montero García
- Alejandro Glez. del Valle Mier - Pedro Javier Peréz Pérez
- Luis Mario López Vázquez - Rafael Vierna Pita
MACHOS MB - 86 PUNTOS
BOS XERCAS CAV VALIDO SHOT. ET/GANADERIA ASTURAO, S.C. - LUGO
REGO SANCHEZ SAMUEL/CASA FIOUKEIRA - LUGO
MACHOS MB - 85 PUNTOS
CARBALLO SHOTTLE TORMENTA 6/S.A.T. CASA CARBALLO 1023 XUGA - LUGO
REBOLO MILLION MILLEIROS/A GRANXA DE VAZQUEZ,S.C. - A CORUÑA
SEIJO LOU SUARON/MUNDIN, S.A.T. - LUGO
HEMBRAS 2 VECES EXCELENTES
AVISPA/LA MESQUERIA, S.C. - CANTABRIA
LLERA ANTYE GIBSON/S.A.T. CECEÑO - CANTABRIA
MORY GIBSON ENAMORADO/S.A.T. DISAMA Nº 39014 - CANTABRIA
HEMBRAS EXCELENTES
AMETSLEKU SPIRTE PONDESI/LA FLOR - CANTABRIA
ANTELANA MAILING INQU. 13446/C..ANTELANA,S.COOP.GALEGA - OURENSE


JAIME ROSLE 202/S.A.T. EMILIO DO JAIME - LUGO
LA FLOR RUBENS EVA/LA FLOR - CANTABRIA
LLERA ARIEL GOLDWYN ET/LLERA HER, S.C. - CANTABRIA
LLERA GOLDWYN BLISS 3 ET/LLERA HER, S.C. - CANTABRIA
LLERA GOLDWYN GALA ET/LLERA HER, S.C. - CANTABRIA
LLERA NENITA GOLDWYN/LLERA HER, S.C. - CANTABRIA
LLINDE SUSAN STARTIT/S.A.T. CECEÑO - CANTABRIA
NETHERVALE JEDAR BELHAZEL/PONDEROSA HOLSTEINS - LLEIDA
PEREJIL RIMBOMBANZIA/GRANJA PEREJIL "EL MACHO" - CANTABRIA
PONDEROSA GOLDWYN EZRA ET/PONDEROSA HOLSTEINS - LLEIDA
ROC VEILIN/PONDEROSA HOLSTEINS - LLEIDA
TRESPANDIO GOLDWYN AMANDA/CUDAÑA - CANTABRIA
VARELA BOLTON 4975/VARELA - LUGO
HEMBRAS MB DE 1º PARTO - 87 PUNTOS
BARCENIA BENITA DENZEL/S.A.T. BARCENIA 8.109 - CANTABRIA
BOS SAN-RIAN JERSEY XACOBEO ET/SAN RIAN S.C.GALEGA - A CORUÑA
CUDAÑA ATENAS II OUTBOUND/CUDAÑA - CANTABRIA


HEMBRAS MB DE 1º PARTO - 86 PUNTOS
AETNA 50/FINCA LA ASUNCION - A CORUÑA
ALGRABUSAN ASHLAR 242-0837/S.A.T. ALGRABUSAN - LUGO
ANTELANA KINGLY BUCKEYE 13965/C.ANTELANA,S.C.GALEGA - OURENSE
ARENAS LUNA KINGLY/S.A.T. ARENAS Nº 39119 - CANTABRIA
BOS SANCHEZ BREYA ET/S.A.T. A CAMPA - A CORUÑA
BOUDOIS TASCA WILDMAN/GANADERIA BOUDOIS, S.C. - ASTURIAS
CANEDA NAVIA MAN OMAN/CASA CANEDA - A CORUÑA
CASA-NOVA PANTOJA WILDMAN 785/CASA NOVA SAT.1021 XUGA - A CORUÑA
CASANOVA XACOBEO 7217/CASANOVA - LUGO
CERCAREDO 6770 BOLTON/CERCAREDO - A CORUÑA
CUDAÑA ROSCA KINGLY/CUDAÑA - CANTABRIA
FARIÑEIRO SUPER COUSA/FARIÑEIRO S.A.T. Nº 1049 XUGA - LUGO
GRC 647 XACOBEO/LANDEIRA SDAD.COOP.GALEGA - A CORUÑA
HOPEFUL HVEZDA BRÜHLHOF/PONDEROSA HOLSTEINS - LLEIDA
KLEINE REIXA ALMA GOLDWYN ET/GRANJA REIJA - LUGO
LA FLOR-PONDE SPIRTE MIGUELINA/PONDEROSA HOLSTEINS - LLEIDA
LODOS ASHLAR VILLA/S.A.T. LODOS E PEREZ N.940 XUGA - LUGO
LODOS XACOBEO SETENTA/S.A.T. LODOS E PEREZ N.940 XUGA - LUGO
LVFILOUSE BRONCO VALTON/PONDEROSA HOLSTEINS - LLEIDA
MANTOÑO DUPLEX LAUSANA ET/MANTOÑO HOLSTEIN - LUGO
MANTOÑO SHOTTLE DAIRA/MANTOÑO HOLSTEIN - LUGO
OUTEIRO MILLION VITA/GANDERIA SINESIO, S.C. - A CORUÑA
OYAMBRE LISA DAMION/S.A.T. TESERNA - CANTABRIA
PADRON BELEN 345 MILLION/GANDEIRA L.CORNES, S.C. - A CORUÑA
PENA RAMPAGE CHAMOSO/GANADERIA PENA - LUGO
PENA SHOTTLE BLITZ/GANADERIA PENA - LUGO
RHIANA ALEXANDER MOX/PONDEROSA HOLSTEINS - LLEIDA
ROXO AFTERSHOCK TOBRA/CASA ROXO - ASTURIAS
S.M. JOHANA GIRON/SAÑUDO HOLSTEIN - CANTABRIA
SAN-RIAN TRIANA MILLION/SAN RIAN S.COOP.GALEGA - A CORUÑA
SERPA GRAND HILARY/PONDEROSA HOLSTEINS - LLEIDA
TEIXEIRO SANCHEZ XUXA/S.A.T. TEIXEIRO - LUGO
TEIXEIRO XACOBEO GLIXA/S.A.T. TEIXEIRO - LUGO
V 4453/VAZQUEZ, S.C. - CANTABRIA
V. EMIR 1875/VAZQUEZ, S.C. - CANTABRIA
VALIÑOS DUPLEX FALI/S.A.T. GANADERIA VALIÑOS - LUGO
VARELA BUCKEYE 1837/VARELA - LUGO
XERCAS CAV SANDIA SHOTTLE/CAVADAS S.A.T. XUGA 941 - LUGO
XERCASPORTA DURO CASILLAS/PORTALOUSA - LUGO
HEMBRAS MB DE 1º PARTO - 85 PUNTOS
ALGRABUSAN CID 302-1536/S.A.T. ALGRABUSAN - LUGO
ALGRABUSAN MILLION 208-8929/S.A.T. ALGRABUSAN - LUGO
ALGRABUSAN XACOBEO 266 0789/S.A.T. ALGRABUSAN - LUGO
ANTELANA KINGLY LHEROS 13971/C.ANTELANA,S.C.GALEGA - OURENSE
ARENAS CASTEL KINGLY/S.A.T. ARENAS Nº 39119 - CANTABRIA
ARGELINA AIRBAG AINOA/GANADERIA ARGELINA - PONTEVEDRA
BAHAMA ROJA DESTRY MOX/PONDEROSA HOLSTEINS - LLEIDA
BAILARETA LUCUS NAR-XOSE/NAR-XOSE,SDAD.COOP.GALEGA - LUGO
BAMBU RESTELL NAR-XOSE/NAR-XOSE,SDAD.COOP.GALEGA - LUGO
BARCENIA BOCANEGRA BOGOTA/S.A.T. BARCENIA 8.109 - CANTABRIA
BELLO 157 XACOBEO/BELLO - A CORUÑA
BLANCO ANITA TILA ET/GANDERIA BLANCO,S.L. - PONTEVEDRA
BOS ANDURIÑA RUTH GOLDWYN ET/ANDURIÑA - A CORUÑA
BOS BLANCO GIPSY GRAND VALI ET/GANDERIA BLANCO,S.L. - PONTEVEDRA
BOS COCHERO SUPER DINA ET/CASA COCHERO - LUGO
BOS MILLION AIKO ET/SAN RIAN SDAD.COOP.GALEGA - A CORUÑA
BOS SANCHEZ BLANCANIEVES ET/POUPARIÑA S.A.T. - LUGO
BOS SHOTTLE VALENTINA ET/S.A.T. A CAMPA - A CORUÑA
BOS XERCASPORTA BAXT CAMELA ET/PORTALOUSA - LUGO
CABANAS REBA SANCHEZ/CABANAS - A CORUÑA
CAMPOGRANDE 1261 BOLIVIA/CAMPOGRANDE-A PENA, S.C. - A CORUÑA
CANEDA NATILLA MILLION/CASA CANEDA - A CORUÑA
CANTON ARDA BONAIR/EL CANTON, S.C. - CANTABRIA
CARBALLO SHOTTLE MARLEEN II/S.A.T. CASA CARBALLO 1023 XUGA - LUGO
CARBALLO SHOTTLE RAFAELA 807/S.A.T. CASA CARBALLO 1023 XUGA - LUGO
CARLOS GERARD JENNY/CARLOS IGLESIAS CARREIRA - LUGO
CASA-NOVA CANDELA WILDMAN 771/CASA NOVA SAT. 1021 XUGA - A CORUÑA
CASA-NOVA MERA MINISTER 802/CASA NOVA SAT. 1021 XUGA - A CORUÑA
CASA-NOVA URSULA DUPLEX 806/CASA NOVA SAT. 1021 XUGA - A CORUÑA
CASEIRODERNES TALENT SUEVIA/CASEIRO DE ERNES S.A.T. - LUGO
CASTRO NEREA MORRISON/CASA CASTRO, S.C. - A CORUÑA
CERRACIN 406 MARCELA XACOBEO/CERRACIN - LUGO
CHACO 444-26 SHOTTLE 2080/CHAIN GANDEIRA,S.L. - LUGO
CID DESTRY LOCA/GANDEIRIA CID, S.C. - LUGO
CID DUPLEX RACHELLE/GANDEIRIA CID, S.C. - LUGO
CID SANCHEZ RONKETA/GANDEIRIA CID, S.C. - LUGO
CIERRON ETHEL 26 MOSCOW/ELOY Y TERESA DE MIER, C.B. - CANTABRIA
CIUCENDE XACOBEO 9329/AGROCIOCENDE, S.C. - A CORUÑA
CONCHADOS SHOTTLE KALI/CONCHADOS, S.C. - LUGO
CUDAÑA BIENVE TEE OFF/CUDAÑA - CANTABRIA
CUDAÑA DESIDIA XACOBEO/CUDAÑA - CANTABRIA
CUDAÑA EMANA IOTA/CUDAÑA - CANTABRIA
CUDAÑA MANDY OUTBOUND/CUDAÑA - CANTABRIA
DA FONTE NICOL PAULINA/CASA DA FONTE - LUGO
DEMETRIO 3913 TIMBER/CASA DEMETRIO - LUGO
DOCAMPO CRISANTO CRISALIDA/DO CAMPO - LUGO
DOCAMPO XACOBEO ALJAZIRA/DO CAMPO - LUGO
EXPLORERR/S.A.T. MIRAS 1124 XUGA - A CORUÑA

FARIÑEIRO DESTRY MAREA ROJA/FARIÑEIRO SAT. Nº 1049 XUGA - LUGO
FARIÑEIRO MR SAM CIELO/FARIÑEIRO S.A.T. Nº 1049 XUGA - LUGO
FARRAQUEIRAS 1 XACOBEO FABIOLA/FARRAQUEIRAS 1 - LUGO
FARRUCO 162 XACOBEO/CASA FARRUCO - A CORUÑA
FARRUCO 163 XACOBEO/CASA FARRUCO - A CORUÑA
FITJIE/CASA DE BOGA - A CORUÑA
FONCUBERTA HOWIE LHEROS 7250/C.COM.DE FONCUBERTA - OURENSE
FOROS GERARD MINGA/S.A.T. OS FOROS - LUGO
FOURMIE 1165/SAMEDE SDAD.COOP.LTDA.GALEGA - A CORUÑA
FREIRE HOWIE 6274/FREIRE - LUGO
G.DUBRA.S.C. 289/GANADERIA DUBRA, S.C. - A CORUÑA
GALAN MINISTER SAMBA/GALAN S.A.T. 994 XUGA - LUGO
GAND-BATALLA BETANIA GOLDWYNET/GAND.BATALLA, S.C. - A CORUÑA
GAND-BATALLA GARDENIA GABOR/GAND. BATALLA, S.C. - A CORUÑA
GAND-BATALLA TESORO TEE OFF/GAND. BATALLA, S.C. - A CORUÑA
GRANCORONA SOUDAN 0809/S.L. GRAN CORONA - LUGO
GRC 608 SHOTTLE/LANDEIRA SDAD.COOP.GALEGA - A CORUÑA
GRC 645 GARRET/LANDEIRA SDAD.COOP.GALEGA - A CORUÑA
GRC 661 SHOTTLE/LANDEIRA SDAD.COOP.GALEGA - A CORUÑA
IGLESIAS 269 SHOTTLE/GANADERIA IGLESIAS - A CORUÑA
ILMA 059 XACOBEO/S.A.T. 828 ILMA-XUGA - A CORUÑA
J. DO ORDEIRO MEGAROY MIMOSA/O ODREIROM S.C. - LUGO
KLEINE REIXA TRAKA KNOWLEDGE/GRANJA REIJA - LUGO
LAMELAS SCOOBY-DUU 278 LUPE/S.A.T. LAMELAS 982 XUGA - LUGO
LARNACA ATWOOD MOX/PONDEROSA HOLSTEINS - LLEIDA
LLERA LAURIN AMNESIA/LLERA HER, S.C. - CANTABRIA
LLERA OSCAR DAMION/LLERA HER, S.C. - CANTABRIA
LLERA SANCHEZ ASPIRINA/LLERA HER, S.C. - CANTABRIA
LODOS GERARD GUINEA/S.A.T. LODOS E PEREZ N.940 XUGA - LUGO
M. MAJESTY 3785 JAZZMAN/S.A.T. MIRAMAR N. 1008 - CANTABRIA
MANEIRO 2669 DANCER/MANEIRO - A CORUÑA
MANEIRO 5150 XACOBEO/MANEIRO - A CORUÑA
MANSILLA NOELIA SHOTTLE/MONICA LANDEIRA NOYA Y OTRO, S.C. - A CORUÑA
MANTOÑO DAMION NIVIDA/MANTOÑO HOLSTEIN - LUGO
MANTOÑO DELETE FROST/MANTOÑO HOLSTEIN - LUGO
MANTOÑO GOLDWYN VICTORIA ET/MANTOÑO HOLSTEIN - LUGO
MANTOÑO SANCHEZ DUINA/MANTOÑO HOLSTEIN - LUGO
MANTOÑO TALENT CHUECA/MANTOÑO HOLSTEIN - LUGO
MANTOÑO TALENT NIVIDA/MANTOÑO HOLSTEIN - LUGO
MAREY QUINTIAN ROSITA/GANADERIA MAREY CASTRO, S.C. - LUGO
MASEDA DELETE 298/LOPEZ TELLADO,MASEDA, S.C. - LUGO
MATIAS ALEXANDER 2008/CASA MATIAS - LUGO
MATIAS ALEXANDER 2009/CASA MATIAS - LUGO
MENOR BRONCO LUNA/S.A.T. CASA MENOR 1017 XUGA - A CORUÑA
MESON 3877/AS TRAVESAS AGROPECUARIA,S.L. - A CORUÑA
MINZE/FINCA LA ASUNCION - A CORUÑA
NAVE MR SAM FIO 2110/LA NAVE, S.C. - LUGO
NAVE ROY DAFNE 6476/LA NAVE, S.C. - LUGO
NAVE ROY EXTILA 1518/LA NAVE, S.C. - LUGO
NODI DAMION REGINA/NODI, S.C. - LUGO
OCEJO JAMAIKA CHAMONIX/LLERA HER, S.C. - CANTABRIA
OUTEIRO TUNNO KEYTY/GANDERIA SINESIO, S.C. - A CORUÑA
OYAMBRE NATACHA SANCHEZ/S.A.T. TESERNA - CANTABRIA
OYAMBRE ROMINA GLEN/EL CANTON, S.C. - CANTABRIA
P.V.P. PERLA 8801 BETANZOS/GANADERIA DO MOURO,S.C. - A CORUÑA
PADRON FLORINDA 336 TEE OFF/GANDEIRA L.CORNES, S.C. - A CORUÑA
PADRON 358 CARMELA JORDAN/GANDEIRA L.CORNES, S.C. - A CORUÑA
PENA LHEROS LADY/GANADERIA PENA - LUGO
PERILLA POZAS XACOBEO/S.A.T. PERILLA Nº 1031 XUGA - A CORUÑA
PETEIRA NEPTUNO 450/S.A.T. PETEIRA - LUGO
PETEIRA NEPTUNO 455/S.A.T. PETEIRA - LUGO
PONDEROSA MILLION PATY/PONDEROSA HOLSTEINS - LLEIDA
PONDEROSA SHOTTLE ATLEE 2/PONDEROSA HOLSTEINS - LLEIDA
QUINTIAN ALEXANDER ALEXIA/QUINTIAN, S.C. - LUGO
QUINTIAN BOLTON BOLERA/QUINTIAN, S.C. - LUGO
RENSKE 312 BLITZ/FINCA LATA - A CORUÑA
RIO PROTOCOL 4240/S.A.T. RIO - LUGO
ROOSJE 191/CASA DE BOGA - A CORUÑA
SAAMIL PINTA XACOBEO/SAAMIL - A CORUÑA
SAAMIL XACOBEO LANA/SAAMIL - A CORUÑA
SALGUEIRO ASHLAR VIANA/S.A.T. G.O SALGUEIRO 1244 XUGA - A CORUÑA
SALGUEIRO JORDAN NUVEIRA/S.A.T. G.O SALGUEIRO 1244 XUGA - A CORUÑA
SATDOCAMPO 805 MAGOT/DO CAMPO S.A.T. 975 XUGA - A CORUÑA
SIDRO DUPLEX BALIRA/ISIDRO, S.C. - ASTURIAS
SIDRO MOSCOW CHAMPION LAY/ISIDRO, S.C. - ASTURIAS
SILVELA DIVINA TOYSTORY/CASA SILVELA, S.C. - ASTURIAS
T. AMAZING 3325/S.A.T. TESERNA - CANTABRIA
T. OUTBOUND 9001/S.A.T. TESERNA - CANTABRIA
T. T.GOLDWYN 9002/S.A.T. TESERNA - CANTABRIA
TEC ROXO BAXTER DACIA ET/CASA ROXO - ASTURIAS
TEIXEIRO GOLDWYN GLICA ET/S.A.T. GAIGO XUGA 1074 - LUGO
TEIXEIRO SANCHEZ BETTER/S.A.T. TEIXEIRO - LUGO
TEIXEIRO XUDAN QUINTA/S.A.T. TEIXEIRO - LUGO
TEJAR BURBUJA DUPLEX/EL TEJAR - CANTABRIA
TENDEIRO SHOTTLE MONICA ET/TENDEIRO - LUGO
TUERKIN 23/FINCA LA ASUNCION - A CORUÑA
UGASMA GRAND 7261/UGASMA - A CORUÑA
VIDUANE BOLIVIA 1083/VIDUANE, S.C. - OURENSE
VIEITES SANTA SHOTTLE/VIEITES - A CORUÑA
VILARIÑO GABOR ALEJANDRA 641/G. VILARIÑO, S.A.T. 985 XUGA - A CORUÑA
XEPE LAWN BOY ROXETTE ROJA/CASA XEPE - LUGO
XERCAS CAV ELVIRA SHOTTLE/CAVADAS S.A.T. XUGA 941 - LUGO
XERCAS DELTA ROUMARE/GANADERIA PERNAS, S.C. - LUGO
XERCASPORTA PIKACHU TEOFILA/PORTALOUSA - LUGO
0297 SOLEDAD CUBELA WILDMAN/CUBELA XUGA S.A.T. - A CORUÑA
0697/BAUTISTA - A CORUÑA
0912/BRAÑA - A CORUÑA
234 ALEX/GANADERIA CORTIGUERA, S.C. - CANTABRIA
8517 MIGUELITA/FINCA LA ASUNCION - A CORUÑA
HEMBRAS MB DE 2º O MÁS PARTOS - 89 PUNTOS
KLEINE REIXA MISKA BURNS ET/VARELA - LUGO
XERCAS CAV GLINDY SANCHEZ ET/CAVADAS S.A.T. XUGA 941 - LUGO
HEMBRAS MB DE 2º O MÁS PARTOS - 88 PUNTOS
ALGRABUSAN DUPLEX 155-0440/S.A.T. ALGRABUSAN - LUGO
ANDURIÑA ESTELA MILLION/ANDURIÑA - A CORUÑA
ARGELINA TALENT TELLA ET/GANADERIA ARGELINA - PONTEVEDRA
ASUNCION XACOBEO BEA/FINCA LA ASUNCION - A CORUÑA
BADO PRINCESA FINAL CUT/S.A.T. SERJA Nº 39018 - CANTABRIA
BOS MAREY GOLDWYN MALPICANA ET/GAN. MAREY CASTRO, S.C. - LUGO
CAMINERO GOLDWYN 4708/CAMINERO, S.A.T. - LUGO
CANEDA RUTA XACOBEO/CASA CANEDA - A CORUÑA
CARBALLO JAZMIN DUPLEX 603/S.A.T. CASA CARBALLO 1023 XUGA - LUGO
CASILMOURE BOLTON ALMUDENA/GANDERIA BLANCO,S.L. - PONTEVEDRA
CHACO LOLA ELAYO RED 1761/CHAIN GANDEIRA,S.L. - LUGO
DA FONTE BUCKEYE ALASKA/CASA DA FONTE - LUGO
DUPA AARON NINA PATRI/CASA GRANDE DE RODIS - A CORUÑA
ERPA 6397 GOL/SALGUEIROS - A CORUÑA
GAIGO GOLDWYN JULIA ET/S.A.T. GAIGO XUGA 1074 - LUGO
LA FLOR TALENT MATEA/LA FLOR - CANTABRIA
LA MESQUERIA FANTASIA SPIRTE/LA MESQUERIA, S.C. - CANTABRIA
LA MESQUERIA NINA TOYSTORY/LA MESQUERIA, S.C. - CANTABRIA
LINA BOLTON MAYRA/LINA - LUGO
LLINDE ANDREITA TOYSTORY/S.A.T. CECEÑO - CANTABRIA
LLINDE MARLA PASEN MARSH/S.A.T. CECEÑO - CANTABRIA
LODOS TALENT NOA/S.A.T. LODOS E PEREZ N.940 XUGA - LUGO
MANTOÑO BAXTER RIANA/MANTOÑO HOLSTEIN - LUGO
MANTOÑO LHEROS CLAUDIANA/MANTOÑO HOLSTEIN - LUGO
MANTOÑO MENDEL DUPLEX DAISA/MANTOÑO HOLSTEIN - LUGO
MENOR CARY/S.A.T. CASA MENOR 1017 XUGA - A CORUÑA
OUTEIRO FINAL CUT BOHEMIA/S.A.T. GANADERIA XUSTO - LUGO
OUTEIRO FINAL CUT SISI/S.A.T. TEIXEIRO - LUGO
PADRON 302 ROY/GANDEIRA L.CORNES, S.C. - A CORUÑA
2590 AUDI/S.A.T. VALDEAMIGO - CANTABRIA
HEMBRAS MB DE 2º O MÁS PARTOS - 87 PUNTOS
AMETSLEKU TALENT PONDEJUMA/PONDEROSA HOLSTEINS - LLEIDA
ANDURIÑA MERCEDES TALENT/ANDURIÑA - A CORUÑA
ANTELANA DANCER AEROLINE 13829/C.ANTELANA,S.C.GALEGA - OURENSE
ARENAS HILDA TRIBUTE/S.A.T. ARENAS Nº 39119 - CANTABRIA
AS CRUCES FONTANS MARIPOSA/VEIGA DE FEXACOS, S.C. - LUGO
ASUNCION BUCKEYE GEMMA 3/S.A.T. CASA CARBALLO 1023 XUGA - LUGO
ASUNCION DUPLEX TIPSY 11/FINCA LA ASUNCION - A CORUÑA
BADO FLORA WILDMAN/S.A.T. SERJA Nº 39018 - CANTABRIA
BATALLA LOLITA ROUKI/BATALLA,S.C. - A CORUÑA
BLANCO MEGATILA/GANDERIA BLANCO,S.L. - PONTEVEDRA
BOURIO BAMBI BUCKEYE/FONTE DE BOURIO - ASTURIAS
CABANAS CURIOSA BOLTON/CABANAS - A CORUÑA
CANDENDO 176/GANADERIA CANDENDO, S.C. - A CORUÑA
CANEDA NACHA GOLDWYN ET/CASA CANEDA - A CORUÑA
CASAGRANDE XACOBEO XEADA/A CASA GRANDE, S.C. - LUGO
CERCAREDO 7941 LHEROS/CERCAREDO - A CORUÑA
CERRACIN 387 LUGUESA NEGUNDO/CERRACIN - LUGO
CERRACIN 393 CHINITA BOLIVIA/CERRACIN - LUGO
CHINELO BOLTON 2058/CHINELO, C.B. - LUGO
CID GOLDWYN MATIGUEIRA ET/GANDEIRIA CID, S.C. - LUGO
CRISTAL/FOCARA - ASTURIAS
CUDAÑA AMERICA BAXTER/CUDAÑA - CANTABRIA
CUDAÑA JANA FINEST/CUDAÑA - CANTABRIA
EIRAS SALVA 200 2881/CASA BARBEIRO, S.C. - LUGO
ELITRAVE/CASA DE BOGA - A CORUÑA
GRACOZA DUPLEX CACERYN/LAR DE GRACOZA, S.C. - LUGO
GRUEIRA FDEZ SPIKE 2279/S.A.T. GRUEIRA FERNANDEZ - LUGO
JAVIER DARTER MARQUESA/RATO, S.C. - PONTEVEDRA
JOSE DE CANDIDA VIDUEIRO ROSCA/CASA JOSE DE CANDIDA - LUGO
KLEINE REIXA KORAL KALIXTO/GRANJA REIJA - LUGO
LOUREIROS CEBRA AIRRAID/RIAL DE LOUREIROS - A CORUÑA
LOUREIROS SABELA GOLDWYN/RIAL DE LOUREIROS - A CORUÑA
MARAGOTO MOES PANPIDA/CASA MARAGOTO - LUGO
MASEDA SHOTTLE 273/LOPEZ TELLADO,MASEDA, S.C. - LUGO
PONDEROSA LHEROS ERA ET/PONDEROSA HOLSTEINS - LLEIDA
RIO BETANZOS 0085/S.A.T. RIO - LUGO
SAT FERNANDO 678 CECILIA TALEN/C. FERNANDO SAT.1122 XUGA - A CORUÑA
TEIXEIRO SHOTTLE YONA/S.A.T. TEIXEIRO - LUGO
VEGA MEGAMAGIC MARTA/VEGA, C.B. - LUGO
VILARIÑO BUCKEYE KNIJA 518/GXA. VILARIÑO, SAT. 985 XUGA - A CORUÑA
XACOBE STORMATIC MORITA/GANADERIA XACOBE - PONTEVEDRA
8437 ALMA GOLDWYN REBOLLO/EL REBOLLO - CANTABRIA
HEMBRAS MB DE 2º O MÁS PARTOS - 86 PUNTOS
A GRANDA BOLTON BELA/A GRANDA - LUGO
A-COSTA-S.C. 7961 BOLTON/GRANXA A COSTA, S.C. - A CORUÑA
ABALUME LANDRA GINEBRE 3/GRANJA DE LEA - LUGO
ABUANDI BOTAFOGO 3754/ABUIDE E ANDION S.A.T. - LUGO
ADRIANO GOSPELL 8853/CASA ADRIANO - LUGO
ALGRABUSAN SHOTTLE 210-4607/S.A.T. ALGRABUSAN - LUGO
AMPU MR. BURNS 220/PUMAR DE BUXAN - A CORUÑA
ANTELANA BONAIR STARDEL 13856/C.ANTELANA,S.C.GALEGA - OURENSE
ANTELANA SPIRTE LOURO 13730/C.ANTELANA,S.C.GALEGA - OURENSE
ARENAS SIENA DUPLEX/S.A.T. ARENAS Nº 39119 - CANTABRIA
AS CARGAS TALENT ALMUDENA/GAND. AS CARGAS, S.C. - A CORUÑA
ASTURAO SC DARTER PILARINA/GANADERIA ASTURAO, S.C. - LUGO
ATONITA ROY NAR-XOSE/NAR-XOSE,SDAD.COOP.GALEGA - LUGO
BADO DOROTEA MERCHANT/S.A.T. SERJA Nº 39018 - CANTABRIA
BADO MANDARINA FINAL/S.A.T. SERJA Nº 39018 - CANTABRIA
BASILIO 327 CASHMERE/GANDEIRIA LISTE REY, S.C. - A CORUÑA
BASILIO 332 ZESTY/GANDEIRIA LISTE REY, S.C. - A CORUÑA
BASILIO 347 BOLTON/GANDEIRIA LISTE REY, S.C. - A CORUÑA
BATALLA MANATA MANAT/BATALLA,S.C. - A CORUÑA
BATALLA SECA TOYSTORY/BATALLA,S.C. - A CORUÑA
BELLO 104 MR SAM/BELLO - A CORUÑA
BELLO 115 BOLTON/BELLO - A CORUÑA
BLANCO.H TOYSTORY DELIA/GANDERIA BLANCO,S.L. - PONTEVEDRA
BLANCOH. TOYSTORY ABELLA ET/GANDERIA BLANCO,S.L. - PONTEVEDRA
BOLECA 8906 BOLTON/BLANCO DE VILLALBA, S.C. - A CORUÑA
BOS ARMSTEAD VICTORIA ET/POUPARIÑA S.A.T. - LUGO
BOS BLANCO LAURI SHEIK LANA ET/GANDERIA BLANCO,S.L. - PONTEVEDRA
BOS XERCAS CAV ANA LAW.ROJA ET/CAVADAS S.A.T. XUGA 941 - LUGO
C.ROMERO BOTITA B.FOGO/GRANXA ROMERO, S.C. - A CORUÑA
CABO XACOBEO CAMILA/CASA DO CABO - LUGO
CANDENDO 234/GANADERIA CANDENDO, S.C. - A CORUÑA
CASEIRODERNES RUBENS FABIOLA/GANDERIA SINESIO, S.C. - A CORUÑA
CUDAÑA VALKIRIA JAYZ/CUDAÑA - CANTABRIA
CUMBRAOS BLITZ MAIRA/GANADERIA CUMBRAOS - PONTEVEDRA
DA FONTE MEGAMATIC BRISA/CASA DA FONTE - LUGO
DEBAIXO BURNS 0745 KALIMA ET/CASA DE BAIXO - PONTEVEDRA
DENOY 044/DENOY, S.A. - A CORUÑA
DUBRA 3258 TALENT/CASA DUBRA, S.C. - A CORUÑA
DUBRA 8887 DUPLEX/CASA DUBRA, S.C. - A CORUÑA
DUPA DUPLEX KIKA RITA/CASA GRANDE DE RODIS - A CORUÑA
EIRAS DUPLEX MESMO/S.A.T. PAZO DE EIRAS - LUGO
EL PUMAR BELINDA BOTAFOGO/EL PUMAR - A CORUÑA
ESPUMA 8685 CUBELA SPIRTE/CUBELA XUGA S.A.T. - A CORUÑA
F.M. 3445 DUPLEX 1313/S.A.T. FAMILIA MARTINEZ - A CORUÑA
FANDIÑO 8216 NED/GANDERIA SINESIO, S.C. - A CORUÑA
FERREIRO BERTA RIRSHALL/CASA FERREIRO - ASTURIAS
FIDEL KORSO 9747/CASA FIDEL - LUGO
FOROS XACOBEO NIEVES/S.A.T. OS FOROS - LUGO
GAFEIRO ALA ALADIN/GAFEIRO, S.C. - ASTURIAS
GALAN MINISTER LERIDA/GALAN S.A.T. 994 XUGA - LUGO
GARCIA CALYPSO SUECA/S.A.T. HERBON NUÑEZ - LUGO
GESTOSO LANDOI TESSIE/GANDERIA GESTOSO, S.C. - PONTEVEDRA
GRANDE BORBONA BARB ROJA/S.A.T. GRANDE - LUGO
GRANDELO BLITZ MARTINA/GANADERIA GRANDELO - LUGO
GRANDELO XACOBEO XACOBEA/GANADERIA GRANDELO - LUGO
GRC 396 BUCKEYE/LANDEIRA SDAD.COOP.GALEGA - A CORUÑA
GRC 573 XACOBEO/LANDEIRA SDAD.COOP.GALEGA - A CORUÑA
HENAR RONDEL XAQUIRA/RAIOLA, S.C. - LUGO
JAIME DASKIN 306/S.A.T. EMILIO DO JAIME - LUGO
LA FLOR TALENT ANGELINA/LA FLOR - CANTABRIA
LA FLOR TALENT FLORENTINA/LA FLOR - CANTABRIA
LANDEIRA-OA EVA BOLTON/CASA LANDEIRA DE OA.S.C. - A CORUÑA
LIÑARES 160 BOLTON/A ROUBADA, S.C. - A CORUÑA
LIÑARES 164 XACOBEO/A ROUBADA, S.C. - A CORUÑA

MASEDA MOES 270/LOPEZ TELLADO,MASEDA, S.C. - LUGO
MASEDA XACOBEO 279/LOPEZ TELLADO,MASEDA, S.C. - LUGO
MESON 3326/AS TRAVESAS AGROPECUARIA,S.L. - A CORUÑA
MIRTA CUBELA MTOTO/CUBELA XUGA S.A.T. - A CORUÑA
MORAO SANTA XACOBEO/MORAO - A CORUÑA
NAVE LHEROS ROCA 9358/LA NAVE, S.C. - LUGO
NAVE ROY GRETAL 7685/LA NAVE, S.C. - LUGO
NAVE SEPTEMBER MONI 9356/LA NAVE, S.C. - LUGO
O-BATALLA JOYA GOLDWYN/GANADERIA BATALLA, S.C. - A CORUÑA
O-BATALLA MISTELA ROY/GANADERIA BATALLA, S.C. - A CORUÑA
OPICO LANDOI ARDILLA/GANDERIA O PICO, S.C. - PONTEVEDRA
OUTEIRO BUCKEYE 387/OUTEIRO-FRADES S.A.T. 942 - A CORUÑA
PACA SEPTEMBER MILA 648/PACA, S.C. - LUGO
PADIN SOSA LILA/CASA GRANDE PADIN - PONTEVEDRA
PADRON ESCARLET 295 XACOBEO/GANDEIRA L.CORNES, S.C. - A CORUÑA
PADRON VIRUTAS 297 MILLION/GANDEIRA L.CORNES, S.C. - A CORUÑA
PADRON 283 ROY/GANDEIRA L.CORNES, S.C. - A CORUÑA
PADRON 301 BOLIVIA/GANDEIRA L.CORNES, S.C. - A CORUÑA
PANTALEON MINIA RIAZOR/PANTALEON - A CORUÑA
PEÑARA P.L. XACOBEO/S.A.T. PEÑARA Nº9678 - CANTABRIA
PEDREIRO BOTAFOGO 91/CASA PEDREIRO - LUGO
PENA DUPLEX JOLT/GANADERIA PENA - LUGO
PENEDO CAROCHA BUCKEYE/FINCA MARISA - A CORUÑA
PEREJIL CACHONDA ET/GRANJA PEREJIL "EL MACHO" - CANTABRIA
PIÑEIRO BRENDA RISING STAR/GANADERIA DE PIÑEIRO, S.C. - ASTURIAS
POLO XACOBEO XACOBEA/CASA DE POLO, S.C. - LUGO
PONDEROSA GOLDWYN PETRA/PONDEROSA HOLSTEINS - LLEIDA
PONDEROSA SANCHEZ EMILIA/PONDEROSA HOLSTEINS - LLEIDA
PONDEROSA SPIRTE TEKA/PONDEROSA HOLSTEINS - LLEIDA
ROYAL ROY NAR-XOSE/NAR-XOSE,SDAD.COOP.GALEGA - LUGO
SALGUEIROS MIRTA DUPLEX/SALGUEIROS - A CORUÑA
SAN CRISTOBAL QUINTANA BLITZ/SAN CRISTOBO - A CORUÑA
SAN RIAN ROMINA ROY/SAN RIAN SDAD.COOP.GALEGA - A CORUÑA
SANTALUCIA 8001 ASHERS/S.A.T. SANTA LUCIA - A CORUÑA
SATDOCAMPO 590 TALENT/DO CAMPO S.A.T. 975 XUGA - A CORUÑA
SATDOCAMPO 628 LUCENTE/DO CAMPO S.A.T. 975 XUGA - A CORUÑA
SATMARIÑO 431 STORMATIC/S.A.T.FINCA MARIÑO Nº1108 XUGA - A CORUÑA
SERNA DOLTI/SERNA - CANTABRIA
SIÑEIRO BOLTON BIMBA/SIÑEIRO, S.L. - LUGO
SOUTO 99 BOTAFOGO/SAR, SAT 1388 XUGA - A CORUÑA
TAROLO CHAMOSO PICARA 8084/CASA TAROLO - LUGO
TARREO BUCKEYE 306 6602/FINCA TARREO,S.A. - A CORUÑA
TOMASA BOTAFOGO FANECA/TOMASA - PONTEVEDRA
VALERIA/REY LOPEZ - A CORUÑA
VIEITES MONCHA MAGNUN/VIEITES - A CORUÑA
VIETES GRATA DUPLEX/VIEITES - A CORUÑA
VILA 531 FORD/S.A.T. GANADERIA VILA DE SANTAIA - A CORUÑA
VILARIÑO ALBAR ENSALADA 553/G. VILARIÑO, SAT. 985 XUGA - A CORUÑA
VILARIÑO GOLDWYN PICARA 440/G. VILARIÑO, SAT. 985 XUGA - A CORUÑA
VISAYA ARMSTEAD MAZORCA/AS TRAVESAS AGROPECUARIA,S.L. - A CORUÑA
XANANTONIO BOLTON LINDA 3604/XANANTONIO - LUGO
XERCAS CHUSCA MODEL/GANADERIA PERNAS, S.C. - LUGO
XERCAS LISA SANCHEZ/GANADERIA PERNAS, S.C. - LUGO
XERCASPORTA BOLIVIA BOLIVIA/PORTALOUSA - LUGO
XERCASPORTA SHOTTLE PETRUSKA/PORTALOUSA - LUGO
XIROME LUA LHEROS/GANADERIA XIROME,S.C. - A CORUÑA
282/CASTRO NOYA,S.C. - A CORUÑA
292/FINCA LA ASUNCION - A CORUÑA
330/ROSENDE DE SAMEDE - A CORUÑA
4137 REDONDA/CASTRO, S.C. - A CORUÑA
HEMBRAS MB DE 2º O MÁS PARTOS - 85 PUNTOS
A CHEDA 8509/S.A.T. FINCA A CHEDA 976 XUGA - A CORUÑA
A CHEDA 8852/S.A.T. FINCA A CHEDA 976 XUGA - A CORUÑA
A PEDRA EMIR 362/A PEDRA S.A.T. Nº 1188 XUGA - A CORUÑA
ABALUME GICA LANDOI 173/GRANJA DE LEA - LUGO
ABALUME IRENE BOLTON 83/PORTO - LUGO
ABALUME TATI ROUMARE 18/GRANJA DE LEA - LUGO
ADONIS BETANZOS XIRA/CASA ADONIS - LUGO
AIRELLE 9076 NATI/ESTEBANO, S.C. - LUGO
ALAMBRERO AMERICAN MILAGROS/ALAMBRERO, S.C. - LUGO
ALAMBRERO ELEGANT ALEGRE/ALAMBRERO, S.C. - LUGO
ALEX TOYSTORY 2949/MOURE - OURENSE
AMAPOLA DOLMAN/GRANJA LA CASONA - CANTABRIA
AMPU BANDERAS 232/PUMAR DE BUXAN - A CORUÑA
AMPU BOLTON 269/PUMAR DE BUXAN - A CORUÑA
ANCADO LUCUS BELEN/ANCAO,S.C. - LUGO
ANDION SMART 3120/ANDION - LUGO
ANDRES VINKY 5560 MARIPOSA/CASA ANDRES - PONTEVEDRA
ANDURIÑA ELEGANT JANA/SC GANADERIA ANDURIÑA - LUGO
ANDURIÑA PIJARA LOMAX/ANDURIÑA - A CORUÑA
ANTELANA ICE PACK STORMATIC/C.ANTELANA,S.C.GALEGA - OURENSE
ANTELANA MAGOT LHEROS 13831/C.ANTELANA,S.C.GALEGA - OURENSE
ANTELANA ORTO ARTIST 13874/C.ANTELANA,S.C.GALEGA - OURENSE
ANTELANA SPIRTE LYSTER 13631/C.ANTELANA,S.C.GALEGA - OURENSE
ANTELANA SPIRTE TITANIC 13632/C.ANTELANA,S.C.GALEGA - OURENSE
ARENAS BRINA TALENT/S.A.T. ARENAS Nº 39119 - CANTABRIA
ARENAS CALA BAXTER/S.A.T. ARENAS Nº 39119 - CANTABRIA
ARENAS MONEY WILDMAN/S.A.T. ARENAS Nº 39119 - CANTABRIA
ARENAS RANIA BAXTER/S.A.T. ARENAS Nº 39119 - CANTABRIA
AS CRUCES INCOME ROSANA/VEIGA DE FEXACOS, S.C. - LUGO
AS CRUCES TRIBUTE SIRENA/VEIGA DE FEXACOS, S.C. - LUGO
ASTURAO SC DANCER ANDURIÑA/GANADERIA ASTURAO, S.C. - LUGO
ASTURAO SC MAESO LISA/GANADERIA ASTURAO, S.C. - LUGO
ASTURAO SC TENORIO SOFIA/GANADERIA ASTURAO, S.C. - LUGO
BADO GITANA SETON/S.A.T. SERJA Nº 39018 - CANTABRIA
BADO OUTSIDE SANDRA/S.A.T. SERJA Nº 39018 - CANTABRIA
BARONCELLE ELEGANT PERLA/RATO, S.C. - PONTEVEDRA
BARREIRO ROUKI 738/S.A.T. CASA CARBALLO 1023 XUGA - LUGO
BELLO 58/BELLO - A CORUÑA
BLANCO LORES ET/GANDERIA BLANCO,S.L. - PONTEVEDRA
BLANCO SENSATION SENSITY/GANDERIA BLANCO,S.L. - PONTEVEDRA
BLANCOH. ATLAS LELY/GANDERIA BLANCO,S.L. - PONTEVEDRA
BLANCOH. INCOME VERONICA/GANDERIA BLANCO,S.L. - PONTEVEDRA
BLANCOV. 5385 SHOTTLE/BLANCO DE VILLALBA, S.C. - A CORUÑA
BOS BLANCO.H TOYST. SALVORA ET/GANDERIA BLANCO,S.L. - PONTEVEDRA
BOS CANDENDO BAXTER LUNA ET/GANAD. CANDENDO, S.C. - A CORUÑA
BOS CURRAS GOLDWYN ADRIANA ET/S.A.T. CREXAL - LUGO
BOS MAC ORCA ET/GANDERIA SINESIO, S.C. - A CORUÑA
BOS PERILLA SAHORTA 444 ET/S.A.T. PERILLA Nº 1031 XUGA - A CORUÑA
BOS SHOTTLE MIKAELA/CASA GABINO - LUGO
BOUDOIS BICOCA POWER/GANADERIA BOUDOIS, S.C. - ASTURIAS
BOUDOIS DORADA TAMARGO/GANADERIA BOUDOIS, S.C. - ASTURIAS
BOUDOIS INTRIGA DELAROSA/GANADERIA BOUDOIS, S.C. - ASTURIAS
BOURIO CHALANA KINGLY/FONTE DE BOURIO - ASTURIAS
BREA SHOTTLE NEVE/CASA GOMEZ DE BREA - A CORUÑA
BRIGITTE 1666/CASA CAPON - LUGO
BUSTO 7473 CHIP/VIRGEN DEL CAMINO, S.C. - A CORUÑA
C. 357 CHULA/S.A.T. EL CAMPON 8.833 - CANTABRIA
CABADO DARTER GEMA/CASA GIL, S.C. - LUGO
CABANA ROYAUME AGRARIA/S.A.T. LODOS E PEREZ N.940 XUGA - LUGO
CABANA SHOTTLE 852/S.A.T. CABANA - LUGO
CABANAS LETI DOLMAN/CABANAS - A CORUÑA
CABANAS RONALDA SANCHEZ ET/CABANAS - A CORUÑA
CABO AMAYA TALENT/CASA CABO - ASTURIAS
CACAHOUETT F9/MANDEO, S.C. - A CORUÑA
CAMINERO CHAMOSO 9133/CAMINERO, S.A.T. - LUGO
CAMPOGRANDE 6774 TANAM/CAMPOGRANDE-A PENA, S.C. - A CORUÑA
CAMPOS BOLTON MOURA/CAMPOS - LUGO
CANAL BOLTON 9157 ROJA/S.A.T. O CANAL - LUGO
CANAL TRONKO 5840/S.A.T. O CANAL - LUGO
CANEDA NANTA SANCHEZ/CASA CANEDA - A CORUÑA
CANEDA RUSINDA MR BURNS ROJA/CASA CANEDA - A CORUÑA
CANTON COQUETA CHICAGO/EL CANTON, S.C. - CANTABRIA
CANUTO XACOBEO FEXA/CANUTO - LUGO
CAPADOR TOYSTORY BLANCA/S.A.T. CAPADOR - LUGO
CAPILLAS FONTANS PINTA/VILARIÑO - PONTEVEDRA
CARBALLES AIRRAID NIEVES/CASABELLA CARBALLES, S.C. - LUGO
CARBALLO BLITZ MIMOSA 631/S.A.T. CASA CARBALLO 1023 XUGA - LUGO
CARBALLO WILDMAN PEGA 728/S.A.T. CASA CARBALLO 1023 XUGA - LUGO
CARMINA SUPPORT 9690/FERNANDEZ VIDAL - ASTURIAS
CAROCA GOLDWIN DANESA/LOPEZ-GALLEGO,S.C. - PONTEVEDRA
CARTEIRO 206 EMIR/GANDEIRIA CARTEIRO, S.C. - A CORUÑA
CASA NOVA AMBAR CHISPA/EXP.GAN.CASANOVA, S.C. - LUGO
CASA-NOVA CHATA MINISTER 773/CASA NOVA SAT. 1021 XUGA - A CORUÑA
CASAGRANDEL SALSA 9538/RATO, S.C. - PONTEVEDRA
CASANA BETANZOS 9813/CASANA, S.C. - LUGO
CASANOVA TALENT 6075/CASANOVA - LUGO
CASANOVA XACOBEO XACOBA/CASA NOVA, S.C. - LUGO
CASEIRODERNES PRONTO LOTTER ET/CASEIRO DE ERNES S.A.T. - LUGO
CASTELO MOES DIANA/CASTELO - LUGO
CASTIÑEIRAS OTILIA OUTSIDE/GAN. CASTIÑEIRAS DE OA, S.C. - A CORUÑA
CASTOR LANDOI 61/SALGADO BUIDE,S.C. - LUGO
CASTRO BOLTON 1022 CATALINA/CASTRO PAZ, S.C. - LUGO
CASTRO CLARA SHOTTLE/CASA CASTRO, S.C. - A CORUÑA
CASTRO FANIA TOYSTORY/CASA CASTRO, S.C. - A CORUÑA
CAZADOR PUMBA 0712/CASA CAZADOR,S.C. - PONTEVEDRA
CELA-ARCA DANCER BAILARINA/CASA QUINTEIRO - PONTEVEDRA
CELOUTA CHAMOSO NAR-XOSE/NAR-XOSE,SDAD.COOP.GALEGA - LUGO
CERRACIN 386 BIANKA LASSON/CERRACIN - LUGO
CHACO MARQUESA AUSTRAL 1900/CHAIN GANDEIRA,S.L. - LUGO
CHACO WISHBONE STEWARD 1938/CHAIN GANDEIRA,S.L. - LUGO
CHAO 0913 BOLTON/CHAO MEZONZO S.A.T. 1189 XUGA - A CORUÑA
CHAO 7204 BUCKEYE/CHAO MEZONZO S.A.T. 1189 XUGA - A CORUÑA
CHAVA LUCUS PARDA/S.A.T. MURADO ROMUALDO - LUGO
CHINELO TORREL 5545/CHINELO, C.B. - LUGO
CHUSCO TALENT LINDA/CHUSCO, S.C. - LUGO
CHUSCO TALENT TALIA/CASA CHUSCO - LUGO
CID BOLIVIA ROSI/GANDEIRIA CID, S.C. - LUGO
CID KITE QUINTANA/GANDEIRIA CID, S.C. - LUGO
CIERRON LINDA 30 GLEN/ELOY Y TERESA DE MIER, C.B. - CANTABRIA
CIERRON SICILIA TOBY/ELOY Y TERESA DE MIER, C.B. - CANTABRIA
CIERRON TVA GLEN/ELOY Y TERESA DE MIER, C.B. - CANTABRIA
CIUCENDE BLITZ 7926/AGROCIOCENDE, S.C. - A CORUÑA
CLARA/PENA - A CORUÑA
CONCHADOS STORM RULA/CONCHADOS, S.C. - LUGO
CONDE SATIRO NAOMI/S.A.T. OS FOROS - LUGO
CRESTA/GANADERIA MENOR, S.C. - ASTURIAS
CUDAÑA DUCHESS KINGLY/CUDAÑA - CANTABRIA
CUDAÑA EDURNE CALYPSO/CUDAÑA - CANTABRIA
CUDAÑA ESTHER BLITZ/CUDAÑA - CANTABRIA
CUDAÑA FANTASIA DUPLEX/CUDAÑA - CANTABRIA
CUDAÑA MALENA LARAMIE/CUDAÑA - CANTABRIA
CUDAÑA OLGA CALYPSO/CUDAÑA - CANTABRIA
CUDAÑA TUSKHOVA FINEST/CUDAÑA - CANTABRIA
CUDAÑA URSULA ARMSTEAD/CUDAÑA - CANTABRIA
DAKTARI/S.A.T. GANADERIA VILA DE SANTAIA - A CORUÑA
DARLINE 1764/GANDEIRIA MONTEMAYOR S.C.GALEGA - A CORUÑA
DELTA EMIR PEÑAENTERA/PEÑAENTERA, S.C. - CANTABRIA
DENOY 1792/DENOY, S.A. - A CORUÑA
DEVISE/FINCA RAPOSO, S.C. - A CORUÑA
DIAZ TOYSTORY ANISETE/GANADERIA DIAZ, S.C. - LUGO
DIXIE LEE AARON/GANDEIRIA ARMUCELA, S.C. - A CORUÑA
DOCAMPO DIVINO SORTE/DO CAMPO - LUGO
DOCILE 1381/MADARRO - LUGO
DOKTER WIJKE 893 4837 GRETA/CAMPO - LUGO
E CASHEMERE DRAMATIC SEÑUELA/S.A.T. LOS TANAGOS Nº 7243 - CANTABRIA
E. REECE SA MA SOYA/S.A.T. LOS TANAGOS Nº 7243 - CANTABRIA
E. ROY ZIDANE SEVILLA/S.A.T. LOS TANAGOS Nº 7243 - CANTABRIA
E. SANDY GARRISON HERMOSA/S.A.T. LOS TANAGOS Nº 7243 - CANTABRIA
E.C. VALIOSO PARIS/S.A.T. A VEREDA - LUGO
ECOSSE TORDA/RAMIL DE FRIOLFE,S.C. - LUGO
ECUME 181/CASA DE BOGA - A CORUÑA
EL PUMAR JANY BLITZ/EL PUMAR - A CORUÑA
ELANCE 116/CASA FERREIRO - ASTURIAS
ELILI/SAR, SAT 1388 XUGA - A CORUÑA
EPANOUIE/CASA CONDE - ASTURIAS
ESTEBANO SC DANCER MERCEDES/ESTEBANO, S.C. - LUGO
ESTEBANO TALENT KIKA/ESTEBANO, S.C. - LUGO
ETOILE 8107/FINCA MARISA - A CORUÑA
ETRILLE/SAT REGUEIRO BRANCO 1390 XUGA - A CORUÑA
F.M. V. 7188 BISBAL 1991/S.A.T. FAMILIA MARTINEZ - A CORUÑA
F.M. 0428 GOLDWYN 1057/S.A.T. FAMILIA MARTINEZ - A CORUÑA
FALCON BUCKEYE 1291/FALCON - LUGO
FARIÑEIRO EMPIRE MAJA/FARIÑEIRO S.A.T. Nº 1049 XUGA - LUGO
FELINE/CASA DE BOGA - A CORUÑA
FERREIRO TORRES 0091/FERREIRO - LUGO
FERRO MATSON MAXIMA/GANADERIA FERRO S.C. - LUGO
FERRO SHOTTLE 4893/GANADERIA FERRO S.C. - LUGO
FIOUQUEIRA CHAMOSO MADEIXA/CASA FIOUKEIRA - LUGO
FONDAL KEOPS SHOTTLE/S.A.T. 913 XUGA O FONDAL ABOI - A CORUÑA
FOROS SHOTTLE SORAYA/S.A.T. OS FOROS - LUGO
FREIRE NIEVE TALENT/FREIRE PEREZ, S.C. - A CORUÑA
G. Y G. CAPTIVATOR CAPTIVA/GOMEZ GONZALEZ, S.C. - LUGO
G.ARCA TALENT DORA ET/GANADERIA ARCA - PONTEVEDRA
G.DUBRA.S.C. 261/GANADERIA DUBRA, S.C. - A CORUÑA
GAIGO ELEGANT XUSTA/S.A.T. GAIGO XUGA 1074 - LUGO
GAINAS IGNITER 213/GANADERIA GAINAS - LUGO
GANADERIARAMOS BEADE MORA/GANADERIA RAMOS - PONTEVEDRA
GARCIA ELEGANT FEFRIGA/S.A.T. HERBON NUÑEZ - LUGO
GARCIA TALENT FATIMA/S.A.T. HERBON NUÑEZ - LUGO
GARCIA TALENT SAMBORA/S.A.T. HERBON NUÑEZ - LUGO
GARYMEN MAITE PEKECHU/S.A.T. GARYMEN - A CORUÑA
GESTOSO BOLTON CLARA/GANDERIA GESTOSO, S.C. - PONTEVEDRA
GESTOSO FIRE NEGRITA/GANDERIA GESTOSO, S.C. - PONTEVEDRA
GESTOSO GLINYE ARCA/GANDERIA GESTOSO, S.C. - PONTEVEDRA
GINSA/EL REBOLLO - CANTABRIA
GRACIANO FRIOL 9932/GRACIANO - LUGO
GRANDELO GOLDWYN ISABEL/GANADERIA GRANDELO - LUGO
GRC 537 GOLDWYN/LANDEIRA SDAD.COOP.GALEGA - A CORUÑA
GRC 568 SHOTTLE/LANDEIRA SDAD.COOP.GALEGA - A CORUÑA
GUEIMOLO VILAR R. AMERICA ROJA/CASA GUEIMOLO - LUGO
HENAR GOLIAT SILVA/RAIOLA, S.C. - LUGO
HENAR MONROI CAMINERA/RAIOLA, S.C. - LUGO
ILMA 7944/S.A.T. 828 ILMA-XUGA - A CORUÑA
ILMA 8951/S.A.T. 828 ILMA-XUGA - A CORUÑA
INDIRA DUPLEX/ROMANO - CANTABRIA
ISAAC BUCKEYE MORITA/ISAAC - LUGO
JAIME TALENT 311/S.A.T. EMILIO DO JAIME - LUGO
JELENA 11511/LOPEZ DE BUXAN,S.C. - A CORUÑA
KAFFEE/GRANXA VILARIÑO, S.A.T. 985 XUGA - A CORUÑA
KLEINE REIXA LYKRA DOLMAN ET/GRANJA REIJA - LUGO
KOOSJE 305 LUPE/GANADERIA CASTIÑEIRAS DE OA, S.C. - A CORUÑA
L.P. DORIS MAZINGER/GANADERIA QUINTANA - CANTABRIA
LA MESQUERIA JEEVES CHENOA/LA MESQUERIA, S.C. - CANTABRIA
LA RIA MAYA 402/SAT FINCA A CARBALLEIRA - LUGO
LA RIVA SIRIA SIRACUSA/LA FLOR - CANTABRIA
LADE 093 DUPLEX 4542/LADEIRO - A CORUÑA
LANDEIRA-OA PILITA CHAMPION/CASA LANDEIRA DE OA.S.C. - A CORUÑA
LARA/GANDEIRA POUSADOIRO, S.C. - A CORUÑA
LAURA LAUTAMIC A-289/SAR, SAT 1388 XUGA - A CORUÑA
LINA CHAMOSO AFRICA/LINA - LUGO
LINA ROY IRIA/LINA - LUGO
LLINDE BRESKA MR BURNS/S.A.T. CECEÑO - CANTABRIA
LODOS SHOTTLE ZAMIA/S.A.T. LODOS E PEREZ N.940 XUGA - LUGO
LOLA/FERREIRA FRAGA, S.C. - A CORUÑA
LOUREIROS MARINA SPIRTE/RIAL DE LOUREIROS - A CORUÑA
LOUREIROS RAIÑA AIRRAID/RIAL DE LOUREIROS - A CORUÑA
LOUREIROS SARA GOLDWYN/RIAL DE LOUREIROS - A CORUÑA
LOUSADA XACOBEO MARTA/LOUSADA S.A.T. 981 XUGA - LUGO
LUKY ATLAS PEÑAENTERA/PEÑAENTERA, S.C. - CANTABRIA
M. BERTA 3666 FBI/S.A.T. MIRAMAR N. 1008 - CANTABRIA
M. TRAMPE 3497 SPIRTE/S.A.T. MIRAMAR N. 1008 - CANTABRIA
MACARENA 7684/VILLAVERDE - A CORUÑA
MACHIÑO GOLDWYN 6661/CASA MACHIÑO - LUGO
MALENA/CASTRO, S.C. - A CORUÑA
MALLOS 106 NEMETON/MALLOS - A CORUÑA
MANDEO 127 SILVANA SHAKER/MANDEO, S.C. - A CORUÑA
MANEIRO 1270 GLEN/MANEIRO - A CORUÑA
MANEIRO 9083 BOLIVIA/MANEIRO - A CORUÑA
MANSILLA MARIELA CHAMOSO/MON. LANDEIRA NOYA Y OTRO, S.C. - A CORUÑA
MARTAVILAR STORMATIC ANGELINA/BERNARDEZ-VILAR,S.C. - PONTEVEDRA
MARTIN CHAMPION MACARENA/MARTIN - LUGO
MARTIN LEREZ PINA/MARTIN - LUGO
MARTIROSA PIRTA SPIRTE/MARTIÑO - A CORUÑA
MASCOTA MASCOL HF07/VITORIA DE VILALBA - A CORUÑA
MELCHORA MEGALONSO 9710/S.A.T. CASA CARBALLO 1023 XUGA - LUGO
MENOR MELANY/S.A.T. CASA MENOR 1017 XUGA - A CORUÑA
MEXICANA/CARMEN FERNANDEZ ROQUEÑO - CANTABRIA
MIKAELA 1470 JACKSON/GANADERIA DO MOURO,S.C. - A CORUÑA
MIRABELLA/PEREIRUGA (Mª JESUS MATO) - A CORUÑA
MIRAMONTES 193 DUPLEX/MIRAMONTES (A. MIRAMONTES F) - A CORUÑA
MIRAMONTES 245 BAXTER/MIRAMONTES (A. MIRAMONTES F) - A CORUÑA
MONASTEIRO CASHMERE MANOLA/SC GANADERIA MONASTERIO - LUGO
MOSQUEIRA SOFIA 4783/MOSQUEIRA - A CORUÑA
NAVE FINAL CUT ARIAZNA 3374/LA NAVE, S.C. - LUGO
NAVE FINAL CUT COLETA 7564/LA NAVE, S.C. - LUGO
NAVE GOLDWYN ADONIA 9944/LA NAVE, S.C. - LUGO
NAVE GOLDWYN GENIA 7921/LA NAVE, S.C. - LUGO
NAVE GOLDWYN GISELA 9359/LA NAVE, S.C. - LUGO
NAVE INTEGRITY MAURA 1416/LA NAVE, S.C. - LUGO
NOVA GOOD-BYE PERLA/S.A.T. MARGA - LUGO
O PEDREGAL VALIOSO BARBARA/GANADERIA O PEDREGAL, C.B. - LUGO
O SEIXO LUPITA XACOBEO/GANDEIRIA O SEIXO - A CORUÑA
O-BATALLA DULCERINA LOU/GANADERIA BATALLA, S.C. - A CORUÑA
O-BATALLA TARTA BLITZ/GANADERIA BATALLA, S.C. - A CORUÑA
OBRERA DEISY RAMPAGE ROJA/GANADERIA LA OBRA, S.C. - CANTABRIA
OCEJO CLARA ALMERIA/OCEJO - CANTABRIA
OLEA 6907/S.A.T. QUEITANO - LUGO
OSCASEIROS STORMATIC PERLA/OS CASEIROS - PONTEVEDRA
OTERO ARENTEIRO 9184/CASA DE OTERO - LUGO
OUTEIRO DARTER ANCORA/GANDERIA SINESIO, S.C. - A CORUÑA
OUTEIRO XACOBEO BETH/CASA GABINO - LUGO
P.E. TALENT AVELINA/S.A.T. A VEREDA - LUGO
PACO BUCKEYE BAMBI/CASA PACO - LUGO
PADRON 282 XACOBEO/GANDEIRA L.CORNES, S.C. - A CORUÑA
PALLON ELEGANT 9586/GANDEIRIA PALLON, S.C. - PONTEVEDRA
PAMELA/GANADERIA GARCIA - A CORUÑA
PAOLA SPIRTE/GANADERIA SANTA ANA, S.C. - CANTABRIA
PARRULO LINCE SERRANA/CASA PARRULO - LUGO
PEÑARA NOEMI AUDI/S.A.T. PEÑARA Nº9678 - CANTABRIA
PEDRAS ALBAS OUTSIDE PEPA/CASA REI DE PEDRAS ALBAS,S.C. - LUGO
PENA AIRRAID LANA ET/GANADERIA PENA - LUGO
PENA RAMPAGE BLITZ/GANADERIA PENA - LUGO
PENAQUENTE BONAIR ARCA/ESVI, S.C. - LUGO
PENAQUENTE TITANIC LENA/ESVI, S.C. - LUGO
PENDO ANDA AUDI/HNOS.SAÑUDO ARGUELLES, S.C. - CANTABRIA
PEREJIL MAROLA/GRANJA PEREJIL "EL MACHO" - CANTABRIA
PEREJIL TRENZA/GRANJA PEREJIL "EL MACHO" - CANTABRIA
PERILLA BRISA XACOBEO/S.A.T. PERILLA Nº 1031 XUGA - A CORUÑA
PIETJE 56/GANDEIRIA MEIXIDE, S.C. - A CORUÑA
PONDEROSA BAXTER JAVEA ET/PONDEROSA HOLSTEINS - LLEIDA
PONTELLO FONTANS PRINCESA/GANADERIA PONTELLO,S.C. - PONTEVEDRA
PORTAGANDARA BRIANNE 4003/S.A.T. A PORTAGANDARA - LUGO
PORTAGANDARA ROYAUME 0093/S.A.T. A PORTAGANDARA - LUGO
PORTELA RIVAS PRESTIGIO PALMER/PORTELA RIVAS, S.C. - LUGO
PORTO DANCER MIRLA/CASA DE PORTO - LUGO
POUPARIÑA PAVITA LHEROS/POUPARIÑA S.A.T. - LUGO
PROAS-DARRIBA XACOBEO PALMERA/G. PROAS DARRIBA, S.C-PONTEVEDRA
PUMAREGA MARAVILLA TARTARE/GANAD. LA PUMAREGA, S.C. - ASTURIAS
QUINTIAN ALEXAND. ALEXANDRA ET/QUINTIAN, S.C. - LUGO
R. CLARA BOTA BOLTON/RAMON DE CLARA - A CORUÑA
R. DUBAI PERLA/ELOISA NORIEGA SANCHEZ - CANTABRIA
R. TALON 615/GANADERIA LOS REMEDIOS, S.C. - CANTABRIA
RETO DIIR STEFI TALENT ET/FERVIZ - CANTABRIA
RIELO LEREZ JIMENA 6902/RIELO, S.C. - PONTEVEDRA
RIGUEIRO AIRRAID MONA/S.A.T. RIGUEIRO REY - LUGO
ROCHO FORD FORITA/ROCHO, S.C. - LUGO
RODRIGUEZ 418 BEST/RODRIGUEZ PAREDES, S.C. - A CORUÑA
ROIBO GOSPELL BATUKA/CASA DE ROIBO - LUGO
ROMAN SHOTTLE FANTASIA/S.A.T. CASA ROMAN - LUGO
ROSA BOTAFOGO BOTAFOGA/DIEGUEZ PAZ, S.C. - PONTEVEDRA
RUBEN BOLTON 137/GANADERIA RUBEN - LUGO
RUBIÑOS BUCKEYE 77 PATRICIA/RUBIÑOS, S.C. - LUGO
RUBIÑOS XACOBEO 114/RUBIÑOS, S.C. - LUGO
RULA/DEUS - A CORUÑA
SAAMIL LAUTAMIC CABANA/SAAMIL - A CORUÑA
SAAMIL SHOTTLE TOTY/SAAMIL - A CORUÑA
SAAMIL TALENT LENI Nº7463/SAAMIL - A CORUÑA
SALGUEIROS LARA SANCHEZ/SALGUEIROS - A CORUÑA
SAN RIAN LATINA GOLDWYN/SAN RIAN S.COOP.GALEGA - A CORUÑA
SAN RIAN RISUEÑA TALENT/SAN RIAN S.COOP.GALEGA - A CORUÑA
SAN RIAN 3828 TURCA STORMATIC/SAN RIAN S.COOP.GALEGA - A CORUÑA
SAN ROQUE TALENT 0497/VIDUANE, S.C. - OURENSE
SANCHEZ SC XACOBEO LUNA 7536/SANCHEZ, S.C. - LUGO
SANDA 09 TALENT/SANDA - A CORUÑA
SANDAMIL KINGLY SALENA/S.A.T. A VEREDA - LUGO
SANDIÑO ELEGANT 9644 DIAN/S.A.T. A PORTAGANDARA - LUGO
SANTA LEOCADIA NAVARRO 8055/SANTA LEOCADIA, S.C. - LUGO
SANTAYA LOU LARSA/FINCA SANTAYA S.A.T.1401 - PONTEVEDRA
SANTAYA ROY DEVORA/FINCA SANTAYA S.A.T.1401 - PONTEVEDRA
SANTO XACOBEO ARCA/SANTO, S.C. - LUGO
SANTOLAJA CHICAGO ANGELES/SANTOLAJA - CANTABRIA
SAT CASA CAETANO BUCKEYE IREA/DO SARGENTO - LUGO
SAT FERNANDO 701 LURDES GOLDWY/C. FERNANDO SAT.1122 XUGA-A CORUÑA
SATMARIÑO 557 BOLICHE/SAT.FINCA MARIÑO Nº1108 XUGA - A CORUÑA
SIÑEIRO FARTER DUBIA/SIÑEIRO, S.L. - LUGO
SILVELA PERDIDA CID/CASA SILVELA, S.C. - ASTURIAS
SILVESTRE CUBANA/GANDEIRIA SILVESTRE, S.C. - A CORUÑA
SOENGAS PEKECHU MIMINA/SOENGAS - PONTEVEDRA
SOUTO 121 BUCKEYE/SAR, SAT 1388 XUGA - A CORUÑA
SUBAIDA 241/GANDERIA BLANCO,S.L. - PONTEVEDRA
SUBAIDA 247/GANDERIA BLANCO,S.L. - PONTEVEDRA
T. JAYZ 0719/S.A.T. TESERNA - CANTABRIA
TAÑOI 0412/GANADERIA TAÑOI S.A.T. 1158 XUGA - A CORUÑA
TABOADES DARTER PALMA/CASA TABOADES - PONTEVEDRA
TALENTA 4486 TALENT/BLANCO DE VILLALBA, S.C. - A CORUÑA
TAROLO STORMATIC SIRENA 1162/CASA TAROLO - LUGO
TATO BONITA AARON/CASA DE TATO - A CORUÑA
TEIXEIRO MTOTO FONTES/S.A.T. TEIXEIRO - LUGO
TEJAR ANDREA TASIO/EL TEJAR - CANTABRIA
TEJAR TAMI GIBSON/EL TEJAR - CANTABRIA
TENDEIRO GOLDWYN 8872/TENDEIRO - LUGO
TOMASA JEFFERSON PITUSA/TOMASA - PONTEVEDRA
TOPPI 142 GOLDWYN/GANADERIA CORTIGUERA, S.C. - CANTABRIA
TROITIÑOS XACOBEO PITUFA/GARCIA CAMPOS - PONTEVEDRA
TULA/DEUS - A CORUÑA
V. AUDI 2972/VAZQUEZ, S.C. - CANTABRIA
V. DUPLEX 8159/VAZQUEZ, S.C. - CANTABRIA
VALCARCE CHAMOSO OLIVA 2093/GAND. VALCARCE, S.C. - LUGO
VALIÑOS AARON HORA/S.A.T. GANADERIA VALIÑOS - LUGO
VALIÑOS MAGOT COSITA/S.A.T. GANADERIA VALIÑOS - LUGO
VALIÑOS XACOBEO 4519 ALBA/S.A.T. GANADERIA VALIÑOS - LUGO
VARELA 0983 BOTAFOGO/FINCA VARELA, S.C. - A CORUÑA
VARELA 354 BOTAFOGO/FINCA VARELA, S.C. - A CORUÑA
VEIGUEIRO AFFIRMED FIRMA/VEIGUEIRO S.COOP.GALEGA - LUGO
VEIGUEIRO BOLIVIA NATACHA/VEIGUEIRO S.COOP.GALEGA - LUGO
VEIGUEIRO MATSON NEREA/VEIGUEIRO SDAD.COOP.GALEGA - LUGO
VEIGUEIRO XACOBEO XACOBEA/VEIGUEIRO S.COOP.GALEGA - LUGO
VIDUANE TALENT 8581/VIDUANE, S.C. - OURENSE

VIEITES CATUXA GOLDWYN/VIEITES - A CORUÑA
VIEITES MARICHULI MAGOT/VIEITES - A CORUÑA
VILARIÑO BOLTON CAMIONERA 496/G.VILARIÑO, SAT. 985 XUGA-A CORUÑA
VILARIÑO DRAC TAPIOCA 603/G. VILARIÑO, S.T. 985 XUGA-A CORUÑA
VILARIÑO GLEN NABA 580/G. VILARIÑO, S.A.T. 985 XUGA - A CORUÑA
VILAVERDE 7772/S.A.T. 876 XUGA VILAVERDE - A CORUÑA
XACINTO BAXTER ACACIA III ET/XACINTO, S.C. - LUGO
XACINTO XENIO VERO/XACINTO, S.C. - LUGO
XAN-BLANCO 5908 BOLTON/GANDEIRA XAN BLANCO S.C. - A CORUÑA
XEPE BOLIVIA ZEA/CASA XEPE - LUGO
XERCAS CAV JACA CALYPSO/CAVADAS S.A.T. XUGA 941 - LUGO
XERCAS CAV SANTA LAURIN/CAVADAS S.A.T. XUGA 941 - LUGO
XERCASPORTA GOLDWYN DORINA ET/PORTALOUSA - LUGO
XUSTO IRON LAURA/S.A.T. GANADERIA XUSTO - LUGO
XUSTO XACOBEO BEA/S.A.T. GANADERIA XUSTO - LUGO
YIN/GANADERIA DONO - A CORUÑA
12974 VIVIAN/MANATO - A CORUÑA
130-2239 MIMOSAS BOIMORTO/EIRA DAS MIMOSAS, S.C. - A CORUÑA

SEPTIEMBRE

Asturias, Cantabria, Álava, Guipúzcoa y Vizcaya
OCTUBRE
Cantabria, Navarra, Barcelona y Lleida

Resumen de Calificación por tipo 2013. Categorías:

NORMAS DE REGISTRO
Ganaderos
En el caso de los machos de monta natural nacidos a partir del 1 de enero de 2011, en el momento del registro, se deberá presentar la huella genética propia y su prueba de filiación (paternidad y maternidad) positiva. A este respecto, se recomienda sangrar la madre del ternero a registrar lo antes posible.
Se recuerda también que:
• La realización de las pruebas y el coste serán por cuenta del propietario.
• La extracción de las muestras de sangre será realizada por un veterinario y será necesario adjuntar un certificado de extracción para el laboratorio.
• Los marcadores que se han de analizar de forma obligato-
ria para determinar la prueba de filiación y la huella genética son: ETH10, ETH185, ETH225, ETH3, BM1818, BM1824, BM2113, SPS115, TGLA227, TGLA126, TGLA122, TGLA53, INRA005, INRA0063, INRA023, CSRM60, ILST006.
Las hijas de los toros que no cumplan los requisitos anteriores sólo podrán ser registradas en el Registro Auxiliar Categoría A, por lo que desde CONAFE se recomienda a los ganaderos socios del Libro Genealógico de la raza Frisona Española que se informen de la situación del registro de los toros a utilizar como sementales en su explotación. Esta información se puede obtener contactando con las Asociaciones/Federaciones Autonómicas, con CONAFE y a través de la página web de CONAFE.

A continuación aparecen los resultados del Control de Rendimiento Lechero del período 1 de enero-31 de diciembre de 2012 (datos recibidos hasta el 11 de mayo de 2013).
Estos datos son facilitados a CONAFE por los organismos oficiales responsables de la gestión del Control Lechero en cada Comunidad Autónoma,
Se recoge la información de la totalidad de las vacas que han finalizado la lactación en el período de referencia, con más de 240 días de duración
Según estos datos, el número total de lactaciones finalizadas en este periodo es ligeramente inferior al registrado el año pasado (347.317 frente a las 350.610 correspondientes a 2012). La cantidad de
lactaciones cerradas ha disminuido en todas las Comunidades Autónomas salvo en Andalucía, Cataluña, Galicia y Aragón.
En cuanto al número de primeras lactaciones finalizadas, encabeza el ranking Galicia, con 46.373, seguida por Asturias, con 12.630.
Respecto a la media de kg de leche en todas las lactaciones a 305 días, la media nacional ha aumentado en 103 kg en comparación a 2012. La Comunidad con mayor producción ha sido un año más Aragón, con 11.250 kg, seguida de nuevo por la Comunidad Valenciana, con 11.005 kg. En cuanto a provincias, también repite Huesca como mayor productora, con una media de 11.668 kg.









FREDDIE x PLANET x RAMOS

VEKIS CHEVROLET ET
CHEVROLET COMBINA PERFECTAMENTE CON EL TIPO DE VACA QUE EL GANADERO ACTUAL REQUIERE PARA SU REBAÑO, ALTA PRODUCCIÓN Y EXCELENTES RASGOS DE SALUD Y LONGEVIDAD, ADEMÁS DE UN PEDRIGÍ MUY ATRACTIVO.

2.253 LB. LECHE Y 74 LB PROT.
846 MÉRITO NETO
106 RECUENTO CELULAR
104 SALUD DE UBRES
784 LONGEVIDAD
2,12 TIPO 1,84 UBRE 1,72 PATAS

ABUELA DE CHEVROLET Larcrest Crimson
Introducción
El Resumen Anual del Control de Rendimiento Lechero ha sido elaborado por la Federación Frisona de Cataluña (FEFRIC) con la colaboración del Departamento de Agricultura, Ganadería, Pesca, Alimentación y Medio Ambiente (DAAM) de la Generalitat de Cataluña.
Los resultados se presentan a nivel de Explotación, Asociación y Cataluña en dos partes diferenciadas.
La primera parte (estructura, fertilidad y producción) se obtiene procesando los datos de las vacas (54.873, 4,7% más que en el 2011), que han tenido alguna incidencia o movimiento en el periodo 1 de enero 31 de diciembre de 2012. La segunda parte contine los resultados medios de 33.570 lactaciones finalitzadas (> 240 días) en el año 2012 de las que 12.279 (36,6%) són primeras lactaciones.
Estos datos provienen de las explotaciones que no han iniciado o cesado su actividad en el control lechero en 2010.

El número total de lactaciones acabadas ha sido de 40.815 (6,4% más que en el 2011). Un 14,7% de las lactaciones no llega a los 240 días (34.814 lactaciones normalizadas).
Resaltar en esta introducción los datos más importantes de la producción en 2012 respecto a 2011: el número de vacas presentes y la producción total por explotación media de Cataluña se ha incrementado un 3,9% y un 6,5% respectivamente. Los Kg. de leche por vaca presente y día han pasado de 26,8 Kg. a 27,1 Kg (incremento del 1,7%) y por día de lactación de 30,5 Kg a 31,1Kg. El % de grasa ha pasado del 3,60% al 3,63% y el de proteína del 3,27% al 3,30%.
Como resumen cabe decir que los kg de leche totales por explotación y por vaca presente aumentan considerablemente. El % de grasa por décimoaño consecutivo está por debajo del 3’7% y aunque con oscilaciones, se confirma la tendencia a la baja, hacía el 3’6%. El porcentaje de proteïna que en en el periodolo del 1998 al 2006 se manteniçia en el 3’2% y que en los últimos años llegó al 3.25%, manteniendose sobre el 3,30% en res últimos años.
En el Cuadro 1 se presenta la evolución de los diez últimos años del número de explotaciones y de vacas en Control Lechero.
Análisis de Resultados
Se han procesado 315 explotaciones que han tenido una media de 133,4 vacas.
Durante el año 2012 y por explotación media de Cataluña el número de vacas dadas de alta ha sido de 45 (33,7%) y las bajas 42 (31,5%) (+2,2%). La evolución de la explotación media en 2012 en las asociaciones ha sido el siguiente:
A.V.Girona crece el 7’5%, A.F.Terres de Ponent, A.F.Urgell y A.F.Noguera junto al 5%, A.F. Osona (2’7%), A.F.Alt Urgell i Cerdanya (1%). A.F.de Girona se mantine, A.F.Vallès y A.F.Vaquers del Berguedà disminuyen ligeramente y A.F.Pallars (-17%).
El número de vacas siempre presentes ha sido del 51% y se corresponde con la baja edad de las vacas del rebaño medio de Cataluña (55 meses) y con número bajo de media de lactaciones 2,44.
De 1990 a1997 la edad y el número medio de lactación han sido bajos, situándose en torno a los 65 meses y 3,0,
disminuyendo en 6 meses y 0,4 lactaciones en los años 98-99-00 (años en los que se inicia el recunto celular para el pago de la leche). En los años 01-0203 el número de lactaciones se mantiene cerca del 2,6, la edad en 58-57 meses y el % de reposición en

el 27-29% (exceptuando el 2001, 23%, por motivos especiales: EEB). Los últimos siete años el número de lactaciones se sitúa alrededor del 2,5 y la edad media en 56-57 meses. En 2012 ha disminuido sensiblemente. El porcentaje de reposición que estaba en torno del 30% se situa en el 31,5%.
Fertilidad
El intervalo medio entre partos ha sido de 422 días lo que significa un intervalo parto-fecundación de 137 días y un 32,5% teórico de vacas no gestantes. El porcentaje medio de días improductivos o bien el de vacas secas, ha sido del 16,4% y la dura-
ción de la lactación media ha sido de 353 días.
El valor del intervalo entre partos y del periodo seco se calcula para las vacas que han tenido partos en el año analizado y por tanto el valor calculado puede diferir del real de las explotaciones.
Se ha de intentar reducir el intervalo entre partos, mejorando ciertos aspectos del manejo (detección de celos y alimentación de acuerdo al potencial productivo) y también aumentando el nivel genético del rebaño, ya que el incremento de la duración de la lactación no está a favor de la eficacia productiva.
Producción
La evolución de la producción media de cataluña en el periodo 2002-2012 está detallada en el Cuadro 2.
Lactaciones finalizades (305 días)(duración ≥ 240 días) (período 2002 – 2012):

La evolución de las primeras lactaciones normalizadas a 305 días y del total de las lactaciones 2002-2012 aparecen en el Cuadro 3.
El número de lactaciones analizadas en el Cuadro 3 se detalla en el Cuadro 4. Las lactaciones procesadas en el Resumen Anual pertenecen a explotaciones que no se han dado de alta o baja en el año analizado.
15 mejores ganaderías por IGP (nov-2012)
IGP= 0,4 ICO/DT ICO + 0,6 IF/DT IF •DTICO =193,99•DT IF = 1,41
Listado de Asociaciones 2012 Aplicando las mejores condiciones para la clasificación de las explotaciones, el índice conómico de las asociaciones es el siguiente
MEJOR TORO PROBADO EN ITALIA (PFT Italy)
MEJOR TORO PROBADO POR LPI (Canadá)
MEJOR HIJO DE BOLTON LIBRE DE BRACHYSPINA (TPI USA)
“ En 2012 Mascalese ha sido utilizado sobre las vacas más importantes de la Raza y, aún incluso antes de nacer, sus hijas han alcanzado los más altos precios en las subastas de todo el mundo. Gracias a todos los criadores Holstein por su entusiasmo”



Soy un ganadero de Castilla y León que tiene una alta tasa anual de abortos desde hace varios años debido a la neosporosis. ¿Cómo puedo controlar esta enfermedad en mi granja?
Responden: Silvia Rojo Montejoa y Luis M. Ortega Morab - ANEMBE
La neosporosis bovina está considerada como una de las principales causas de aborto en el ganado bovino a nivel mundial, originando importantes pérdidas económicas. En la cabaña bovina

el ganado bovino puede adquirir la infección vertical y horizontalmente. La transmisión vertical transplacentaria de N. caninum de la madre al feto durante la gestación es el modo de transmisión predominante de la infección, jugando un papel relevante en la propagación y mantenimiento de la enfermedad en un rebaño. Muchas granjas mantienen una tasa de prevalencia más o menos constante a lo largo de los años con una correlación casi perfecta entre la seropositividad de las madres y sus terneros, sin que exista una aparente fuente externa de infección. El otro modo de transmisión de importancia en la neosporosis bovina es el horizontal. Se produce tras la ingestión por parte del ganado de alimento o el agua contaminados con heces de perros u otros posibles hospedadores definitivos potenciales (hasta ahora sólo cánidos domésticos y silvestres). Aunque su presentación es menos frecuente, sus repercusiones clínicas y económicas pueden ser enormes. Con frecuencia, cuando aparece esta contaminación externa, una proporción elevada del rebaño se infecta por primera vez en poco tiempo, traduciéndose en un brote de abortos.
a Sistemas de Producción Animal, Servicio Regional de Investigación y Desarrollo Agroalimentario del Principado de Asturias (SERIDA).
b Grupo SALUVET. Dpto. de Sanidad Animal, Facultad de Veterinaria, Universidad Complutense de Madrid.
Pese a su gran repercusión, no existe ningún tratamiento ni vacuna en el mercado, de manera que, hasta la fecha, la única herramienta disponible es la aplicación de medidas de manejo del rebaño. En muchas situaciones, sin embargo, la aplicación de las medidas adecuadas resulta económicamente inviable. Por ello, el programa de control debe llevarse a cabo “a medida” para cada explotación, incorporando un análisis costebeneficio, teniendo en cuenta los costes que supone la puesta en marcha de las medidas de control frente al beneficio de reducir las pérdidas económicas que ocasiona la enfermedad.
En todos los casos, el diseño de un programa de control frente a la neosporosis debe seguir los siguientes pasos:
1.Conocimiento de la situación inicial de la granja
El punto de partida en cualquier programa de control es conocer la situación inicial de la infección en la granja. En la práctica, se emplean técnicas serológicas convencionales para la detección de anticuerpos específicos frente a N. caninum en muestras de suero. Los resultados obtenidos aportarán información sobre la seroprevalencia en la explotación y la seroprevalencia en las vacas abortadas, indicando la magnitud del problema y si éste es debido a la infección por N. caninum. Además, podremos obtener información de la relación entre la serología materna y la de su descendencia, así como la distribución de los animales seropositivos por edades, lo que nos orientará sobre el modo de transmisión de la infección predominante en esa granja (vertical u horizontal). Esta información es relevante ya que de ello dependen las consecuencias clínicas y económicas de la infección y, por tanto, las medidas de control a adoptar en cada caso.
2.Puesta en marcha del programa de control
Una vez conocida la situación epidemiológica pasaremos a decidir qué medidas son las más apropiadas. A continuación se describen brevemente las diferentes opciones de control de las que disponemos en la actualidad así como las nuevas alternativas que podrían utilizarse en un futuro (Figura 1).

2.1. ¿Cómo podemos prevenir la entrada de la infección en la granja?
Las siguientes medidas de bioseguridad básica van dirigidas a evitar la entrada de la infección en la granja:
•Diagnóstico serológico de los animales antes de la compra y adquisición sólo de los que presenten resultados negativos a la prueba.
•Control de la transmisión horizontal en granjas libres de la infección mediante el seguimiento serológico de los animales con el fin de detectar y eliminar nuevos casos, y la adopción de medidas para evitar la infección postnatal, como se explica en el apartado 2.3.


Prevenir la infección
Prevenir la infección
Reposición con animales negativos
Control de la transmisión horizontal

Seroprevalencia baja
Tasa de abortos alta
Eliminación gradual de vacas seropositivas o con cruce cárnico


Explotación infectada




Control de la transmisión vertical
Reducir el número de reproductoras positivas

Control de la transmisión horizontal
Control de los perros
Evitar contaminación de alimentos y agua con heces de perros
Retirada inmediata de placenta y fetos abortados
Seroprevalencia alta

Eliminación gradual de vacas seropositivas:
-con antecedentes de aborto -con terneros positivos
Cruce cárnico
Transferencia de embriones en vacas de alto valor genético
Evitar la entrada de nuevos casos mediante el control de la reposición
Interna: serología precalostral negativa y madres negativas
Externa: serología negativa

hembras seropositivas.
•La transferencia de embriones de hembras infectadas a no infectadas, sobre todo en el caso de reproductoras de alto valor genético, también ayuda a obtener reposición libre de la infección.
2.3. ¿Cómo podemos evitar que los animales que hayan nacido libres de la infección se infecten tras el nacimiento?
En este caso, lo que debemos es incluir medidas de manejo para controlar la transmisión horizontal en el rebaño, entre las que se encontrarían las siguientes:
•Evitar que el perro y otros posibles hospedadores definitivos potenciales contaminen con sus heces el agua, pienso y forraje.
•Eliminación segura de tejidos fetales y placentarios, evitando su consumo por el perro.
•Aplicar medidas de desratización. Los roedores se han sugerido como posibles reservorios de la infección (aún sin confirmar).
2.4. ¿Qué papel juega la vacunación en el control de la neosporosis?
2.2. ¿Cómo podemos evitar la transmisión de la infección de madres a hijas?
Las medidas encaminadas a evitar la transmisión vertical constituyen una de las bases del control de la neosporosis. Dichas medidas se describen a continuación:
•Control rutinario de la reposición, que engloba la adquisición de animales libres de la infección, o en el caso de hacer reposición interna, diagnóstico de las hembras nacidas en la granja y selección para la renovación sólo de aquellos animales negativos.
•Prevención de potenciales factores que pudieran alterar el balance inmunológico durante la gestación favoreciendo una recrudescencia en vacas congénitamente infectadas.
•Diagnóstico y sacrificio selectivo, encaminado a la reducción/eliminación de la infección en las explotaciones. La selección de una estrategia u otra depende de la seroprevalencia en la granja y su instauración puede hacerse de dos formas: drásticamente, eliminando todas las vacas seropositivas, o gradualmente. Si la seroprevalencia es baja puede ser factible la eliminación gradual de las vacas positivas pero si ésta es elevada es muy probable que la eliminación de los animales seropositivos no sea una medida realista económicamente y debamos actuar siguiendo pautas más conservadoras. En esta estrategia cabe destacar las siguientes opciones: (a) la eliminación de vacas seropositivas o seropositivas con antecedentes de aborto, (b) inseminación de vacas seropositivas con semen de toros de aptitud cárnica y (c) evitar la reposición con crías de

Actualmente no existe ninguna vacuna frente a la neosporosis en el mercado. Hasta la fecha, únicamente se ha comercializado una vacuna inactivada en América y Oceanía, llamada NeoGuard®. Dicha vacuna, actualmente retirada del mercado, mostró una baja eficacia en la prevención de abortos. Sin embargo, varios estudios indican que, en rebaños con elevada prevalencia de la infección, aún cuando los niveles de protección de la vacuna frente al aborto no alcanzaran el 50%, vacunar es más rentable que realizar diagnóstico y sacrificio de los animales positivos. De manera que la vacunación es una de las principales alternativas de futuro para el control de la enfermedad.
A nivel experimental, los resultados más prometedores de protección frente al aborto se han observado con el empleo de vacunas vivas atenuadas. Un ejemplo es el aislado de origen español Nc-Spain 1H que, tras varios ensayos tanto en animales de laboratorio como en ganado bovino, demostró ser seguro y eficaz, considerándose un buen candidato para el desarrollo futuro de una vacuna viva atenuada. Sin embargo, la eficacia de estas formulaciones parece limitada en condiciones de infección natural.

Dada la ausencia de vacunas eficaces y seguras, la comunidad científica sigue trabajando intensamente en este campo, ya que la obtención y comercialización de una vacuna frente a la infección por N. caninum proveería al sector bovino de una potente herramienta para el control de la enfermedad.






ANEMBE y Frisona Española colaboran en este foro informativo que pretende ser la sección ANEMBE RESPONDE. Aquí tienen cabida las preguntas que normalmente se plantean al veterinario en su actuación cotidiana en el campo.


Aquellos ganaderos interesados en plantear cuestiones, las pueden enviar a la redacción de la revista Frisona Española. Desde aquí se trasmitirán a ANEMBE que las dirigirá a profesionales de prestigio de las diferentes áreas de la clínica y producción bovina y cuyas respuestas se publicarán en estas páginas.

En el presente artículo vamos a tratar un tema de actualidad que afecta a miles de personas que han firmado contratos de hipoteca con entidades bancarias. Pues bien, nos estamos refiriendo a las denominadas “cláusulas suelo”.
Para abordar el tema, en primer lugar vamos a tratar de definir de la manera más clara y concisa, qué es una “cláusula suelo” y en qué repercuten a los préstamos hipotecarios en los que se integran.
Pues bien, son cláusulas que se incluyen en un contrato de préstamo hipotecario y que establecen cuál será el tipo mínimo de interés que tendrá que abonarse en cada cuota de la hipoteca. A la cláusula suelo también se le llama cláusula de invariabilidad o de interés mínimo, puesto que lo que fija es el porcentaje mínimo de interés que se aplicará a las cuotas que el prestatario (“hipotecado”) tenga que pagar.
La mayor parte de las hipotecas contratadas en España utilizan como índice de referencia el conocido Euribor (el tipo de interés que paga como precio un banco cuando otro le presta dinero) más un diferencial (0,25; 0,50; 0,75; 1,25, etc).
Sin embargo, las cláusulas suelo son aquellas que determinan que dicho índice de Euribor más un diferencial no podrá ser nunca inferior a lo que en la cláusula se establezca, es decir, y por poner un ejemplo práctico, si dicho indice es del 1,5 % y la cláusula suelo es del 2 % entrará en juego la cláusula suelo, saliendo por tanto perjudicado el hipotecado.
Además, dichas cláusulas suelo, en muchas ocasiones han ido acompañadas de las conocidas

Por ello, es obvio que existe una profunda desigualdad entre las partes contratantes de un préstamo hipotecario que incluya las citadas cláusulas puesto que, al respecto, se ve siempre perjudicado el consumidor.
Tal es así, que ante tal evidencia, han sido múltiples las reclamaciones frente a las entidades bancarias a fin de eliminar las cláusulas
Como consecuencia de dichas reclamaciones han tenido lugar sentencias pioneras en la materia (Juzgado de lo mercantil nº 2 de Sevilla de 30 de septiembre de 2010) que declaran la nulidad de las cláusulas suelo dejándolas sin efecto e incluso condenando a entidades bancarias a la devolución de las cantidades indebidamente cobradas por la aplicación de dichas cláusulas.
De acuerdo con la reciente jurisprudencia, no todas las cláusulas suelo son abusivas y por tanto susceptibles de ser anuladas, sino que para ello se exige una serie de requisitos:
1º.- Que la cláusula no haya sido negociada individualmente.
2º.- Que la actuación de la entidad bancaria sea contraria a la buena fe.
3º.- Que la cláusula ocasione un desequilibrio entre los derechos y obligaciones de las partes que firman la hipoteca.
El primero de los requisitos se entiende cumplido en una gran mayoría de los casos en los que el banco redacta el contrato de préstamo hipotecario sin dar posibilidad al prestatario a modificar cláusula alguna, e imponiendo las condiciones de la misma, es decir, que el hipotecado tan sólo haya tenido la opción de adherirse al contrato.
El segundo de ellos se entenderá cumplido cuando la entidad bancaria actúe en contra de las buenas prácticas y diligencia debida, por ejemplo ofreciendo el préstamo sin explicar al detalle las condiciones del mismo.
Por último, el tercero de los requisitos menciona el término desequilibrio, es decir, que en conjunto salga más beneficiada la entidad bancaria que el usuario del préstamo.
El pasado día 9 de mayo de 2013 el Pleno del Tribunal Supremo mediante Sentencia nº 241/2013 declaró la nulidad de las cláusulas suelo por la falta de información suficientemente clara facilitada a los usuarios por las entidades bancarias, entiende el alto Tribunal que las cláusulas suelo no son suficientemente claras y además las considera desequilibradas dada la desproporción entre las mencionadas cláusulas suelo y las cláusulas techo.
No obstante lo anterior, dicha sentencia del Tribunal Supremo ha sido recurrida por entidades bancarias tales como BBVA y CAJAMAR, por lo que aún con todo esto aún se debe actuar con cautela en dicha materia puesto que si bien es cierto que a día de hoy la jurisprudencia es favorable al consumidor, en un futuro no muy lejano puede que no sea así.
PRODUCCIÓN
Proteína
Grasa
Proteína (‰) - 0,9
Grasa (‰) - 2,1
Leche

(Shottle x O-Man x MR Schips)
Equilibrio en Producción y Tipo Excelentes funcionales Alta fertilidad Ideal para novillas
Fiabilidad producción: 95
Hijas: 225
Rebaños: 181
Fecha: 13/06/2013
Fiabilidad tipo: 94
: 134
Rebaños : 109
Pruebas Francia junio 2013 RASGOS
Longevidad +1,7
Células somáticas +2,7
Síntesis fertilidad +0,7
Velocidad de ordeño - 0,3
Temperamento +1,2
Facilidad de parto 91 “fácil”
Hasta hace poco se hablaba en las granjas de micotoxinas y del efecto de estas sobre la producción y reproducción. Casi como un cajón de sastre donde cuando no se encontraba una razón para una baja producción o a problemas inespecíficos de salud del rebaño o de la reproducción se asociaba sistemáticamente con micotoxinas. Ahora debemos hablar también de micotoxinas y de su detección en leche. En el caso de la aflatoxina M1, su capacidad carcinogénica (es decir, su capacidad para producir cáncer) hace que exista un límite legal por encima del cual la leche no debe ser comercializada y sí destruida.
¿Qué son las micotoxinas?
Micotoxina viene de las palabras griegas mykes (hongos) y toksicons (venenos). Las micotoxinas son metabolitos producidos por hongos que pueden alterar el crecimiento y desarrollo de los rumiantes. Son producidas en el campo, en el momento de cosechar, en el transporte, almacenamiento, conservación o procesamiento de ciertos alimentos.
Existen más de 300 detectadas en forrajes y granos. Más del 25% de los granos a nivel mundial se encuentran contaminados por una o varias micoto-
duración del consumo.
No hay una sola zona en el mundo que no se vea afectada por estas toxinas.
La presencia del hongo no implica la presencia de micotoxinas puesto que más allá de la capacidad genética del hongo, es necesario ciertas condiciones para que el hongo produzca la micotoxina: se producen al final de la fase exponencial o al principio de la fase estacionaria del crecimiento.
En el campo se dan en años secos y se agrava en situaciones de lluvia e insectos; en el almacenamiento, por humedad y duración del almacenamiento. Los granos partidos son más propensos a contaminarse.
¿Qué efecto producen las micotoxinas?
Los efectos sobre el ganado son diferentes según cada micotoxina.
Así las aflatoxinas son sustancias tóxicas, mutagénicas y carcinogénicas producidas por Aspergillus

Las principales son: aflatoxina, ocratoxina y ze-
María Martín Richard. ASPROLAC maria@asprolac.comSe encuentran en cualquier parte del mundo ya que el Aspergillus flavus crece a 25ºC y 70% de humedad. Entre los alimentos en los que se desarrolla está el maíz, avena, cebada, trigo, arroz. Las 4 principales son la B1, B2, G1 y G2. Entre las diferentes aflatoxinas, la más tóxica es la B1 y está asociada a la aparición de cáncer de hígado. En general reducen el crecimiento y aumentan las necesidades de proteína en la dieta.
La aflatoxina B es absorbida por el aparato digestivo y metabolizada en hígado en aflatoxina M que pasa a la leche. Es importante su detección en leche por su carácter carcinogénico y evitar que entre en la cadena alimentaria humana.
Produce bajada de producción, inmunosupresión y carcinogenia. La aflatoxina B1 se transfiere a la leche en forma de aflatoxina M1 en la tasa de 65 partes para 1. Es decir, si tenemos en la ración 65 ppb de aflatoxina , en la leche tendremos 1 ppb de aflatoxina M1. Otros lo calculan al 1,7% de la concentración de la toxina en la ración (entre el 0,8 y 2%)
En la Comunidad Europea se admite solo 0,05 ppb en leche y en piensos para ganado lechero 0.005ppm (0.01 ppm para terneros)..
La FDA limita la concentración de B1 a no más de 20 ppb y de M1 a menos de 0,5 ppb (o 500 ppt). Los residuos de M1 se aprecian en leche entre 6 y 24 horas después de la ingestión de la B1.La ventaja es que al retirar el alimento contaminado, en 3 días no habrá rastro de esta toxina.
-La ocratoxina A se degrada rápidamente en rumen por lo que su efecto se limita solo a animales muy jóvenes. Es un contaminante natu-
ral de cereales sobre todo cebada y arroz. Afectan al hígado y riñón y su efecto es inmunosupresor.
-La vomitoxina produce una disminución de la ingesta de alimentos, bajada de producción y aumento del recuento celular.
-La zearalenona es producida por hongos fusarium que contaminan el maíz, la cebada, avena, trigo y arroz. Produce infertilidad, aumento de tamaño de glándula mamaria, disminución de la producción láctea y vaginitis. La zearalenona y sus derivados tiene baja toxicidad por lo que no causa daños severos pero sus efectos estrogénicos y anabólicos causan efectos muy fuertes sobre la reproducción: abortos, disminución de la viabilidad fetal. En vacas productoras, la ración final con dosis de 250 ppb puede provocar problemas estrogénicos, abortos, disminución del consumo y de la producción, deficiencias en reproducción y aumento del tamaño de ubres en novillas no preñadas.
Los tricotecenos tienen efecto letal a dosis alta. La presencia de T2 afecta al consumo de alimentos (aumenta el rechazo), bajada de la producción lechera, gastroenteritis, hemorragias intestinales y muerte.
Aunque un rumiante puede morir por causa de las micotoxinas, es más importante el efecto subclínico: problemas reproductivos, producción errática de leche, reducción de consumo de alimentos, aumento de células somáticas, inmunosupresión, aumento del daño hepático, etc. Esto se produce porque la detoxificación en el rumen se produce de forma parcial y porque en ocasiones, los metabolitos producidos son aún más tóxicos que la toxina original.
Es importante saber que muchas veces existen más de una micotoxina en los alimentos y que juntas pueden potenciar sus efectos.
¿Cómo se pueden medir?
Otro punto es la dificultad de detección de las
Fig 1: Efectos de las micotoxinas.

micotoxinas. Por un lado, la distribución de las mismas no es uniforme. Por otro, la presencia de hongos no indica obligatoriamente la presencia de micotoxinas y al contrario, la ausencia de hongos no implica la ausencia de micotoxinas, ya que aunque el hongo muere, las micotoxinas persisten.
Aflatoxinas totales
D.O.N. (vomitoxina)
Zearalenona
Toxina T-2
25 ppb
250 ppb
250 ppb
100 ppb
Fumonisina 20.000 ppb
¿Qué niveles son preocupantes
Sin embargo en el campo se aprecian problemas con dosis más bajas. Las dosis anteriormente mencionadas son en casos de encontrar una sola, lo que es relativamente raro. Y se debe incidir en la capacidad sinérgica, es decir que al encontrar 2 o más, estas potencian su capacidad tóxica. Además, existen en los animales otros factores que hacen que las dosis necesarias no sean tan altas como factores estresantes o enfermedades inmunosupresoras o simplemente una vacunación (es-
Para introducción y venta de productos para vacunos de leche y para destete y engorde.
Programas de nutrición para Novillas, Terneros y Vacuno Lechero.
Gama de alta calidad reconocida en el mercado Nacional e Internacional.


Productos iniciadores. Núcleos, Correctores y Formulación.

-imposibilidad de sacar el aire en el almacenamiento de silos.
Se debe tener en cuenta el tratamiento del producto. En el caso de los DDG (destilados de maíz) contienen 3 veces más micotoxinas que el maíz
trés por vacunación).
Por lo tanto se requiere una buena toma de muestras, que sea representativa y que el laboratorio haga una buena detección de las toxinas más importantes.
En leche se puede detectar la aflatoxina M1 de diversas formas como cromatografía (HPLC, TLC), Elisa o Inmunoensayo de flujo. Existen ya en el mercado sistemas rápidos (resultados en unos 5-10 mn) muy parecidos a los de detección de antibióticos en leche.
¿Cómo se pueden controlar?
El control es en primer lugar evitar la formación del hongo tanto en los cultivos como en los silos: evitar quebrar el maíz antes de lluvias, evitar la espera de camiones para hacer silos, mejorar la compactación de los mismos, utilización de inoculantes para bajar el pH, evitar entrada de aire.
En el caso del maíz, los mayores factores de riesgo son:
-humedad elevada durante su crecimiento y desarrollo
-sequía y alta temperaturas durante la maduración del grano
-insectos y otros mecanismos físicos que alte-
El uso de agentes fungistáticos: como el ácido propiónico es muy efectivo contra los hongos pero no contra levaduras o bacterias. Se puede usar pero debido al olor es preferible sus sales. También la sal común actúa como fungistático, es decir impide su crecimiento pero no es fungicida (no lo mata). Pero si ya existen las micotoxinas en los alimentos, los fungistáticos no actuaran sobre ellas. Los fungicidas actúan sobre la membrana del hongo y acaban destruyéndolo. Es el caso del formaldehído, de pesticidas y herbicidas. Pero no se pueden utilizar directamente en los alimentos para animales por sus efectos tóxicos que pueden alterar la salud del animal.
Pero como es imposible conseguir que todas las materias estén libres de micotoxinas, se deben utilizar secuestrantes. Son sustancias inertes capaz de fijar a su superficie la micotoxina que se mezclan con el alimento y salen del organismo vía heces. El adsorbente evita que la micotoxina sea absorbida por el animal y evita así el efecto tóxico. En el mercado existen varios tipos con varias calidades. Se deben valorar su espectro de acción, su capacidad de adsorción, su calidad y su respaldo tecnológico.
Existen diversos tipos en el mercado: arcillas, arcillas modificadas, bacterias productoras de enzimas específicas o a base de pared celular de levaduras. En cualquier caso deben venir avalados por estudios técnicos.
La prevención de micotoxinas en los silos de maíz incluye prácticas como mejorar la fermentación y eliminar el oxígeno así como mejorar la limpieza de los silos antes de agregar nuevos alimentos. La conservación de subproductos debe ser siempre bajo techo, promover la rotación de inventarios, drenar los lixiviados.

Así pues un fungistático eficaz que impide el desarrollo del hongo y un secuestrante de micotoxinas son 2 productos que se complementan para el control de las micotoxinas en la alimentación ani-


En aquella ocasión habíamos acudido a la granja, una de las granjas más reconocidas de la región con unas 250 vacas en ordeño, por un increíble problema de cojeras. Y curiosamente, lo hacíamos de la mano de la empresa de correctores que

El problema no apareció de repente, sino que fue progresivo, pero cada vez que se tomaba una nueva medida profiláctica o terapéutica la cosa empeoraba. Decidieron explorar todos los días a todas las vacas recién paridas, a las enfermas y a las convalecientes. Y se les aplicaba una cantidad enorme de tratamientos, tanto terapéuticos como preventivos: anticetósicos, vitaminas, antibióticos, vacunas, etc. Además se hicieron corrales de preparto, parto, posparto y enfermería; y las vacas iban y venían de unos corrales a otros de forma continua dependiendo de si se las veía mejor o no. El veterinario visitaba la granja todos los días y, casi también a diario, el casquero.
Ganadero y veterinario pensaban: “Si hacemos todo lo que se puede y más desde el punto de vista médico y no se solucionan los problemas ¡El problema es de la alimentación y el culpable el nutrólogo!”
Y por su parte, el nutrólogo pensaba: “No se puede hacer más desde el punto de vista de la alimentación ¡Aquí hay una bacteria o un virus especialmente patógenos que lo desbarata todo, hace falta un veterinario que dé con ello!”
Como siempre, cuando fuimos allí nos enseñaron montañas de análisis laboratoriales, tanto microbiológicos como de alimentación. Cuando exploré las vacas, el problema podal era un brote de flemón interdigital. Pero el problema no estaba en los gérmenes, sino en el elevadísimo estrés al que sometían a las vacas en el momento más delicado para ellas, el periparto. Éste hacía que bajaran las defensas y aparecieran todo tipo de enfermedades como el panadizo. Y por si todo esto no fuera bastante, también había un problema de dosificación errónea del antibiótico.
La solución, como siempre, era más sencilla y más barata de lo que a primera vista pudiera parecer. Se trataba de reducir el estrés, reduciendo el número de patios, el movimiento de las vacas y eliminando los tratamientos que no fueran absolutamente imprescindibles y de eficacia reconocida. Resumiendo ¡Había que dejar a las vacas tranquilas!
Juan Vicente González Martín DVM, PhD, Dipl. ECBHM
Profesor Titular Dpto. de Medicina y Cirugía Animal, Facultad de Veterinaria, UCM
TRIALVET Asesoría e Investigación Veterinaria SL www.trialvet.com/ e-mail: trialvet@trialvet.com
Una de las creencias que más me llama la atención es esa que asocia las cojeras de las vacas con errores en la alimentación. Donde más he visto esta creencia es en el vacuno lechero y en el cebo. Y no sucede sólo en España, es algo generalizado. Sin embargo, a día de hoy, esto no se ha podido demostrar de forma científica. Nadie ha podido repro-
ducir de forma experimental cojeras en las vacas alterando de alguna manera la alimentación. La idea probablemente tenga dos orígenes:
Uno es el hecho de que en granjas con mala alimentación, mal manejadas en general, la incidencia de cojeras es mucho mayor, pero también es mayor la incidencia de metritis o de mastitis.
El otro es la extrapolación de la etiología de las cojeras en los caballos a las vacas. Y aunque en ellos sí se ha visto la relación de la alimentación o de infecciones graves como la metritis con la infosura, eso mismo no se ha podido demostrar en las vacas.
Por otro lado está la influencia de tantas y tantas personas que utilizan los problemas que se puedan dar en una granja como argumento para vender sus productos o servicios, sin ser especialistas, sin un estudio previo e incluso sin que sus productos tengan nada que ver con el problema de la granja. ¡Con qué facilidad compramos productos milagrosos! ¡Qué fácil es vender algo que sólo con dinero soluciona nuestros errores!
Las cojeras infecciosas de las vacas
Como todos sabemos, las cojeras en las vacas son el tercer problema médico en la granja después de la reproducción y la mamitis. Y en nuestros animales, la inmensa mayoría de las claudicaciones se producen en los pies, lo que llamamos cojeras bajas. En contraposición a ellas están las cojeras que asientan más arriba, como por ejemplo la luxación de cadera o la artritis de la rodilla. Éstas se engloban en lo que se denomina cojeras altas.
Existe sólo un puñado de enfermedades principales que afecten a los pies de las vacas. Se pueden clasificar de muchas maneras pero una muy práctica es la que las clasifica en enfermedades infectocontagiosas y las que no lo son. Las contagiosas son solamente dos, la dermatitis digital, que tanto dinero nos cuesta en vendas y el flemón inter-


La inflamación simétrica es muy característica del flemón interdigital, aquí se aprecia en toda la zona enrojecida de la extremidad posterior derecha
Sin embargo esta inflamación no es simétrica,


Si no se trata adecuadamente, la vaca puede incluso llegar a perder un dedo
ochenta. Hasta entonces, la enfermedad contagiosa más habitual era el flemón interdigital, también llamado panadizo y pedero. Realmente este último nombre es más aplicado a una enfermedad parecida que sufre el ganado ovino.
La dermatitis digital y la dermatitis interdigital solamente afectan a la piel, pero el flemón interdigital, como su propio nombre indica, produce lesiones internas. Un flemón es una infección que se establece y difunde por el tejido conjuntivo que separa los diferentes tejidos, produciendo su necrosis. La clave que diferencia la evolución en las tres enfermedades está en los gérmenes que las producen. La dermatitis interdigital está producida por el Dichelobacter nodosus que sólo afecta a la epidermis. La dermatitis digital la producen espiroquetas que, aunque solo afectan a la epidermis, producen lesiones erosivas en unas ocasiones o bien proliferativas en otras, siendo más dolorosas. Pero el flemón interdigital está producido por el Fusobacterium necrophorum y en muchas ocasiones se encuentran junto con él otras bacterias como la Porphyromonas levii, motivo de la gravedad de las lesiones producidas.
F. necrophorum es una bacteria muy dañina que además del panadizo produce abscesos en el hígado y metritis graves en las vacas; y difteria (laringitis necrótica) en las terneras. El motivo de la gravedad de las lesiones que origina es que posee una toxina, un lipopolisacárido que da lugar a necrosis en los tejidos. La bacteria vive en el aparato digestivo de las vacas, por lo que la podemos encontrar en todos los animales de todas las granjas. Es anaerobia, por lo que no vive en presencia de oxígeno, de modo que si la granja está limpia y seca no será fácil que tengamos casos de cojeras por esta bacteria. Esta bacteria sobrevive en zonas encharcadas con basura, como por ejemplo en los pasillos que no se limpian completamente con la arrobadera o en los corrales de cama caliente y en potreros o prados alrededor de los bebederos inundados. Pero por sí misma no puede penetrar en el organismo. Para producir la infección necesita alguna lesión en la piel, causada por ejemplo por heridas por objetos punzantes como palos o piedras, por contacto continuo de la piel de los dedos con el purín o por lesiones previas de otras bacterias menos patógenas como las que producen la dermatitis interdigital.
Una vez que la bacteria penetra debajo de la piel que está entre las pezuñas, comienza a destruir los tejidos con sus toxinas. Ésto produce una gran inflamación en la zona, con calor y dolor intenso, incluso en muchos casos fiebre de 40 o más grados centígrados y por supuesto una gran cojera.
Sin embargo, no todos los casos son igual de graves. Hay granjas en las que prácticamente no se ven casos, hay granjas en los que los casos son leves, hay casos que pese a ser agudos se controlan bien con antibióticos y casos extremos que responden mal a los tratamientos. Y es que esta enfermedad podría ser modelo para otras enfermedades infecciosas. Las enfermedades infecciosas son el resultado de la interacción entre los gérmenes, el ambiente y el paciente. Ya hemos visto la importancia del ambiente, ya que tiene que haber basura, o purines para que vivan allí las bacterias. La bacteria también es muy importante claro, ya que sin ella no habría enfermedad. Pero aunque esta bacteria en concreto se encuentra habitualmente en el rumen de todas las vacas, también hay que decir que existen distintas cepas de F. necrophorum, siendo algunas de ellas mucho más patógenas que otras y algunas más resistentes a los antibióticos que otras. Y por último, aunque no por ello menos importante, está el sistema inmune de la vaca. No en vano la enfermedad suele aparecer en mayor medida en el posparto, que es cuando menos resistencia tiene la vaca a las enfermedades infecciosas. Por lo tanto, con una buena higiene y un buen manejo de la vaca para que sufra el menor estrés posible, no deberá preocuparnos la enfermedad.
Otra buena noticia es que esta infección se controla muy fácilmente con tratamiento antibiótico. El tratamiento debe ser parenteral, inyectable. No sirven los tratamientos locales y también está contraindicado el vendaje de la pezuña, pues al tratarse de un germen anaerobio el aire ayuda a controlarlo. El tratamiento debe ser aplicado lo antes posible y mantenido por tres días. Esta bacteria es sensible a muchos antibióticos: tetraciclinas, penicilinas, cefalosporinas, macrólidos, fenicoles o sulfamidas entre otros.
Sin embargo, yo he tenido casos en los que esta enfermedad causó graves pérdidas a la explotación. Los problemas aparecen cuando una vaca sometida a un gran estrés enferma, no es tratada adecuadamente y la enfermedad progresa contaminándose todo el ambiente de la granja por el pus, con una cepa de F. necrophorum especialmente patógena que contagiará después a otras vacas y se mantendrá así la enfermedad de forma enzoótica. Los errores vienen fundamentalmente del fallo en el diagnóstico o del fallo en el tratamiento.
El diagnóstico es relativamente sencillo, pero hay que explorar al animal. Entre las cojeras infecciosas la diferencia es fácil: la dermatitis digital produce cojera, a veces intensa, pero no produce inflamación ni fiebre. Quizás con las cojeras que más fácilmente se confunda sea con las úlceras de la palma, de línea blanca y con el absceso retroarticular (las conocidas aguaduras). Todas estas pododermitis sépticas producen inflamación del talón cuando progresan y en ocasiones, afectan a todo el dedo. Aquí es donde estriba la diferencia, ya que estas enfermedades producen inflamación de un sólo dedo, de forma asimétrica, y el flemón produce inflamación en los dos dedos y de manera simétrica. Pero el flemón tiene otras particularidades
casi únicas. Aparece bruscamente (en un día más o menos), produce fiebre, la vaca deja de comer y baja la producción láctea. Todo esto son características de las infecciones producidas por bacterias Gram negativas, como es nuestra F. necrophorum, o las pasterelas de la neumonía o los coliformes de las mamitis ambientales. Además, si levantamos la pata afectada veremos que la piel que está entre los dos dedos está necrosada y si la tocamos y después olemos el dedo comprobaremos que tiene un olor nauseabundo. Todo esto sólo se da en el flemón interdigital.
Y algunos os estaréis preguntando ¿Qué problema hay con no hacer un diagnóstico correcto? El problema es que si no se hace un diagnóstico correcto difícilmente se aplicará el tratamiento adecuado y sin tratamiento la enfermedad puede ser desastrosa. Si el sistema inmune de la vaca y el tratamiento adecuado no detienen la progresión de la necrosis producida por la bacteria, ésta entrará en la articulación de la primera con la segunda falange y la destruirá, llegando en casos extremos a desprenderse todo el dedo.
El tratamiento
Como hemos dicho antes, el tratamiento es muy sencillo, tan solo se necesitan tres días de tratamiento antibiótico. Pero eso sí, hay que hacerlo pronto, al principio de la enfermedad. Ningún otro tipo de cojera de las enumeradas anteriormente necesita tratamiento antibiótico inyectado: la dermatitis digital necesita legrado, antibiótico local y vendaje y las úlceras y abscesos lo que necesitan es la apertura del absceso y el arreglo corrector del casco por un podólogo experimentado.
Con el uso de antibióticos en las cojeras se puede pecar tanto por exceso como por defecto. Si la enfermedad que sufre la vaca es un flemón interdigital y no se aplica antibiótico de la manera adecuada, ya hemos visto que probablemente perdamos la vaca. Pero si inyectamos antibiótico en cualquiera de los otros casos, no solo estaremos tirando el dinero sino que estaremos favoreciendo la aparición de las temidas resistencias de las bacterias a los antibióticos, que tanto daño hacen a nuestros animales y a nosotros mismos.
Aunque son muchos los antibióticos eficaces para tratar la enfermedad, debido a que con mucha frecuencia se presenta en el pico de lactación, lo más indicado es el uso de productos con poco o ningún periodo de supresión. Las cefalosporinas serían ideales, desde las de primera generación como la cefalexina, de tercera generación como el ceftiofur o incluso de cuarta generación como la cefquinoma. Pero lo que sí es muy importante es que el tratamiento dure al menos tres días. Es importante estar atento a la dosificación correcta. Y aun haciéndolo todo correctamente, hay veces que el tratamiento que va bien durante un tiempo no funciona más tarde o el que va bien en una granja no funciona en otra. F. necrophorum, al igual que otras bacterias, puede desarrollar resistencias con facilidad. Los antibióticos son medicamentos que se deben usar bajo supervisión y prescripción veterinaria y es nuestro veterinario quien mejor nos asesorará en todos estos casos.
Profilaxis
Por supuesto que también podemos hacer profilaxis de la enfermedad. Lo primero, como en todas las enfermedades, es reducir el estrés al máximo y especialmente en el periodo más crítico, que es el periparto. Mantener las patas de las vacas limpias y secas, con buena cama. Y evitar que los pasillos y caminos puedan traumatizar los pies de las vacas cuando caminan por ellos manteniéndolos limpios de piedras, palos u otros objetos punzantes. Los baños de patas con sulfato de cobre al 5% también ayudan, pero no está tan claro que lo hagan las vacunas (autovacunas) o la suplementación con zinc, salvo que haya deficiencia de ese metal en la alimentación. Una vez más no se trata de gastar dinero en productos mágicos, tan solo tenemos que tratar bien a nuestras vacas.


La mastitis continúa siendo la enfermedad más común y que mayores pérdidas ocasiona en una explotación lechera y aunque la erradicación sigue siendo imposible erradicarla, si que está a nuestro alcance la implantación de medidas que ayuden a prevenir infecciones intramamarias y reducir los casos de mastitis clínica. Todas estas medidas deben incluir se en un Programa de Control de Mas-

para ver cual es la evolución de los casos de mastitis clínica. Por otro lado el papel que juega el diagnóstico laboratorial es decisivo, es necesario conocer cual o cuales son los microorganismos que están causando la mastitis y a los cuales nos enfrentamos porque esto determinará el tipo de tratamiento que decidamos aplicar.
En muchos casos no se dispone de registros de los casos de mastitis que nos puedan ayudar a incrementar la eficacia de los tratamientos y por otro no sabemos la etiología de las mastitis clínica, es decir el microorganismo que está causando la mastitis. Por un lado el simple hecho de tener un registro de los casos de mastitis nos puede ayudar a decidir cual va a ser el tratamiento en base a los resultados anteriores, sabremos si es una vaca crónica o no, y por supuesto a nivel de rebaño es de gran ayuda
Nuria Roger y Luís Miguel Jiménez Servet Talavera SL. luismi-che@servettalavera.esEn este sentido el cultivo de las muestras de leche de los casos de mastitis es una herramienta muy útil que nos puede ayudar a decidir qué tipo de tratamiento usar con el fin de aumentar la tasa de curación y de reducir la tasa de repetición de los casos. A nivel práctico no se puede esperar 76 horas que es el tiempo mínimo de proceso de una muestra en el laboratorio para tratar una mastitis. Tenemos a nuestra disposición herramientas que nos ayudan a tomar decisiones en menos de 24 horas, esto se conoce como cultivo en granja, que no es otra cosa que el cultivo de las muestras de leche en medios selectivos y esto se realiza en la propia explotación. Se debe entender que esta herramienta nos va a ayudar a decidir cual será el tratamiento de elección, ni mucho menos se va a llegar a un diagnóstico específico, por tanto las muestras una vez cultivadas en la granja se deben remitir a un laboratorio de microbiología especializado para que se realice un aislamiento e identificación completo. Las ventajas de la utilización de este método precoz de diagnóstico es por un lado incrementar la tasa de curación de los animales que han tenido mastitis clínica, esto se debe a que mediante esta herramienta las vacas recibirán una terapia antibiótica más dirigida y consistente ya que el diagnóstico es más preciso. La otra gran ventaja es la rentabilidad económica de la explotación puesto que mediante el uso del cultivo en granja disminuirán las pérdidas generadas por la mastitis. Partimos de la base que si conocemos más acerca del agente causal de la mastitis se va a reducir el coste de los tratamientos puesto que la elección de los mismos será más adecuada y certera, favoreciendo así una reducción en los tiempos de hospita- lización y de leche descartada como consecuencia de los tratamientos.
El método consiste en la siembra de la leche en una placa de cultivo denominada biplaca que está dividida en dos partes, en cada parte crecerá un tipo de microorganismo, una parte para los microorganismos gram negativos y otra para el crecimiento de los microorganismos gram positivos.
Dependiendo de que haya crecimiento en una parte u otra de la biplaca se procederá a tratar de
Staphy-
fueron tratados el 100% y en los 217 solamente se trataron el 43%. La curación bacteriológica se evaluó tomando 3 muestras posteriores al caso. El 37% de las infecciones fueron causadas por coliformes, el 23% por estreptococos, el 15% por estafilococos coagulasa negativos, el 10% por Staphylococcus aureus y el resto (15%) por otros microorganismos. La tasa de curación en los 231 cuartos que se trataron fue del 71% y en los que solamente se trataron el
Foto 2Foto 3
Son muchos los cultivos que dan como resultado un crecimiento negativo, un estudio de 2008 realizado por Richard Olde en Canadá reveló que casi el 44% de un total de más de 3.000 muestras de mastitis clínica tuvieron como resultado ausencia de crecimiento. En la mayoría de los casos no hay ninguna ventaja en tratar estos casos de cultivo negativo con antibioterapia puesto que no hay evidencia de microorganismos, simplemente el tratamiento puede consistir en antiinflamatorios no es-
43% con antibiótico la tasa fue de un 60%. Se podría pensar que las vacas tratadas en el momento que se ve la mastitis podrían más éxito en la curación y sobre todo menos tasa de repetición que las infecciones que se tratan transcurridas 24 horas (hasta que tenemos el resultado del cultivo). Esto no es así, en un estudio en 4 rebaños comerciales en Dakota del Norte y Michigan demostraron que las vacas en las que se obtuvo un resultado preliminar y fueron tratadas 24 horas después la tasa de


detectar una bacteria susceptible de tratar con antibióticos. La especificidad fue del 80%, es decir en el 80% de los casos se detectó una bacteria que no era susceptible de tratar con antibiótico. La tasa de curación fue de un 77% en los casos en los que se usó el cultivo en granja y de un 87% en los que no se usó. El menor consumo en antibióticos obtuvo una rentabilidad en la explotación de 3.300 dólares por un menor desecho de leche y un menor consumo de antibióticos.
En un estudio realizado por Servet Talavera en explotación de aproximadamente 1.000 vacas en ordeño también se evaluó los beneficios del uso del cultivo en granja, se tomaron muestras de 173 casos de mastitis clínicas, una vez que las muestras fueron
•Tomar una muestra en un tubo estéril
•Identificar la muestra con nº de vaca y cuarto afectado
•Sembrar las biplacas e incubar en la estufa a 37ºC

cultivadas en la granja, inmediatamente se congelaron para su posterior envío a un laboratorio convencional y proceder a su análisis siguiendo los procedimientos del Nacional Mastitis Council (NMC). Para demostrar la eficacia del método del cultivo en granja se evaluó la tasa de curación de los casos de mastitis clínica. Esta explotación tenía una tasa mensual de mastitis clínica del 5,5% con una epidemiología de mastitis variable, en la que los microorganismos que más destacaban eran Staphylococcus aureus, Enterococcus, Prototheca y coliformes. En esta explotación se empezaron a usar para la determinación de los patógenos causantes de mastitis, biplacas o triplacas que contienen medios selectivos que permiten el desarrollo de los patógenos más prevalentes de la explotación. Una vez sembradas las muestras se incuban a 37ºC y se realiza una primera lectura a las 12 horas para comprobar si existe crecimiento o no en alguna de las partes de la placa. Si no existe crecimiento se incuban 12 horas más y se realiza una lectura final antes de instaurar un protocolo de tratamiento. Todos los animales con mastitis clínica se dividieron en dos grupos, un grupo tratamiento del que previamente a la aplicación de un tratamiento antibiótico se tiene información sobre la etiología de la enfermedad a través el uso del cultivo en granja, y un grupo control, que también reciben terapia antibiótica, pero que se desconoce el agente causal. Para valorar si los animales han curado o no después del tratamiento se usó el recuento de células somáticas del control lechero siguiente al episodio de mastitis. Aquellos animales que tuvieron un recuento de células somáticas menor o igual a 200.000 cel/ml. se les considera curados. La sensibilidad del método de diagnóstico del cultivo en granja fue del 75,6% y la especificidad fue del 90,1%. En cuanto a la curación de los casos, se comprobó que en el caso de los animales en los que se usó el cultivo en granja el 50% de los casos curaron y solamente el 20% de los animales en los que se trataron directamente.
•Congelar la muestra para envío al laboratoiro
•Leer a las 12-18 horas
Sin crecimiento
Incubar 12-18 horas
El cultivo en granja es una herramienta eficaz que tenemos a nuestra disposición y que se puede incluir dentro de un Programa de Mejora de la Calidad de la Leche. Se puede usar de una manera sencilla en cualquier explotación de leche o incluso como método de diagnóstico precoz para equipos veterinarios. Simplemente se necesita una estufa de cultivo, placas de cultivo, escobillones para la siembra de leche y por supuesto una mínima formación para poner la técnica a punto. Es un método muy versátil que se puede adaptar a la epidemiología de todos los gérmenes causantes de mastitis de las explotaciones lecheras. Nos ayudará a decidir más rápidamente y con criterio el tratamiento de los casos de mastitis aumentando así las curaciones y nos puede aportar otras ventajas como el menor uso de antibióticos repercutiendo en la economía de la explotación. (Cuadro 1)
Referencias
Minnesota Easy Culture System II Handbook. Laboratory for Udder Health, University of Minnesota Veterinary Diagnostic Laboratory, St. Paul, MN.

Alfonso Lago y col. Use of On-farm Culture Systems in Mastitis Control. Proceedings NMC Regional Meeting 2007. Martín Pol y col. On-Farm Culture: Characteristics Of The Test. Proceedings NMC Annual Meeting 2009 Nuria Roger y col. Valoración del cultivo de muestras de leche en granja: resultados preliminares. Libro de ponencias, Congreso Internacional Anembe 2011. Cultivo en granja. www.atlanticfarmsolutions.com
Sin crecimiento Gram + Gram + GramGram -¡Tu nuevo tanque que sea TCool!
Una producción láctea de calidad superior asegurada

n Eficiencia energética: Consumo eléctrico reducido y máxima capacidad de refrigeración*
n El mejor sistema de lavado del mercado: Un proceso de limpieza que no deja restos bacterianos
n Seguridad del enfriamiento: Gran aislamiento de serie**
n 5 años de garantía en evaporador
Consulte nuestras exclusivas condiciones de financiación.
* Ej: Grupo frigorífico 10 CV capacidad de enfriamiento 620 litros/hora con una temperatura ambiente de 32 °C.
** Densidad 41 kg/m3, Grosor 5 cm de media (7 cm en la mitad inferior y 3 cm en la superior). Leche refrigerada a 4 °C con temperatura exterior de 38 °C, sin conexión eléctrica, sólo permite un aumento máximo de 0,5ºC en 12 horas.
GEA Farm Technologies Ibérica S.L.
Avda Sant Julià 147 -08403 Granollers, Barcelona
Tel: +34 938 617 120, Fax: +34 938 494 988, E-mail: agricola@gea.com
www.gea.com | www.gea-farmtechnologies.es
De las 774 explotaciones con cuota, 743 produjeron leche en 2012. La explotación media de Catalunya, según la muestra del Observatori de la llet1, tiene una superficie agraria útil de 53,69 Ha, de la cual, prácticamente su totalidad se dedica a la producción de leche, con 141 vacas presentes, 3,22 unidades de trabajo agrario (UTA) y con un capital invertido de 4.015 euros por vaca.
El 34,23% de la superficie se aprovecha a doble cosecha anual y el 43,63% es de regadío, mayoritariamente presente en explotaciones con cuota superior a 500.000 litros. El 33% de las vacas presentes son de primera lactación, el 44,64% de segunda y el 21,17% de tres y más lactaciones. La carga ganadera (en unidades de ganado mayor) es de 3,93 y en vacas presentes de 3,04. Por cada UTA corresponden 40,70 vacas presentes. El 65,61% de la mano de obra es familiar (porcentaje inferior al de 2011 que fue de 68,38%). Una unidad de mano de obra familiar dedica 2.825 horas al año y una de contratada 2.471. El sueldo bruto de un asalariado fijo, incluida la seguridad social, es de 8,64 €/hora.
Del capital invertido el 49% lo está en animales, 23% en edificios, 14% en maquinaria, 10% instalaciones, y el resto, 4%, en cuota.
En cuanto a la producción de leche la media fue de 9.024 litros por vaca presente y año, con una tasa de grasa del 3,69% y de proteína del 3,28%. El recuento celular fue de 232.000/ml y el de bacterias de 23.000/ml. El consumo de concentrados por vaca y año fue de 4.584 kg, con un índice de 2,11 litros producidos por kg de concentrado consumido.
A continuación se presentan los resultados de la gestión económica de 2012
Los ingresos totales fueron inferiores en un 1,38% a los de 2011. Los relativos a la venta de leche fue-
J. Maynegre*, M. Nogué*, S. Olives** y A. Seguí***
* Ingenieros agrónomos, Gestrum Integral SLP, jmaynegre@agronoms.cat
** Ingeniera agrónoma, UdL, s.olives@prodan.udl.cat
*** Dr. Ingeniero agrónomo, asegui@remugants.cat
ron 32,99 cts. €/l, prácticamente iguales a los de 2011 (0,09 cts. por debajo).

La venta de leche es la partida mayoritaria y las subvenciones e indemnizaciones representan el 11,65% de los ingresos.
Los costes variables –cualquier gasto originado por la producción de leche, directamente relacionado con la cantidad–fueron de 26,89 cts./l, de los cuales, como cada año, los relativos a los productos comprados para la alimentación son los mayoritarios, representando el 64%. Cabe destacar que esta partida aumentó en 1,84 cts./l respecto a la de 2011.

1 La muestra tiene cuatro estratos (a: 4 explotaciones con menos de 250.000 litros de cuota; b: 7 entre 250.000 y menos de 500.000; c: 14 entre 500.000 y menos de 1.000.000; d: 22 con más de 1.000.000).
Los productos comprados para la alimentación se desglosan en las siguientes partidas:

Los costes fijos –todo coste en efectivo o calculado relacionado con la estructura de la explota-
Este año 2012 los costes de oportunidad fueron inferiores en 32,66% a los de 2011. Las explotaciones son mayores en cuanto a efectivos ganaderos y tienen más mano de obra asalariada.

En definitiva, los resultados fueron los siguientes:

Como hemos reseñado, los ingresos han bajado 0,56 cts./l respecto de 2011 y los costes variables han aumentado 2,67 cts./l, los costes fijos han bajado 5% y los de oportunidad han bajado el 32,66%. Partida


La partida de amortizaciones de maquinaria es la más importante de las amortizaciones técnicas, representando el 42% sobre el total, seguida por los edificios u obra civil (23%), instalaciones (22%) y finalmente la cuota lechera (13%).
La conservación y la reparación de la maquinaria representan el 56% del total de la partida de contribuciones, seguros y conservación, seguida de la conservación y reparación de edificios, con un 16%.
Los costes de oportunidad, que representan la valoración del capital invertido, de la mano de obra familiar y de la renta de la tierra en propiedad, siguen una tendencia inversamente proporcional al volumen de leche producido. A menor volumen de leche producido más costes de oportunidad. Sirven para valorar, sobre todo, la mano de obra familiar, a la que se le asigna la renta de referencia de los presupuestos generales del Estado, que este año fue de 27.907 €/UTA, superior en 1,5% a la de 2011.
En consecuencia, el margen bruto (ingresos menos costes variables) de 2012 baja 3,23 cts./l respecto al de 2011 (bajada del 19,07%), el margen neto baja 2,66 cts./l (47,58%) y el beneficio baja 0,05 cts./l (1%). Sin duda la pérdida de ingresos y el aumento del coste de la alimentación son las causas del descenso. Desde 2006 (primer año del Observatorio) el beneficio medio es negativo, por primera vez, en todos los estratos.
Con tales resultados, la producción de leche en Cataluña se habría realizado sin pérdidas y con una remuneración por UTA de acuerdo a la renta de referencia, en el año 2012, a partir de un precio medio de la leche (con primas de calidad incluidas) de 36,90 cts. €/l. O dicho de otra forma, el coste medio de producción de un litro de leche en Cataluña en el ejercicio 2012 fue de 44,52 cts. €/l (mano de obra familiar incluida).
Pueden encontrar el informe completo del año 2012, y demás información relacionada con el Observatori de la llet en la página web oficial del Departament d’Agricultura, Ramaderia, Pesca, Alimentació i Medi Natural (DAAM) de la Generalitat de Catalunya

Las condiciones ambientales reinantes en un alojamiento de vacuno lechero son de la mayor importancia para el confort y bienestar de los animales allí alojados, amén de ser una condición necesaria (aunque no suficiente) para que éstos puedan expresar todo su potencial productivo.
Por otra parte, cuando las vacas están en unas condiciones de alojamiento óptimas aumenta su resistencia a las enfermedades, es decir, a la primera causa de NO BIENESTAR. En efecto, el sistema inmunitario del animal se deprime cuando estas “necesidades ambientales” no están correctamente satisfechas.
En este trabajo nos vamos a referir fundamentalmente al factor temperatura, cuyos elevados valores van a causar lo que se conoce como ”estrés térmico”1 o “estrés calórico”. No obstante, otros factores ambientales como la humedad o la velocidad del aire pueden aliviar o agravar este estrés, como señalaremos oportunamente.
Por tanto, tras describir cuáles son las necesidades térmicas de estos animales, explicaremos cuáles son sus mecanismos de producción y eliminación de calor , las consecuencias del estrés calórico y las distintas estrategias para evitar alcanzarlo o, al menos, para mitigar sus efectos.
Es preciso señalar que no es sencillo conseguir de forma óptima, en todo momento, el confort térmico de las vacas lecheras, teniendo en cuenta que, al contrario que en explotaciones intensivas de animales monogástricos, en los alojamientos bovinos el control de la temperatura es mucho menor, cuando no inexistente. Además, diversas circunstancias contribuyen a aumentar esta dificultad:
•Hay una variada tipología de alojamientos, según la edad y estado fisiológico del animal a alojar
•Las condiciones climatológicas propias de la zona donde se ubica la granja; con frecuencia, sin suficientes datos históricos que orienten sobre la solución constructiva a adoptar.
•La considerable variación de la climatología a lo largo del año en la mayor parte de nuestro país y de otras zonas de similar latitud geográfica.
Antonio Callejo Ramos. Dr. Ingeniero Agrónomo
Dpto. de Producción Animal-EUIT Agrícola-UPM antonio.callejo@upm.es
•La elevada producción de calor y de vapor de agua de estos animales (dado su tamaño y nivel productivo), así como de deyecciones que, a su vez, generan gran cantidad de calor, vapor de agua y gases nocivos, cuya mayor o menor importancia en el confort ambiental también dependerá del sistema de eliminación de deyecciones que se arbitre.
Si a esto le unimos la diversidad de modelos productivos existentes, las diferentes condiciones ambientales entre distintas zonas geográficas o, incluso, la diversa reglamentación o normativa, podemos entender la dificultad que entraña ofrecer sugerencias de tipo general en las cuestiones que se van a tratar en este capítulo. Por ello, emplazamos al lector a considerar las condiciones y circunstancias particulares que haya en cada caso, tomando las decisiones que cada uno de ellos precise.
2. TEMPERATURA.
Los procesos fisiológicos en las vacas (como en todos los mamíferos) requieren, dentro de unos límites, una temperatura corporal relativamente constante. Ello se debe a su condición de animales homeotermos. Dado que la temperatura del ambiente que rodea al animal es variable, las vacas deben poner en funcionamiento una diversidad de mecanismos de adaptación a esa variabilidad térmica, fundamentalmente modificando aspectos etológicos (comportamiento) y fisiológicos (ver punto 4). En definitiva, se trata de que la producción y eliminación de calor por el animal se mantengan en equilibrio.
No obstante, debemos recordar que no sólo la temperatura del aire (la que medimos con el termómetro) es responsable de la temperatura efectivamente percibida por el animal.
Hay otros parámetros que actúan combinadamente sobre el confort térmico de los animales:
•Temperatura
•Humedad relativa
•Velocidad del aire
•Temperatura de la cama, paredes y suelo
2.1. Mecanismos de producción de calor
Las vacas disponen de los siguientes mecanismos de producción térmica:
1 El estrés térmico también puede ser por frío intenso, pero no es habitual en ganado lechero en nuestro país
• Tasa de metabolismo basal. Es el calor desprendido en los procesos fisiológicos vitales más imprescindibles. Es función del peso metabólico, por lo que aumenta con la edad y el peso.
• Ingestión de pienso. Calor generado en los procesos de digestión. Puede aumentar hasta un 20% el calor basal.
• La termorregulación. Calor generado por los procesos fisiológicos puestos en marcha para mantener la tª corporal, en especial en situaciones de tª ambiental alta (aumento del ritmo cardíaco y respiratorio).
A estos procesos básicos hay que añadir el calor generado en la síntesis de los tejidos muscular y adiposo, por la actividad física y, en animales expuestos, el obtenido por radiación solar.
2.2. Mecanismos de eliminación de calor
En realidad, los mecanismos que se describen a continuación son de intercambio térmico, si bien la situación más habitual va a ser la de animales que necesitan eliminar exceso de calor en situaciones de altas temperaturas ambientales. Por tanto, la eliminación de calor corporal por parte de las vacas puede realizarse por los procesos siguientes:
•Por radiación a través del aire, donde la transmisión de calor entre dos cuerpos se produce por medio de ondas, del más caliente al más frío. Es proporcional a la diferencia de temperaturas y se produce a través de la piel. La radiación puede ser directa o indirecta, es decir, radiación reflejada por otro cuerpo sólido y recibida por el animal.
•Por convección. La transmisión de calor se produce por calentamiento del aire que rodea al animal. Al calentarse, se eleva y permite que aire más frío ocupe su lugar y se repita el proceso. Las pérdidas por esta vía son proporcionales a la velocidad del aire alrededor del animal. Esta convección puede ser forzada cuando se usa energía para mover el aire e incrementar la transmisión de calor. En ambientes calurosos no supone un porcentaje muy importante del intercambio térmico.
•Por conducción. Tiene lugar cuando un cuerpo caliente entra en contacto físico con otro más frío, siendo el intercambio térmico proporcional a la diferencia de temperatura entre ambos cuerpos. En las vacas se produce cuando están tumbadas.
RADIACIÓN + CONVECCIÓN + CONDUCCIÓN = CALOR SENSIBLE
•Por evaporación del vapor de agua en las mucosas del aparato respiratorio, por la piel (sudoración) y por las deyecciones. Se pierden 0,54 kcal por gramo de agua evaporada. La importancia de este mecanismo aumenta conforme se eleva la temperatura ambiental.
EVAPORACIÓN DE AGUA = PÉRDIDAS DE CALOR LATENTE
Los procesos de producción y eliminación de calor se esquematizan en la Figura 1. Para mantener la temperatura corporal es preciso que las ganancias de calor sean iguales a las pérdidas, lo que se representa en la Figura 2.
PRODUCCIÓN DE CALOR = PÉRDIDAS DE CALOR SENSIBLE + PÉRDIDAS DE CALOR LATENTE
Calor de radiación
Reservas corporales
Producción de calor
Energía alimentos

MantenimientoProducciones
Características ambientales
•Temperatura
•Humedad
•Ventilación
Eliminación de calor
Actividad
Características del animal
•Color pelo
•Superficie corporal
•Actividad metabólica
RadiaciónConducción
ConvecciónEvaporación

Tasa de pérdida o ganacia de calor
Temperatura corporal
Pérdida de calor latente
Temperatura ambiental
A: zona de hipotermia, cuyo límite CD: zona de mínimo esfuerzo superior es Btermorregulatorio
C: Temperatura crítica inferior CE: zona de mínimo metabolismo
D: Temperatura crítica superior F: zona de hipertermia, cuyo límite inferior es E

según la temperatura ambiental (elaboración
a partir de Spain y col., 2008)
Enfriamiento NO EVAPORATIVO
Enfriamiento EVAPORATIVO Superficie corporal
Enfriamiento EVAPORATIVO tracto respiratorio
Temperatura ambiente (ºC)
Figura 1. Procesos de producción y eliminación de calor Figura 3. Importancia de unas formas u otras de pérdidas de calor propia
2.3. Temperatura ambiental óptima
Cada especie animal posee una temperatura ambiental óptima. Esta temperatura es la que exige el mínimo gasto energético para mantener la temperatura del organismo dentro de los límites normales.
Para que las tres funciones orgánicas principales (mantenimiento, crecimiento y producción) sean posibles en un nivel óptimo, el animal debe encontrarse expuesto a una temperatura ambiental incluida en el intervalo termoneutro o zona de confort térmico. Este intervalo está limitado por la temperatura crítica superior (tcs) y por la temperatura crítica inferior (tci), cuyos valores dependen de factores ambientales y productivos y que se exponen en la Tabla 2 y en la Figura 4:
•El peso vivo (edad)
•Nivel de producción
•Condiciones climáticas (en animales expuestos al exterior)
•Velocidad del aire
•Humedad relativa
•Posición del animal (levantado o acostado
•Grado de humedad de la piel
Como podemos observar, los rumiantes adultos son mucho más tolerantes al frío que al calor
Grandes variaciones de temperatura respecto a la óptima, tanto por exceso como por defecto, así como la duración de las mismas, pueden ocasionar graves alteraciones, dando lugar a situaciones de estrés térmico (por calor o frío, respectivamente). En estas circunstancias, los animales ponen en funcionamiento mecanismos termorreguladores para que la temperatura del cuerpo se mantenga constante, y que serán comentados cuando hablemos de estrés calórico, puesto que el estrés por frío es muy poco frecuente en nuestro país y en vacas lecheras.
El valor térmico marcado por el termómetro no tiene por qué coincidir con la temperatura realmente percibida por los animales o temperatura efectiva. Factores como la humedad relativa, la velocidad del aire o la temperatura de la cama y del agua de bebida modifican la sensación térmica del animal (Tabla 3).
En efecto, la humedad es otro factor determinante del confort ambiental de las vacas. La principal fuente de humedad de la nave son los animales, bien a través de las deyecciones o, en situaciones de estrés por calor, por el jadeo. Esta humedad debe eliminarse mediante la ventilación si no se quiere que sea absorbida por el material de cama y aumenten los problemas por exceso de amoníaco.
Si la temperatura ambiental es correcta, la HR aceptable en los alojamientos ganaderos se sitúa entre el 40 y el 70 %, aproximadamente, y la más aconsejable, entre el 50 y el 60%.
Por no extendernos demasiado, simplemente señalaremos que la humedad relativa excesivamente alta agrava los problemas de estrés por calor cuando coincide con temperaturas elevadas, al reducir las posibilidades de eliminación del calor corporal a través del incremento del ritmo respiratorio (y, en animales que sudan, de la sudoración).




Como quedó expuesto al principio de este trabajo, las vacas lecheras prefieren temperaturas entre 0 y 24 ºC, pudiendo mantener su producción incluso a temperaturas de -10 ºC. Sin embargo, las vacas empiezan a experimentar estrés por calor a una temperatura de 25 ºC, con niveles normales de

radiaciónsolar reflejada
radiaciónsolarreflejada
radiacióninfrarroja
radiación infrarroja
radiación infrarroja de la atmósfera
radiación infrarroja de la atmósfera
radiaciónsolarreflejada
radiacióninfrarroja
evaporaciónconvección
radiación infrarroja
evaporación suelo
El estrés por calor se produce por combinación de diversos factores ambientales que provocan que la temperatura ambiental efectiva sea mayor que la temperatura crítica superior que delimita la zona termoneutra. Aunque la temperatura del aire es el factor más importante de la temperatura efectiva2, también influyen el contenido en humedad, el movimiento del aire y el intercambio de calor por radiación con el sol y con otros elementos cercanos como suelo, paredes, etc.
Dicho de otro modo, cuando la ganancia de calor del animal supera su capacidad de perderlo
La figura 5 muestra los modos de transferencia de calor en una zona calurosa típica.
La tabla 4 muestra los parámetros que controlan esta transferencia térmica para cada una de los cuatro mecanismos de transmisión.
En ambientes calurosos y en animales expuestos, el intercambio por radiación es el mayoritario (> 75% de la energía absorbida y más del 50% de la emitida). Por ello, la sombra protege a los animales de la radiación solar directa, aunque proporciona otras fuentes de radiación infrarroja.
Por tanto, para alterar el microclima de un animal a través de modificaciones del ambiente que le rodea o de su alojamiento es preciso alterar uno o más factores de los señalados en la tabla 4:
Tabla 4. Factores físicos que influyen en la transmisión de calor desde la superficie corporal del animal1 (tomado de Bucklin y col., (1999)
Factor Modo de transferencia de calor Radiación Convección Conducción Evaporación
Superficie corporal del animal X2 X X3 X4
de la superficie del animal X X X X5
de superficies próximas al animal X X6
Temperatura del aire X X
Velocidad del aire X X
Presión parcial de vapor en el aire X
Forma de la fuente o sumidero de radiación X
Emisividad de la superficie del animal X
Conductividad de superficies próximas al animal X6
Emisividad de superficies próximas al animal X


1 Factores biológicos como aislamiento tisular, vasodilatación y posición del animal influyen en la transmisión de calor, pero son muy variables.
2 Superficie del animal directamente expuesta a la fuente o sumidero de radiación
3 En animales levantados, la transmisión de calor es insignificante; en animales tumbados, dependerá de la superficie del animal en contacto.
4 La superficie húmeda del animal, incluyendo el tracto respiratorio.
5 La temperatura del animal es un factor indirecto, ya que la presión de vapor es función de la temperatura.
6 Únicamente la superficie en contacto con el animal.
020406080100
Humedad relativa (%)
No estrés (ITH<72)Estrés bajo (ITH=72-76)Estrés medio (ITH=76-89)
Estrés severo (ITH=89-98Muerte del animal (ITH>89)
•Temperatura de las superficies próximas (p.ej., proporcionando sombras)
•Temperatura del aire (p.ej., refrigerando el aire)
•Velocidad del aire (p.ej., mediante el uso de ventiladores)
•Aumentando la presión de vapor del aire (p.ej., evaporando agua)
•Conductividad de las superficies de contacto con el animal
Como quiera que las pérdidas de calor sensible (por evaporación) se dificultan cuanto mayor es el grado de humedad relativa ambiental, el estrés calórico debe vincularse tanto a la temperatura como a esta humedad relativa. El ITH (índice tª-HR) relaciona ambos parámetros y puede estimarse a partir de la ecuación siguiente:
ITH = 0,81 * ta + HR * (ta - 14,4) + 46,4
expresándose la temperatura en ºC y la HR en valor decimal, y debiéndose medir a una altura de 1,20 m, en el lugar donde se encuentre el ganado (Figura 6).
Figura 5. Intercambios de calor entre el animal y el entorno en un ambiente caluroso 2 La realmente percibida por el animalSin embargo, estos valores de ITH datan de los años sesenta, cuando la producción de las vacas era notablemente más baja que en la actualidad. Por ello, hoy día el umbral de estrés calórico se sitúa en una
ITH de 65 a 68 en vacas de alta producción. Debemos recordar, por tanto, que las vacas lecheras empiezan a tener sensación de calor mucho antes que nosotros.
Los principales efectos de este estrés son de tres tipos:
Fisiológicos:
•Aumento de ritmo respiratorio, es decir, jadeo, provocando pérdida de saliva y menor poder tampón en el rumen (riesgo de acidosis ruminal).
•Mayor sudoración del ganado. Junto con lo anterior, mayor pérdida de calor latente. En todo caso, este efecto es beneficioso al contribuir a la eliminación de calor.
•Aumento de la tª corporal.
•Aumento considerable del consumo de agua.
•Menor consumo, limitándose la actividad ruminal para no generar más calor endógeno
•Menor rendimiento productivo
•Mayor incidencia de cojeras por estar los anima-
sangre
•Redistribución del flujo global de sangre, dirigiéndose hacia la piel para paliar los efectos del calor.
Inmunológicos:
•Reducción de la tasa de formación de leucocitos y linfocitos, lo que supone una pérdida de capacidad inmunológica y, en definitiva, un debilitamiento del estado de salud.
Etológicos:
•Desplazamiento hacia zonas frescas o de vientos dominantes
•Búsqueda de zonas sombreadas
•Adopción de posturas en extensión (de pie o tumbadas)
•Contacto con superficies y/o suelos fríos
•Dispersión entre animales
•Autohumedecimiento de la superficie corporal
Podemos decir que la vaca sufre estrés calórico y necesita refrigeración cuando se da alguna de las siguientes circunstancias:
•El ritmo respiratorio es superior a 80 respiraciones por minuto3 en, al menos, el 70% de las vacas.
•La temperatura rectal es superior a 39 ºC en, al

Los efectos negativos del calor se ven incrementados cuando:
•Los animales no cuentan con agua fresca a libre disposición.
•No disponen de áreas sombreadas en los patios de ejercicio y patios de espera al ordeño.
•El desplazamiento del ganado por las instalaciones es grande.
•Los tiempos de espera al ordeño son prolongados.
•Las instalaciones están mal diseñadas, con ventilación natural deficiente.
Esto nos da ya una idea de cuáles deben ser las medidas a tomar para evitar el estrés calórico.
La “receta”, a priori, es sencilla: reducir la transmisión de calor desde el ambiente hacia la vaca y aumentarla en sentido inverso, de la vaca hacia el ambiente. Las ganancias de calor por parte del animal las podemos reducir proporcionando sombras y limitando la radiación directa e indirecta. Las pérdidas de calor del animal las aumentaremos, por un lado incrementando la velocidad del aire y, por otro, a través del agua de bebida y de la evaporación de agua, de forma directa o indirecta.
5.1. Sombreo
En una buena parte de las explotaciones lecheras de nuestro país las vacas disponen de una nave cubierta donde permanecen constantemente o a


la nave donde se ubica la zona de reposo, bien de cama caliente, bien con cubículos. Por tanto, quizá la única observación que habría de hacerse es que el comedero esté también cubierto cuando éste se coloca fuera de la nave principal.
Sin embargo, aquellas granjas donde las vacas permanecen mucho tiempo en el exterior y, por la razón que sea (de manejo, excesiva distancia, etc.) no descansan en dicha nave, es preciso proporcionarles una zona sombreada bajo la que poder mitigar los efectos del calor
La sombra puede ser natural o artificial. Aunque la sombra natural proporcionada por los árboles es de gran calidad, no suele ser un sistema práctico ni aplicable a grandes rebaños.
Lo más efectivo es construir estructuras que protejan al ganado de la radiación solar. La orientación de estas estructuras es fundamental. La orientación este-oeste del eje longitudinal de la estructura permite una sombra más estable a lo largo del día, en diferentes estaciones del año. En zonas de clima seco, esta orientación puede resultar recomendable. En cambio, en áreas húmedas puede preferirse la orientación Norte-Sur, porque el desplazamiento de la sombra proyectada a lo largo del día permite el secado del suelo (Figura 7).
Se pueden instalar estructuras fijas, con cubierta convencional de fibrocemento o chapa (Figura 8), o estructuras de cubierta temporal, elaborada con red material plástico (rafia). El éxito y durabilidad de estas últimas depende, en gran medida, de que la colocación de la red sea hecha con muy buen tensado y evitando todo tipo de roces entre la malla y los alambres que se utilicen para su confección.
La consolidación del suelo (tanto si es de tierra como si es de hormigón) debe extenderse más allá del área cubierta por el tejado, debido a que el área sombreada no está enteramente bajo la estructura y es esta área el que van a ocupar los animales. Esta extensión debe cifrarse en unos 2,5 m hacia el norte, 1,25 hacia el sur y unos 6 m hacia el este y hacia el oeste si la altura del alero es de unos 3,5 m. Mayor altura de éste precisa una mayor extensión de suelo firme (Figura 9).
El suelo de tierra es más cómodo para las vacas que el de hormigón, pero en zonas húmedas puede tener graves problemas de enlodazamiento, por lo que en climas húmedos, el suelo bajo la sombra debe estar bien drenado o elevado respecto al terreno circundante.
Una cuestión importante es decidir la altura de la estructura de sombreo. Es verdad que el movimiento del aire es mejor según se incrementa la altura, pero también lo hace el coste económico debido al peso de la estructura y a la necesidad de consolidar una mayor superficie de suelo.
La recomendación es de un mínimo de 3,5 m de altura en alero para estructuras de menos de 12 m de anchura. Estructuras de más de 12 m de anchura
 Figura 7. Representación esquemática de sombras con diferentes orientaciones en dos momentos del año, para el hemisferio norte, indicando la proyección de la sombra en diferentes horarios (área gris) (adaptado de Taverna, 2005)
Figura 8. Estructura fija para proporcionar sombra
Figura 7. Representación esquemática de sombras con diferentes orientaciones en dos momentos del año, para el hemisferio norte, indicando la proyección de la sombra en diferentes horarios (área gris) (adaptado de Taverna, 2005)
Figura 8. Estructura fija para proporcionar sombra
nuestros asesores y la calidad del producto SON TU MEJOR OPCIÓN SIGUE APOSTANDO POR LA CALIDAD, NO RENUNCIES A LOS BUENOS RESULTADOS








CON nutricor, todo ESTÁ bajo control SOMOS TU MEJOR ALIADO



y menos de 3,5 m de altura en el alero presentan un reducido movimiento del aire en el centro de las mismas. Estas instalaciones de más de 12 m de ancho deberían contar con una altura mínima de 4 m en el alero. La distancia entre estas estructuras sombreadoras y otros elementos como árboles, edificios, etc., debería ser, al menos, de 15 m.
Para reducir la radiación solar, la cubierta debería ser blanca, pero esto suele estar prohibido por las normas urbanísticas y las de aviación civil. Suele ser más práctico colocar un aislante bajo la cubierta, bien espuma de poliestireno proyectada o que dicha cubierta sea una placa tipo “sándwich”, con el aislante incorporado, reduciendo así el calor de radiación que reciben las vacas.
Figura 10. Comedero con gran exposición al sol



La temperatura de la cubierta puede reducirse también mediante riego de la misma (y posterior evaporación del agua). Este método puede aportar alguna ventaja en estructuras mal ventiladas, de escasa altura, pero nula en instalaciones con correcta ventilación.
5.2. Comederos y bebederos cubiertos
Es importante que las zonas donde beben y comen los animes estén protegidas de la radiación solar. Ello redunda en una mayor confortabilidad de los animales y también mejora la calidad del agua y de los alimentos ingeridos, más frescos y palatables.
Si ello no es así, las vacas suelen preferir perma-

necer tumbadas a la sombra que ir a beber y a comer, sobre todo en las horas de más calor. En consecuencia, se reduce la ingestión de alimentos y de agua y la producción de leche.
Algunos comederos están cubiertos por la propia estructura de la nave, pero su orientación puede provocar que, en algún momento del día, reciban una intensa radiación solar (Figura 10), por lo que debería proporcionárseles sombras bien colocadas (Figura 11).
Adicionalmente, debemos considerar estimular el consumo suministrando el alimento en las horas más frescas del día y facilitando el acceso al comedero, el cual debe proporcionar espacio suficiente para que todos los animales puedan comer en el momento que lo deseen, sin esperas.
5.3. Disminución de la radiación directa e indirecta
La orientación de los alojamientos debe tener en consideración tres aspectos principales:
•La protección contra los vientos dominantes
•La insolación óptima del edificio
•La situación con relación a cualquier edificio cercano o a todo obstáculo natural que pueda suponer un problema a la libre circulación del aire o que ayude a generar corrientes (efecto pasillo). La parte abierta se orientará, generalmente, hacia el Sureste, lo que sitúa el eje longitudinal de la nave en dirección noreste-sudeste (Figura 12). Esta disposición, así como la Este-Oeste, permite una buena ventilación y una óptima radiación solar (Figura 13). Como es lógico, habrá que estudiar en cada caso la mejor solución, pues existen a veces severos condicionantes (forma de la parcela, del edificio, movimientos de tierra, vientos dominantes, etc.) que obligan a buscar otra solución distinta a la citada.
Figura 11. Malla de sombreo bien colocada protegiendo del sol al comedero Figura 12. Alojamiento de frente abierto. Protección eficaz contra los vientos dominantes e insolación máxima en invierno (BTPL, 2006) Figura 13. La orientación Este-Oeste minimiza la insolación en veranoCon nuestras condiciones climáticas, resulta muy comprometido orientar las naves abiertas en dirección norte-sur, pues permitirá una inaceptable entrada de radiación solar tanto durante la mañana como durante la tarde (Figura 14), aunque la colocación de un peto o cortina (Figura 15) o la prolongación del alero puede minimizar esta circunstancia.
5.4. Ventilación
La ventilación de las naves se tratará en un posterior trabajo para no hacer demasiado extenso el que usted está leyendo. Simplemente comentaremos que el aumento de la velocidad del aire aumenta la sensación de confort térmico (al aumentar la pérdida de calor por convección), por tanto, el estrés calórico. Sin embargo, la instalación de ventiladores es costosa y no proporciona una adecuada reducción térmica del animal salvo que se combine con una refrigeración del aire que mueven.
5.5. Otras medidas
El manejo general de la explotación también puede contribuir considerablemente a reducir el estrés calórico. Así, debe procurarse evitar aglomeraciones:
•Reduciendo los tiempos de espera al ordeño
•Ordeñando en las horas más frescas, si ello es posible
•Proporcionando superficie de descanso suficiente
•Combatiendo a los insectos
6.1. Refrigeración evaporativa.
Este sistema trabaja aprovechando el calor de evaporación (o vaporización) del agua, el cual pasa de estado líquido a gaseoso captando calor del aire, reduciéndose la temperatura de éste y aumentando su nivel de humedad. Por esta razón, este sistema funciona con mayor rendimiento (en términos de reducción de temperatura) cuando la humedad relativa del aire es baja.
En el sistema de refrigeración evaporativa, se refrigera el aire, no la piel del animal. El agua se pulveriza a alta presión sobre las vacas en forma de niebla, es decir, de gotas de agua muy pequeñas que enfrían el aire según se evaporan4. Los ventiladores, instalados sobre los inyectores cada 6 metros y bajo la estructura de sombreo, crean la corriente de aire necesaria para distribuir esta agua. Las vacas inhalan aire más frío y pueden cederle el calor que tienen que eliminar. Este sistema se ha utilizado con gran eficacia en las zonas áridas del sur de EE.UU, logrando un aumento de la producción de unos 3 kg/día y una mejora considerable de los resultados reproductivos.
Sin embargo:
•la presencia de viento (o el propio flujo generado de aire generado por los ventiladores) arrastra estas gotas de agua fuera de la zona donde se ubican los animales.
•Si estas gotas no se evaporan antes de llegar a la superficie del animal, puede formarse una capa de aire entre esta “niebla” y el cuerpo del animal que le dificulta la eliminación de calor.
•Si la ventilación no es adecuada, este sistema pude dar lugar a problemas respiratorios.
4 Al no llegar las gotas al suelo, este sistema puede instalarse para refrigerar aquellas zonas que no deben mojarse; p.ej., la cama o el comedero
Figura 14. La orientación Norte-Sur permite una excesiva entrada


40º latitud Norte, 21 de agosto
Figura 15. Con una orientación Norte-Sur es necesario instalar elementos de protección, aunque pueden limitar la entrada de aire y tener menor efecto protector por la tarde.
2 m de cortina desde mediodía hasta el crepúsculo
40º latitud Norte, 21 de agosto
•El sistema es más complejo y costoso que otros. También se han utilizado muy satisfactoriamente paneles de refrigeración y ventiladores, similares a los usados en naves de animales monogástricos pero son costosos de mantener, y sólo se justifican en zonas muy áridas.
6.2. Ventiladores y aspersores
Los sistemas más utilizados son los que rebajan la temperatura corporal de las vacas mojando directamente el dorso del animal mediante ventiladores y difusión o aspersión de agua, con posterior evaporación de esa agua, por lo que también funciona mejor en climas secos.


Distancia entre difusores
Tuberías de difusores
Típico sistema de pulverizadores colocados sobre la línea de comederos
Cornadiza
3,6 m 1,5 m
Tuberías de difusores
Área mojada por cada pulverizador
Evitar mojar los cubículos Cornadiza
Vista cenital de los aspersores sobre la cornadiza
Los difusores funcionan entre 1 y 3 minutos cada ciclo de 15, de forma que la cantidad de agua expulsada sea de 1,2-1,5 mm por ciclo. El sistema se completa con un regulador de presión, un termostato y un programador.
Los ventiladores se colocan en línea y en sentido longitudinal a la nave, de forma que lancen el aire en el sentido de los vientos dominantes de la zona. Se disponen a una altura de 2,5-3 m, por encima de los difusores, y con una inclinación de 30º hacia el suelo.
m, respectivamente. El caudal respectivo habitual es de 390 y 700 m3/min.
También se pueden colocar ventiladores (aunque no difusores, para no mojar la cama) encima de las filas de cubículos. Los mejores resultados se han obtenido con una línea de difusores y ventiladores sobre el comedero y una línea de ventiladores en medio de la nave en sentido longitudinal (Figuras 18 y 19).
Deben recordarse las necesidades que deben cubrirse para el buen funcionamiento del sistema:
•Estructura cubierta
Los ventiladores se colocan a una distancia 10 veces su diámetro. Como los más habituales son de 90 y 120 cm, se colocan a una distancia de 9 y 12
Figuras 18 y 19. Colocación de los ventiladores


Pasillo de circulación
Pasillo de circulación
Pasillo de alimentación
7. Zonas de tránsito (sombrear) 1,5-2 m
Pasillo de alimentación
•Amplio suministro de agua (175-265 l/vaca y día)
•Alojamiento diseñado para recoger y manejar el agua no evaporada (suelo de hormigón y con adecuada pendiente).
•Adecuado suministro eléctrico. Para evitar un pico excesivo de demanda eléctrica, los ventiladores deben ponerse en marcha de forma secuencial, no simultánea.
•Alimento y agua en las proximidades del área que se enfría. El sistema sólo es eficaz si las vacas comen y producen más.
Otra zona donde conviene instalar estos sistemas de refrigeración es en el corral de espera al ordeño, dado el hacinamiento y la escasa ventilación que en él suelen soportar las vacas.
En muchas zonas de nuestro país, las temperaturas en verano sobrepasan con facilidad los 30 ºC. Sin embargo, las producciones no se ven afectadas cuando el ambiente refresca por la noche.
Por lo tanto, a la hora de plantear inversiones para paliar los efectos del estrés calórico, deberemos tener en cuenta los datos termométricos medios de los meses de verano en la zona donde se ubique la explotación. Una vez revisados estos datos, deberemos determinar el número de días al año que potencialmente producirían estrés calórico en el ganado.
Con estas premisas y teniendo en cuenta el tamaño del rebaño, nivel de producción, ventilación de las naves, etc., se estimarían la cantidad de pérdidas económicas producidas por el calor. A continuación se plantearían las posibles inversiones para evitar estas pérdidas y mejorar el bienestar de los animales y determinar su rentabilidad.
Si nos tenemos que plantear por dónde empezar, nuestra opinión es que deben instalarse primero los aspersores, pues mojando la piel del animal conseguimos que éste pierda calor a través de la piel. En una segunda fase se instalarían los ventiladores, con los que se incrementaría la evaporación en la piel de las vacas y aumentamos aún más la pérdida de calor de éstas.
También podemos preguntarnos acerca de cuál sería el lugar de la explotación por donde empezaríamos a instalar refrigeración, si nuestra capacidad económica nos obliga a establecer un calendario de actuaciones. En este asunto hay disparidad de opiniones. Nosotros nos permitimos dar la nuestra:
1. Corral de espera al ordeño y duchas a la salida de la sala
2. Vacas en maternidad
3. Vacas pre-parto (21 días)
4. Vacas en lactación

5. Vacas secas, novillas y en tratamiento veterinario
6. Áreas de tratamiento
Figura 17. Colocación de los emisores de agua sobre la cornadiza

Artículo 1º.- Organizado por la Confederación de Asociaciones de Frisona Española (CONAFE) y la colaboración de Asturiana de Control Lechero Asociación Frisona (ASCOLAF) se celebrará el 34º Concurso Nacional CONAFE 2013 de la Raza Frisona, en el Recinto Ferial de Asturias “Luis Adaro” (Gijón), durante los días 26 al 29 de septiembre.
Este Concurso está autorizado y dirigido técnicamente por el Ministerio de Agricultura, Alimentación y Medio Ambiente.
Artículo 2º.- Los fines que se persiguen, fundamentalmente son: poner de manifiesto la mejora que se viene haciendo en el país respecto al ganado de la raza a través de la labor selectiva practicada; estimular la dedicación de los ganaderos a la vía de ganado de pedigrí y su participación en los procesos selectivos; orientar la selección y facilitar la adquisición de reproductores selectos, como base para la mejora de las explotaciones y la cría de ganado de esta raza y para competir en el mercado interior y extranjero.
Artículo 3º.- Comité Organizador
La función es la de ejercer de responsable máximo de la ejecución de todos los servicios y medios necesarios para la celebración del certamen y de la aplicación del Reglamento, así como de cualquier incidencia que se presente no prevista en el Reglamento o las dudas que pudieran existir en la interpretación del mismo.
Presidente:
-Germán de la Vega Delgado. Presidente de CONAFE.
Vicepresidentes:
-José Emilio García Suárez. Presidente de ASCOLAF.
-Director del Recinto Ferial de Asturias “Luis Adaro”. -Presidente de la Sociedad Mixta de Turismo y Festejos de Gijón.
-Director General de Agroganadería del Principado de Asturias.
Vocales:
-Todos los miembros de la Junta de Gobierno de CONAFE
-Todos los miembros de la Junta de Gobierno de ASCOLAF
Coordinadores:
-Sofía Alday Martínez de Cestafe. Directora Gerente de CONAFE
-Carlos Méndez Suárez. Director Gerente de ASCOLAF
Artículo 4º.- Comité de Admisión
4.1 Estará compuesto por:
Presidente:
Un miembro de la Junta de Gobierno de CONAFE que no presente ganado al Certamen.
Vocales:
-Gabriel Blanco del Campo. Jefe del Departamento de Morfología de CONAFE.
-Juan Manuel Fernández Ahedo. Coordinador de Calificadores de CONAFE.
-Un Juez Nacional de CONAFE.
-Un Técnico de la Consejería de Agroganadería y Recursos Autóctonos del Principado de Asturias, designado por dicho Organismo.
-Otros técnicos nombrados por la Junta de Gobierno de CONAFE.
Secretarios:
-Los coordinadores generales del Concurso.

4.2 Sus funciones son:
-Verificar la documentación genealógica y su correspondencia con los animales presentados y corroborar que se ajustan a las secciones para las que se presentan al Concurso.
-Colaborar con el Servicio Veterinario de Inspección Sanitaria para garantizar que cada animal se presenta con la documentación sanitaria exigida.
-Comprobar y verificar, en cualquier momento y sin lugar a ninguna objeción por parte de los participantes, que la preparación y presentación de animales se ajusta a los requisitos del Reglamento.
4.3 Sus facultades son:
-Cualquier miembro del Comité puede circular libremente por el recinto del ganado, pudiendo exigir cualquier control o verificación de un animal.
-Podrá dividir las secciones de mucha participación en dos grupos con el objeto de hacer más fácil el juzgamiento.
-Ante una anomalía observada que incumpla este Reglamento, se comunicará a los coordinadores generales, quienes podrán reunir al Comité para tomar la decisión que estime adecuada.
El Comité podrá sancionar con la exclusión de un animal del Concurso o con la anulación de un resultado otorgado en el mismo.
Artículo 5º.- Comité de Juzgamiento
5.1 Estará compuesto por un Juez único a quien acompañará en pista un Técnico de CONAFE, quien actuará de auxiliar para aquél, facilitándole todo tipo de información que se solicite sobre el ganado concursante y hará, al mismo tiempo, de intérprete.
-El Juez será Niels Erik Haahr, Juez Internacional danés del panel internacional de jueces de la Federación Europea de Holstein, EHRC.
-Las decisiones del Juez serán inapelables.
5.2 Obligaciones del Juez.
-Clasificar todos los animales en cada sección según el mérito morfológico, colocándolos en la pista según dicho orden y dar explicación verbal, al menos, de los cinco primeros.
-El Juez debe comportarse en la pista con corrección hacia la Organización, participantes y público, evitando cualquier conducta que pudiera ser objetable o provocativa o que pudiera, de alguna manera, incitar a cuestionar su imparcialidad.
-Firmar el Acta con los resultados del Concurso y emitir un informe de las incidencias.
5.3 Facultades del Juez.
-Eliminar de la pista los animales que no reúnan las condiciones mínimas de juzgamiento o que contravengan los requisitos del Reglamento.
-Dejar desierta alguna sección o algún premio de una sección del programa si los animales, por su cantidad o su calidad, no son a su juicio merecedores de la sección o del puesto.


Artículo 6º.- Todas aquellas cuestiones que exceden de la competencia del Comité de Admisión y del Comité de Juzgamiento, así como cualquier incidencia que se presente y no esté prevista en este Reglamento, o las dudas que pudieran existir en la interpretación del mismo, serán resueltas por la Comisión Organizadora del certamen.
Artículo 7º.- Podrán tomar parte en el certamen todos los ganaderos con animales inscritos en el Libro Genealógico que lo deseen y así lo soliciten mediante la Cédula de Inscripción, siempre que lo hagan dentro del plazo establecido y que el ganado concurrente reúna todas las condiciones que para el mismo se exigen en este Reglamento. Sólo se impondrán limitaciones en cuanto al número de ejemplares concursantes por ganadería, en caso de que la cifra de solicitudes rebase las posibilidades de alojamiento ferial.
Artículo 8º.- Las solicitudes de participación se formularán rellenando las "Cédulas de Inscripción" correspondientes y remitiéndolas, una vez cumplimentadas, a la Confederación de Asociaciones de Frisona Española (CONAFE), cuya dirección postal es:
Apartado de Correos nº 31 (o Crta. de Andalucía, Km. 23,600) 28340 Valdemoro (Madrid)
Sólo tendrán derechos y obligaciones en el Concurso los ganaderos que se hayan inscrito en plazo y forma.
Artículo 9º.- Los impresos de Cédulas de Inscripción pueden solicitarse a la Confederación de Asociaciones de Frisona Española (CONAFE), a la dirección indicada en el Artículo precedente o a Asturiana de Control Lechero Asociación Frisona (ASCOLAF).
Artículo 10º.- Las Cédulas de Inscripción indicadas se rellenarán a máquina, cumplimentándose todos los datos que en ellas se piden; si no es posible rellenarlas a máquina, se hará con letra clara y se utilizarán letras mayúsculas para poner el número genealógico de cada ejemplar, su nombre y fecha de nacimiento.
Artículo 11º.- El plazo concedido para remitir las Cédulas de Inscripción, cumplimentadas según las normas indicadas en los Artículos precedentes, finalizará el día 16 de septiembre de 2013, a las 16:00 horas. Los animales que no figuren inscritos en el Catálogo, no podrán participar en el Concurso.
Condiciones Generales a)De tipo general.
Artículo 12º.- El ganado concursante será nacido en España, procederá de explotaciones inscritas en el Libro Genealógico y contará con la calificación sanitaria hecha en la explotación que lo inscriba.
Artículo 13º.- Para la inscripción de animales en las categorías de vacas en lactación es condición necesaria que, tanto los animales a inscribir como las ganaderías propietarias de los mismos, estén incluidos en Control Oficial de Rendimiento Lechero, tal como se establece en el R.D. 368/2005, de 8 de abril, por el que se regula el Control Oficial de Rendimiento Lechero para la evaluación genética en las especies bovina, ovina y caprina.
Artículo 14º.- Los animales asistentes deberán encontrarse en las suficientes condiciones de presentación y manejo que la categoría y distinción de la raza exigen. Los ejemplares que no reúnan suficientes condiciones serán eliminados del recinto del certamen por el Comité de Admisión.
Artículo 15º.- Las edades citadas en las distintas secciones del Programa se entenderán referidas al 31 de agosto de 2013.
b)De carácter genealógico.
Artículo 16º.- Serán condiciones indispensables que todos los animales concursantes figuren inscritos en el Libro Genealógico de la Raza a nombre de la ganadería que los presenta y que
se presenten al certamen con las correspondientes Cartas Genealógicas o Certificaciones de Registro, cumplimentadas según las normas exigidas por el Reglamento de dicho Libro Genealógico.
Artículo 17º.- Las Cartas Genealógicas o Certificados de Registro, una vez examinados y hechas las comprobaciones oportunas por el Comité de Admisión, serán devueltas a los propietarios o encargados del ganado, quienes deberán presentarlas junto con cada animal cada vez que éstos sean reclamados a presentarse en la pista de calificación para ser examinados por el Juez.
c)De aspectos sanitarios:
Artículo 18º
NORMAS GENERALES
1º Todos los animales vendrán acompañados de la Guía de Origen y Sanidad Pecuaria (GOSP) y del Documento de Identificación Bovina (DIB).
2º Los vehículos de transporte deberán reunir las condiciones exigidas en la normativa vigente, sobre protección de animales durante el transporte.
EXPLOTACIONES
-No hallarse sometida a restricciones para el movimiento de animales por motivos de sanidad animal, de acuerdo con la normativa vigente.
-Estar situadas en una zona que no esté sometida a una prohibición o restricción de conformidad con la legislación sanitaria vigente.
-Certificado oficial acreditando que los animales proceden de explotaciones oficialmente indemnes a: Tuberculosis (T3), Brucelosis (B4), Leucosis, libres de Perineumonía contagiosa Bovina.
ANIMALES
1- Identificación Oficial individual y DIB.
2- Certificado veterinario acreditando que los animales han recibido tratamiento antiparasitario interno y externo en los últimos 30 días a su traslado.
3- No presentarán sintomatología que haga sospechar de enfermedad infectocontagiosa, al menos en las 48 horas anteriores al traslado.
4- Respecto a IBR: certificado oficial veterinario o certificado veterinario e informe laboratorial acreditando que en los 30 días anteriores a la entrada en el concurso los animales han resultado negativos a una prueba de detección de anticuerpos frente a la IgE del virus de la IBR.
5- Certificado Oficial veterinario, acreditando que en los 30 días anteriores a la entrada en el Concurso, han resultado negativos frente a las pruebas sanitarias individuales contra las siguientes enfermedades: Animales menores de 12 meses
-Tuberculosis.
-Paratuberculosis.
-Prueba de detección de Antígeno negativa, de la Diarrea Vírica Bovina, realizada en un laboratorio oficial. Animales mayores de 12 meses
-Tuberculosis.
-Brucelosis.
-Leucosis Enzoótica Bovina.
-Perineumonía Contagiosa Bovina.
-Paratuberculosis.
-Prueba de detección de Antígeno negativa, de la Diarrea Vírica Bovina, realizada en un laboratorio oficial.
6- Cualquier animal participante podrá ser sangrado para comprobar la veracidad de las pruebas sanitarias aportadas.
ACTUALIZACIÓN: Respecto a la Lengua Azul, consultar condiciones sanitarias con la Organización o con las autoridades competentes de cada Comunidad Autónoma.
Artículo 19º.- Con objeto de poder obtener las certificaciones anteriormente citadas, los ganaderos que piensen concurrir

con su ganado al Certamen, las solicitarán de la Jefaturas Provinciales de Producción Animal u órgano equivalente de las Comunidades Autónomas.
Vigilancia Sanitaria
Artículo 20º.- El equipo de veterinarios del Servicio de Ganadería de la Consejería de Agroganadería y Recursos Autóctonos del Principado de Asturias será el encargado del examen de los animales a su llegada al recinto ferial y durante su permanencia en el mismo para comprobar su estado sanitario y exigir, examinar y retener hasta la salida del ganado la documentación sanitaria que se indica en los Artículos 18º y 19º de este Reglamento. Este personal constituye el "Servicio de Inspección Sanitaria".
Artículo 21º.- Aquellos animales que presenten síntomas de enfermedades o los que carezcan de alguno de los documentos o requisitos sanitarios exigidos, no serán autorizados a entrar en el recinto ferial y serán secuestrados o devueltos a su origen, según proceda.
Artículo 22º.- El transportista de los animales, deberá presentar certificado o talón de desinfección, expedido conforme al Real Decreto 1559/2005, de 23 de diciembre.
Artículo 23º.- Este servicio de Inspección Sanitaria colaborará con el Comité de Admisión, al que dará cuenta de las incidencias que se produzcan en su actuación.
Instalaciones
Artículo 24º.- El recinto en el que se celebre este certamen ganadero de carácter nacional, dispondrá en sus instalaciones o en sus en proximidades de un centro de limpieza y desinfección de vehículos de transporte de ganado, autorizado por la Consejería de Agroganadería y Recursos Autóctonos, en cumplimiento del artículo 54 de la Ley 8/2003, de 24 de abril, de Sanidad Animal.
Transporte de Ganado
Artículo 25º.- Para atender a los gastos originados por el transporte del ganado, la Organización compensará a los ganaderos concursantes mediante factura dirigida a CONAFE a razón de 0,24 euros (terneras y novillas) y 0,32 euros (vacas) por kilómetro recorrido y por animal, contando los kilómetros una sola vez desde la finca al recinto ferial.
Artículo 26º.- Los vehículos de transporte del ganado estarán debidamente desinfectados, lo que acreditarán con el Talón correspondiente en el que figurará la fecha de la desinfección y el procedimiento empleado.
Descarga y Alojamiento del Ganado
Artículo 27º.- La descarga del ganado se hará previa autorización del Servicio de Inspección Sanitaria indicado en el Artículo 20º y en su presencia, una vez comprobada la documentación sanitaria presentada por los conductores del ganado.
Artículo 28º.1- El alojamiento del ganado en el recinto ferial se hará bajo la dirección del Comité de Admisión, debiendo ocupar cada animal el lugar que le sea asignado. No obstante, se permitirá que animales participantes en el Concurso permanezcan en los stands comerciales siempre que éstos estén habilitados para ello.
28.2 Queda prohibida la salida de animales de la zona delimitada por el pabellón de estabulación y la carpa de lavado, sin permiso de la Organización.
Sujeción del Ganado
Artículo 29º.- Cada ejemplar deberá presentarse provisto de cabezada y ramal para su manejo y sujeción.
dos en las instalaciones del certamen, hasta las 20 horas del día 26 de septiembre.

Entrada y Estancia del Ganado
Artículo 30º.- Los animales concursantes deberán ser presenta-
Aquellos concursantes que no presenten su ganado en el plazo fijado, no serán admitidos al certamen.
Artículo 31º.- Los animales expuestos en el recinto ferial no podrán ser retirados del mismo hasta la finalización del certamen, es decir, después de las 18 horas del día 29 de septiembre. Quienes contravinieran esta norma serán privados de los premios que hubieran podido alcanzar y podrán ser sancionados a no admitirlos en futuros certámenes.
Custodia del Ganado
Artículo 32º.- La custodia y manejo del ganado correrá a cargo de sus propietarios, que deberán adoptar las medidas más apropiadas para garantizar la seguridad de su ganado, ya que serán responsables de las incidencias o alteraciones que puedan provocar durante su permanencia en el recinto ferial.
Artículo 33º.- Los riesgos que puedan concurrir durante la carga, descarga y transporte del ganado, así como las incidencias que puedan producirse durante su permanencia en el recinto del Certamen, quedarán bajo la responsabilidad de los expositores.
Artículo 34º.- En ningún caso la Organización será responsable de los accidentes, enfermedades de cualquier tipo o sustracciones que puedan ocurrir a los expositores, a sus ejemplares o a terceras personas, así como a los animales durante el desarrollo del Concurso.
Seguro del Ganado
Artículo 35º.- Con la finalidad de cubrir parte de los riesgos indicados en los Artículos precedentes, la Organización suscribirá a su cargo un seguro "tipo" de ganado, con entidad de la máxima garantía, que compense los accidentes que pueda sufrir el ganado durante la operación de carga, transporte y descarga, así como de los que puedan producirse durante su permanencia en el recinto ferial.
Artículo 36º.- La organización facilitará la alimentación del ganado (alfalfa y pulpa) en cantidades suficientes. Igualmente se facilitará la paja y serrín necesarios para preparar la cama.
Artículo 37º.- Los expositores podrán disponer de cantidad extra de los productos, previo pago de su importe, en el almacén habilitado por la Organización dentro del recinto.
Artículo 38º.- El recambio de las camas correrá a cargo de los expositores; éste deberá ser realizado durante las horas en que permanezca cerrado al público el recinto ferial y siempre antes de las 08:00 horas.
Los participantes aceptan expresamente, y para facilitar las tareas de limpieza, el depositar la paja y el estiércol en el lugar que la comisión organizadora destine a este fin.
Artículo 39º.- El lavado de los animales deberá realizarse en los puntos oportunamente señalados por la Organización.
Carteles
Artículo 40º.- Se permitirán tres tipos de carteles:
a) Carteles publicitarios de la Asociación/Federación participante.
b) Carteles publicitarios de la ganadería.
Ambos carteles estarán homologados con las siguientes características:
-Han de ser sobre fondo blanco.
-Sus medidas serán entre 3 y 6 metros de largo y 0,80 de ancho.
c) Carteles de identificación del animal. Estos últimos carteles serán facilitados por la entidad organizadora y en ellos constarán los siguientes datos:
-Nombre del animal.
-Número Genealógico o CIB.
-Número de identificación en la pista.
-Fecha de nacimiento.
-Sección a la que pertenece.
-Nombre del padre.
-Nombre del padre de la madre.
-Índice Genético (ICO).
-Nombre de la ganadería.
Asistencia Sanitaria
Artículo 41º.- Durante la celebración del Certamen funcionará en el recinto del mismo una clínica veterinaria con servicio gratuito, a la que podrán acudir cuantos expositores lo precisen para la atención del ganado, siendo el importe de los medicamentos a utilizar por cuenta de los propietarios del ganado.
Presentación del Ganado en Pista y Exhibiciones
Artículo 42º.- La presentación del ganado en pista, cuantas veces sean necesarias para su calificación, así como su participación en las exhibiciones que determine la Organización, será obligatoria, debiendo ser conducido por los propietarios y/o personal a su cargo. Los animales que lleguen tarde a su presentación en pista ocuparán el último lugar dentro de la sección.
Artículo 43º.- De la presentación en pista. Los concursos son la base para presentar a la raza y útiles para fomentar el contacto entre ganaderos. Los animales serán presentados en la pista de la forma más natural posible, con un cuidado, tanto veterinario como estético, que no afecte al bienestar, a la salud, al estrés y a la morfología del animal.
1.Prácticas que se permiten en la preparación de las vacas Se aceptan las siguientes prácticas:
El recorte de pezuñas, poner pelo postizo en la cola, lavar y pelar el animal.
Equilibrado natural de las ubres con leche propia del animal, en la medida que sea necesario para su bienestar. Los pezones pueden estar sellados de forma externa.
El tratamiento de un animal por parte del veterinario oficial del Concurso, en la medida que sea necesario para su bienestar y no altere la morfología del animal.
2.Prácticas que no están permitidas en la preparación de las vacas
Para la preparación de la línea de pelo de la parte dorsolumbar de la vaca no se permite pelo ajeno o de otra región, u otros materiales (únicamente pelo nacido de su propio folículo piloso). El pelo ajeno solo está permitido como postizo en la cola.
Administrar sustancias (por vía oral, rectal o vaginal) que cambien el perfil natural del animal (p.e. llenar demasiado la vaca de forma no natural).
Inocular subcutáneamente con sustancias irritantes o cual-
Anexo

quier otro tipo de droga que altere el aspecto de las ubres.
Cualquier otra modificación no recopilada en los puntos anteriores, que afecte al estado natural del animal y que pueda interferir, a juicio de la Comisión de Admisión, en la salud, estrés, bienestar del animal y morfología del mismo.
3.Conforme a las normas
-El propietario de un animal es responsable del cumplimiento de la normativa del ConcursoÉl debe asegurarse de que sus técnicos, agentes u otras personas que actúan en su animal cumplen con las normas del Concurso.
-Obligatoriamente las tres primeros vacas de cada sección en producción serán sometidas a una prueba de escáner ecográfico de la ubre, inmediatamente después de terminar el juzgamiento de la sección.
-Se podrá llevar a cabo un examen de la ubre con ultrasonidos, de cualquier vaca antes o después del juzgamiento, si el Comité de Admisión lo considera oportuno.
-Ninguna vaca será sometida al escáner ecográfico antes del juzgamiento si no es autorizado por el Comité de Admisión.
-El Comité de Admisión tiene autoridad para recoger y examinar, en cualquier momento, cualquier fluido del cuerpo de los animales para analizarlo.
-El propietario debe aceptar estas normas y firmar un documento que le entregará la Organización al inicio del Concurso (ver Anexo).
4.Medidas frente al incumplimiento de las normas éticas
1º El propietario se compromete a cumplir la normativa del concurso, para lo que firma un documento (ver Anexo) de aceptación de las normas.
2º Con la solicitud de inscripción se deberá enviar el documento de aceptación de las normas incluidas en el presente Reglamento.
3º Si se comprueba una infracción o resulta positivo al escaneado un animal, se descalificará al animal del Concurso y se le retirarán sus premios y títulos conseguidos, ocupando sus puestos los animales inmediatamente siguientes .
4º Se prohíbe entrar en pista a todos los animales a los que se detecte cualquier infracción al cumplimiento del Reglamento.
5º El Comité de Admisión emitirá un informe a la Junta de Gobierno de CONAFE, quien se reserva el derecho de imponer medidas complementarias al propietario.
6º Las decisiones de la Junta de Gobierno de CONAFE son definitivas.
Faltas y Sanciones
Artículo 44º.- Además de las atribuciones conferidas en el Art. 4º al Comité de Admisión y en el Art. 5º al Comité de Juzgamiento, serán consideradas las siguientes faltas y sanciones, tomando como fecha de inicio de la sanción la fecha de notificación de la falta.
CERTIFICADO
DON ..........................................................., con D.N.I..............................., en mi calidad de ..................................... de la explotación ganadera ............................................................, por medio de la presente ACEPTO dar cumplimiento al Reglamento del Concurso, redactado por CONAFE, que conozco, tengo a mi disposición y he leído, por el que se rige el 34º CONCURSO NACIONAL CONAFE’13 a celebrar entre los días 26 al 29 de septiembre del año 2013, en la ciudad de Gijón, por lo que, y en base al contenido del mismo, por la firma del presente documento me COMPROMETO a,
1.-Actuar de acuerdo a lo establecido en el Reglamento del Concurso, y muy concretamente, a las normas y prácticas relacionadas con el bienestar de los animales.
2.-A mantener mis animales en perfectas condiciones de salud y bienestar durante el Concurso, reconociendo ser el único y exclusivo responsable de las acciones de mis empleados, mías propias, y de las de cualquier otra persona que me ayude con el equipamiento, cuidado y preparación de los animales durante la vigencia del Concurso.
3.-A evitar y denunciar ante la Organización cualquier incumplimiento de las normas del Concurso, que a su vez, pueda perjudicar a la ganadería de la raza frisona, a los propios ganaderos participantes en el Concurso, a otros expositores y a los trabajadores en el Concurso y a los visitantes.



4.-Eximir a los organizadores, y a su personal, de cualquier acción de sanción que se pueda tomar por los mismos al amparo del Reglamento del Concurso.
5.-Asumir, a mi costa y cargo, cualquier perjuicio, daño o pérdida, sufrida durante el tiempo de duración del Concurso, tanto si es debido, directa o indirectamente, a las acciones u omisiones de los organizadores del mismo, como si no. Una vez leído y de acuerdo con su texto y contenido, se firma en ........................, a .......... de ............................ de 2013. FirmaGanadería


1.Faltas
Leves
-Falta de diligencia y celo en la confección de los documentos para el Concurso.
-Falta de colaboración con los Servicios Veterinarios de Inspección Sanitaria o con el personal de la Organización.
Graves
-Realización de actividades que sean contrarias a los principios inspiradores de un Concurso Nacional en la forma que se prevé, o bien en contra de la actividad ganadera, del bienestar y salud de los animales o de los intereses del sector.
-El incumplimiento probado por el Comité de Admisión de las prácticas no permitidas que se recogen en el Art. 43, apartado 2.
-Dar positivo al escaneado de un animal, según Art. 43 apartado 4, punto 3º.
-Falta de consideración manifiesta hacia el Juez del Concurso y/o hacia otros participantes.
-Comportamiento incorrecto en pista.
-Reiteración de faltas leves.
Muy Graves
-Incumplimiento del Art. 43, apartado 4, punto 2º.
-Cualquier falsificación de la documentación genealógica y su correspondencia con los animales presentados.
-Reiteración de resultado positivo en el escaneado de un animal o de una misma ganadería.
-Reiteración de faltas graves.
2.Sanciones
Además de lo que ya se contempla en el propio Reglamento del Concurso, de acuerdo con la calificación de la falta, se podrían aplicar las siguientes sanciones:
-Apercibimiento verbal en el momento de la infracción y por escrito de la Junta de Gobierno de CONAFE a la ganadería infractora con copia a la Asociación/Federación de su C.A., en todos los casos en los que se aprecie falta leve.
-Además de las acciones tomadas por las faltas leves, se dará público conocimiento de la infracción, a través de la revista Frisona Española, si ésta pusiera en peligro la defensa de los intereses del sector y/o de la raza y en todos los casos de falta grave o muy grave.
-Además de las acciones tomadas por las faltas graves, en las faltas consideradas como muy graves, se dará parte al Inspector de la Raza y al Gobierno de la C.A., del interesado, si la falta además fuera en contra de la actividad ganadera, de la higiene, salud y bienestar de los animales.
-Aquella ganadería que haya incurrido en una falta grave no podrá participar durante un año en ningún otro Concurso Nacional o regional de la raza frisona. En el caso de las faltas muy graves, la sanción será de dos años sin posibilidad de participar en concursos regionales o nacionales de la raza frisona.
-Las decisiones de estas sanciones podrán ser recurridas por
los interesados, antes de un mes, a la Asamblea General de la Confederación, que decidirá y agotará la vía administrativa, debiéndose realizar su estudio en la primera de sus reuniones.
Artículo 45º.- El ganado que no sea presentado en pista en el momento indicado para su calificación, será eliminado del Concurso. Los animales que lleguen con retraso ocuparán el último lugar dentro de la sección.
Artículo 46º.- Cada presentador llevará un distintivo con el número identificativo del animal en pista, facilitado por la Organización, que coincidirá con el correspondiente número de orden del Catálogo del Certamen.
Artículo 47º.- Los presentadores irán uniformados con pantalón blanco y camisa blanca.
Artículo 48º.- Se establecen tres premios a presentadores que serán otorgados por el Juez, después de observar su actuación a lo largo de todo el Concurso.
Salida del Ganado
Artículo 49º.- Una vez finalizado el certamen, para la salida del ganado del recinto ferial, los propietarios deberán proveerse de la oportuna Guía de Origen y Sanidad, e interprovincial en los casos necesarios, debiendo retirar igualmente la documentación sanitaria que les fue recogida a la entrada por el Servicio de Inspección Sanitaria.
Artículo 50º.- No se permitirá la carga del ganado en vehículos que no estén previamente desinfectados y que lo demuestren mediante el talón correspondiente.
Premios a Concursantes
Artículo 51º.- Todo ganadero expositor recibirá los diplomas, trofeos, banderines, estandartes, etc., que se mencionan en las diferentes secciones del programa.
-La primera clasificada de cada sección, las campeonas y las subcampeonas tendrán derecho y obligación a una fotografía gratuita oficial para la difusión de la raza, realizada en el set que se instale al efecto en el recinto del Concurso. El incumplimiento de este punto será sancionado con la pérdida de la publicidad gratuita y de los premios en metálico.
-Se concederá una página gratuita de publicidad en la revista Frisona Española a la Ternera Campeona, Novilla Campeona, Gran Campeona Nacional (Novillas), Vaca Joven Campeona, Vaca Intermedia Campeona, Vaca Adulta Campeona, Gran Campeona Nacional (Vacas), Gran Campeona Nacional Reserva (Vacas), Mejor Autonomía, Mejor Rebaño Nacional y Mejor Criador Nacional.

Jueves, día 26 de septiembre:
Entrada de ganado. La entrada de ganado deberá realizarse hasta las 20 horas del día 26 de septiembre.
Viernes, día 27 de septiembre:
Descanso del ganado.
Sábado, día 28 de septiembre:
Mañana: Concurso de Terneras y Novillas
•Desde las 10:00 horas.
Juzgamiento de las secciones: 1, 2, 3, 4, 5, 6, 7, 8 y 9.
Tarde:
•16:30 horas. XIII Campeonato Nacional de Manejadores
Domingo, día 29 de septiembre:
Mañana: Concurso de Vacas lactación y grupos
•Desde las 10:00 horas.
Juzgamiento de las secciones: 10, 11, 12, 13, 14, 15, 16, 17, 18, 19, 20, 21, 22, 23 y 24.
•Entrega de los diplomas a las Mejores Vacas de la Evaluación Genética de Junio 2013.

NOTA: Todos los actos comenzarán rigurosamente a las horas fijadas.
Notas Previas de Interés
Fecha de referencia: A efectos de determinar la edad, se considera como tal el día 31 de agosto de 2013.
1. La identificación, edad, parentesco y propiedad de los animales se comprobarán por el Comité de Admisión mediante la correspondiente Carta Genealógica Oficial o Certificado de Registro, que deberá ser entregado siempre que el Comité lo solicite. El animal del que no se presente la documentación anterior no podrá competir.

2. Definiciones:
a) Novilla no parida: Toda aquella que no haya parido nunca.
b) Hembra lactación: Es aquella que se encuentra en ordeño.
3. El Juez en cada sección establecerá un orden de mejor a peor.
4. Se publicará a continuación del Concurso, antes de finalizar los actos, una relación de todos los animales con el lugar establecido por el Juez de pista en cada sección.
5. A efectos de consecución de premios (banderines, estandartes, trofeos, diplomas, etc.) se considerarán los cinco primeros puestos en pista.
6. Los estandartes y/o banderines y trofeos se entregarán en la misma pista de competición, en el momento de realizar su dictamen el Juez al final de cada sección.
7. Los campeonatos no serán premios únicos, sino que se subdividirán en:
-Campeona.
-Subcampeona.
8. El Gran Campeonato de Novillas será premio único y el Gran Campeonato de Vacas se subdividirá en:
-Gran Campeona Nacional (Vacas).

-Gran Campeona Nacional Reserva (Vacas).
9. El título de Campeona queda reservado para animales individuales, no para grupos de animales.
10. Los grupos de animales obtendrán el título de Mejor y Segundo.
11. Se concederán Estandartes de color azul (letras y cenefas doradas) a:
-Campeona y Subcampeona.
-Gran Campeona Nacional y Gran Campeona Nacional Reserva (Vacas).
-Mejor Rebaño y Segundo Rebaño.
-Mejor Criador y Segundo Criador.
-Mejor Autonomía y Segunda Autonomía.
12. Se concederán Banderines a los cinco primeros clasificados en cada sección individual, con el distintivo de color único (azul), indicando su clasificación.
13. Se concederá Banderín a la mejor ubre de cada sección.
14. Las actuaciones del Juez en pista se realizarán de forma ininterrumpida, desde el comienzo de cada sección hasta finalizar el programa previsto para el día.
15. Cada sección será juzgada siguiendo el orden que figura en el calendario
Fecha de Referencia: A efectos de determinar la edad, se considera como tal el día 31 de agosto de 2013
Sección 1ª. Terneras de 8 a 10 meses
Son las hembras de 8 a 10 meses. (Nacidas entre el 1 de octubre de 2012 y el 31 de diciembre de 2012).
Sección 2ª. Terneras de 11 a 13 meses
Son las hembras de 11 a 13 meses. (Nacidas entre el 1 de julio de 2012 y el 30 de septiembre de 2012).
Sección 3ª. Terneras de 14 a 16 meses
Son las hembras de 14 a 16 meses. (Nacidas entre el 1 de abril de 2012 y el 30 de junio de 2012).
Sección 4ª. Novillas de 17 a 19 meses
Son las hembras de 17 a 19 meses, no paridas. (Nacidas entre el 1 de enero de 2012 y el 31 de marzo de 2012).
Sección 5ª. Novillas de 20 a 22 meses
Son las hembras de 20 a 22 meses, no paridas. (Nacidas entre el 1 de octubre de 2011 y el 31 de diciembre de 2011).
Sección 6ª. Novillas de 23 a 26 meses
Son las hembras de 23 a 26 meses, no paridas. (Nacidas entre el 1 de junio de 2011 y el 30 de septiembre de 2011).
Nota: la Organización podrá limitar la participación a 3 animales por ganadería, en las secciones 1ª, 2ª, 3ª, 4ª, 5ª y 6ª.
Sección 7ª. Ternera Campeona
Competirán las dos primeras clasificadas en las secciones 1ª, 2ª y 3ª. Se obtendrán los títulos de Ternera Campeona y Ternera Subcampeona.
Sección 8ª. Novilla Campeona
Competirán las dos primeras clasificadas de las secciones 4ª, 5ª y 6ª. Se obtendrán los títulos de Novilla Campeona y Novilla Subcampeona.
Sección 9ª. Gran Campeona Nacional (Novillas)
Competirán la Ternera Campeona (Sec. 7ª) y la Novilla Campeona (Sec. 8ª). Se obtendrá el premio único de Gran Campeona Nacional (Novillas).
Nota: El juzgamiento de las secciones 7ª, 8ª y 9ª (Campeonato de Terneras, Campeonato de Novillas y Gran Campeonato de Novillas), se realizará simultáneamente en pista.
Sección 10ª. Vaca joven lactación hasta 30 meses
Hembras hasta 30 meses en ordeño. (Nacidas después del 31 de enero de 2011). Se entregará un banderín a la Mejor Ubre.
Sección 11ª. Vaca joven lactación de 31 a 35 meses
Hembras de 31 a 35 meses en ordeño. (Nacidas entre el 1 de septiembre de 2010 y el 31 de enero de 2011). Se entregará un banderín a la Mejor Ubre.

Sección 12ª. Vaca intermedia lactación de 36 a 41 meses
Hembras de 36 a 41 meses en ordeño. (Nacidas entre el 1 de marzo de 2010 y el 31 de agosto de 2010). Se entregará un banderín a la Mejor Ubre.
Sección 13ª. Vaca intermedia lactación de 42 a 47 meses
Hembras de 42 a 47 meses en ordeño. (Nacidas entre el 1 de septiembre de 2009 y el 28 de febrero de 2010). Se entregará un banderín a la Mejor Ubre.
Sección 14ª. Vaca intermedia lactación de 4 años
Hembras de 48 a 59 meses en ordeño. (Nacidas entre el 1 de septiembre de 2008 y el 31 de agosto de 2009). Se entregará un banderín a la Mejor Ubre.
Sección 15ª. Vaca adulta lactación de 5 años
Hembras de 60 a 71 meses en ordeño. (Nacidas entre el 1 de septiembre de 2007 y el 31 de agosto de 2008). Se entregará un banderín a la Mejor Ubre.
Sección 16ª. Vaca adulta lactación de 6 años o más
Hembras de 72 meses o más en ordeño. (Nacidas antes del 1 de septiembre de 2007). Se entregará un banderín a la Mejor Ubre.
Sección 17ª. Vaca en Producción de más de 50.000 kg Hembras en lactación, con al menos tres partos, que hayan producido en lactaciones naturales finalizadas un total de 50.000 kg o más según los datos de producción registrados en la Base de Datos de CONAFE e incluidos en la valoración genética de junio de 2013. Se entregará un banderín a la Mejor Ubre.
Sección 18ª. Vaca Joven Campeona
Competirán las dos primeras clasificadas en las secciones Vaca Joven Lactación hasta 30 meses (Sec. 10ª) y Vaca Joven Lactación de 31 a 35 meses (Sec. 11ª). Se obtendrán los títulos de Vaca Joven Campeona y Vaca Joven Subcampeona.
Sección 19ª. Vaca Intermedia Campeona
Competirán las dos primeras clasificadas en las secciones
Vaca Intermedia Lactación de 36 a 41 meses (Sec. 12ª), Vaca Intermedia Lactación de 42 a 47 meses (Sec. 13ª) y Vaca Intermedia Lactación de 4 años (Sec. 14ª). Se obtendrán los títulos de Vaca Intermedia Campeona y Vaca Intermedia Subcampeona.
Sección 20ª. Vaca Adulta Campeona
Competirán las dos primeras clasificadas en las secciones de Vaca Adulta Lactación de 5 años (Sec. 15ª), Vaca Adulta Lactación de 6 años o más (Sec. 16ª) y Vaca Producción de más
de 50.000 kg (Sec. 17ª). Se obtendrán los títulos de Vaca
Adulta Campeona y Vaca Adulta Subcampeona. Sección 21ª. Gran Campeona Nacional (Vacas)
Se obtendrán dos títulos:
Gran Campeona Nacional:
Competirán la Vaca Joven Campeona (Sec. 18ª), Vaca Intermedia Campeona (Sec. 19ª) y Vaca Adulta Campeona (Sec. 20ª). Se obtendrá el título de Gran Campeona Nacional (Vacas).
Gran Campeona Nacional Reserva: Competirán las vacas campeonas de las secciones que no hayan conseguido el título de Gran Campeona Nacional y la Subcampeona de la sección de la que quede Gran Campeona. Se obtendrá el título de Gran Campeona Nacional Reserva.
Nota: El juzgamiento de las secciones 17ª, 18ª, 19ª y 20ª (Campeonatos de Vaca Joven, Vaca Intermedia, Vaca Adulta y Gran Campeona y Gran Campeona Reserva), se realizarán simultáneamente en pista.
Sección 22ª. Mejor Autonomía
Se entregará este premio a la Autonomía que obtenga el mayor número de puntos ganados en las secciones individuales por hembras en lactación cuyos criadores y propietarios sean ganaderos de la misma, en base al siguiente baremo:
1º2º3º4º5º6º7º8º9º10º
Vacas lactación2018161412108642

Se obtendrán los títulos de Mejor Autonomía y Segunda Autonomía. Solo puntuarán los mejores cinco animales de cada Autonomía.
Sección 23ª. Mejor Rebaño Nacional
Se entregará este premio al ganadero que obtenga el mayor número de puntos ganados en las secciones individuales por hembras de su propiedad, en base al siguiente baremo:
1º2º3º4º5º6º7º8º9º10º
Vacas lactación2018161412108642
Terneras y Novillas109 87654321
Se obtendrán los títulos de Mejor Rebaño Nacional y Segundo Rebaño Nacional. Sólo puntuarán los mejores cinco animales de cada ganadería propietaria.
Sección 24ª. Mejor Criador Nacional
Se entregará este premio al ganadero que, inscrito como participante en el Concurso, obtenga el mayor número de puntos ganados en las secciones individuales por hembras con su prefijo ganadero, en base al siguiente baremo:
1º2º3º4º5º6º7º8º9º10º
Vacas lactación2018161412108642
Terneras y Novillas109 87654321
Se obtendrán los títulos de Mejor Criador Nacional y Segundo Criador Nacional. Sólo puntuarán los mejores cinco animales de cada ganadería criadora.

Las cédulas de inscripción se pueden descargar desde www.conafe.com o bien solicitarlas en CONAFE, tlf. 91 895 24 12 / 62 / 68
Objetivo
CONAFE organizará durante su Concurso Nacional en Gijón, el XIII Campeonato Nacional "CONAFE 2013" de Manejadores.
Se pretende con este Campeonato:
1º Fomentar la profesionalidad y autoestima de ganaderos y profesionales.
2º Estimular a los manejadores en la formación de las técnicas de presentación de los animales en concursos, subastas, exposiciones de su ganado, etc.
Bases del Campeonato
1. Podrán participar en el Campeonato todas las personas que lo deseen sin ninguna distinción específica.
2. Se establecerán tres categorías:
•Infantil: Hasta 11 años
•Júnior: De 12 a 17 años
•Sénior: De 18 a 30 años
3. Los que deseen participar deberán inscribirse antes de las 13:00 horas del día 28 de septiembre, provistos con su D.N.I.
Condiciones de Participación
1. Todos los manejadores deberán presentarse uniformados con pantalón y camisa blancos.
2. Presentarse con un animal suficientemente domado, de tal forma que no perturbe las acciones del resto de participantes.
3. Aceptar estas norma y las decisiones del Juez.

Condiciones de Juzgamiento
1º El Juzgamiento se basará fundamentalmente en:
1.Presentación del manejador
2.Preparación del animal: doma, limpieza, etc.
3.Habilidades del manejador en la conducción del animal
4.Atención al Juez y a sus indicaciones
2º No se valorará la morfología del animal ni su extrema preparación.
Títulos y Premios
Se concederán los títulos de:
•Campeón Nacional Infantil de Manejadores CONAFE´13
•Subcampeón Nacional Infantil de Manejadores CONAFE´13
•Campeón Nacional Júnior de Manejadores CONAFE´13
•Subcampeón Nacional Júnior de Manejadores CONAFE´13
•Campeón Nacional Sénior de Manejadores CONAFE´13
•Subcampeón Nacional Sénior de Manejadores CONAFE´13
Programa
Sábado, día 28 de septiembre.
•A las 16:15 horas se presentarán todos los participantes inscritos en la pista del Concurso con la indumentaria exigida.
•A las 16:30 horas el Juez del Concurso y Gabriel Blanco (CONAFE) explicarán:
1º)las normas para una buena presentación en pista de los animales y 2º)las reglas para ser un buen manejador.
•A continuación se tendrá lugar el desarrollo de las secciones.
7540 Real Decreto 506/2013, de 28 de junio, sobre productos fertilizantes. Miércoles 10 de julio de 2013, BOE núm. 164


6638 Orden AAA/1129/2013, de 7 de junio, por la que se definen las explotaciones y animales asegurables, las condiciones técnicas mínimas de explotación y manejo, el ámbito de aplicación, los periodos de garantía, el valor del suplemento de alimentación y las fechas de suscripción en relación con el seguro de compensación por pérdida de pastos, comprendidos en el Plan Anual 2013 de Seguros Agrarios Combinados. (, Martes 18 de junio de 2013.BOE núm.145
6903 Orden AAA/1169/2013, de 21 de junio, por la que se modifican el Reglamento Técnico de Control y Certificación de Semillas de Plantas Forrajeras, aprobado mediante Orden ARM/3370/2010, de 27 de diciembre, y el Reglamento Técnico de Control y Certificación de Semillas de Sorgo, aprobado mediante Orden ARM/3374/2010, de 27 de diciembre Miércoles 26 de junio de 2013 BOE núm.152
7089 Resolución de 10 de junio de 2013, de la Entidad Estatal de Seguros Agrarios, por la que se establece la convocatoria de subvenciones de la Administración General del Estado a la suscripción de los seguros incluidos en el Plan de Seguros Agrarios Combinados para el ejercicio 2013.
Sábado 29 de junio de 2013 BOE núm.155
7411 Orden AAA/1273/2013, de 27 de junio, por la que se modifica la Orden AAA/907/2013, de 16 de mayo, por la que se definen las explotaciones de ganado asegurables, las condiciones técnicas mínimas de explotación, el ámbito de aplicación, el periodo de garantía, las fechas de suscripción y el valor unitario de los animales en relación con el seguro renovable para la cobertura de los gastos derivados de la retirada y destrucción de animales bovinos muertos en la explotación, comprendido en el Plan anual 2013 de Seguros Agrarios Combinados.
Sábado 6 de julio de 2013,BOE núm.161
7412 Orden AAA/1274/2013, de 27 de junio, por la que se modifica la Orden AAA/924/2013, de 16 de mayo, por la que se definen las explotaciones de ganado asegurables, las condiciones técnicas mínimas de explotación, el ámbito de aplicación, el periodo de garantía, las fechas de suscripción y el valor unitario de los animales en relación con el seguro
para la cobertura de los gastos derivados de la retirada y destrucción de animales no bovinos muertos en la explotación, comprendido en el Plan anual 2013 de Seguros Agrarios Combinados.
Sábado 6 de julio de 2013,BOE núm.161
7413 Orden AAA/1275/2013, de 27 de junio, por la que se modifica la Orden AAA/929/2013, de 16 de mayo, por la que se definen las explotaciones de ganado asegurables, las condiciones técnicas mínimas de explotación, el ámbito de aplicación, el periodo de garantía, las fechas de suscripción y el valor unitario de los animales en relación con el seguro renovable para la cobertura de los gastos derivados de la retirada y destrucción de animales no bovinos muertos en la explotación, comprendido en el Plan anual 2013 de Seguros Agrarios Combinados.
Sábado 6 de julio de 2013,BOE núm.161
8048 Real Decreto 505/2013, de 28 de junio, por el que se regula el uso del logotipo «raza autóctona» en los productos de origen animal. Miércoles 24 de julio de 2013,BOE núm 176
8178 Resolución de 16 de julio de 2013, de la Entidad Estatal de Seguros Agrarios, por la que se convoca la concesión de subvenciones a organizaciones profesionales y organizaciones de las cooperativas agrarias de ámbito estatal para el fomento de los seguros agrarios en el ejercicio 2013.
Viernes 26 de julio de 2013,BOE núm 178

8482 Orden AAA/1479/2013, de 17 de julio, por la que se publica la convocatoria de los Premios Alimentos de España en su XXVI edición, año 2013.
Jueves 1 de agosto de 2013,BOE núm 183






Nº1 Nacional e Internacional con hijas en España
Las mejores ubres con 99% de Percentil

+1.731 kg de Leche
+55 kg de Proteína
+2,24 en Ubres
+1,29 en Patas
ICO
3.638 Nº1
+107 en Longevidad

CONAFE JUNIO 2013 ¡ABEREKIN presenta 5 de los 10 mejores toros españoles en ICO: BEHOBIA, BIARRIZ, SILEX, LOTTERY y BONFIRE!



